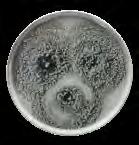

PORCELAIN FLATWARE COOKWARE MELAMINE TOOLS GLASSWARE 2024
QUALITÀ E DESIGN DA OLTRE 75 ANNI QUALITY AND DESIGN FOR OVER 75 YEARS

TOGNANA, DOVE L’ARTE È DI CASA TOGNANA, WHERE ART IS AT HOME
Da oltre 75 anni, Tognana garantisce radizione, qualità e design italiano, sempre al passo con l’innovazionee i trend più attuali.
Abbiamo da sempre un obiettivo chiaro: essere al vostro fianco nelle occasioni più importanti, ma anche nei piccoli gesti quotidiani, per rendere speciale ogni istante della vostra vita.
Mettiamo ricerca e passione in ogni nuova collezione: non riempiamo spazi, ma valorizziamo ambienti, decorando di autentica armonia la vostra ritualità quotidiana.
Una promessa mantenuta grazie al saper fare e alla passione di Tognana, azienda italiana che dal 1946 porta emozione e stile italiano in cucina e in casa.
For over 75 years, Tognana has been the touchstone in tradition, quality and Italian design, always in step with innovation and the latest trends.
We have always had a clear goal – to be by your side for the most important occasions, and also in your small, daily acts, to make each and every moment in your life special.
We put a great deal of research and enthusiasm into each new collection –we do not bulk out spaces, but enhance environments, and decorate your daily rituals with a touch of authentic harmony.
A promise that we manteins thanks to the know-how and enthusiasm at Tognana, an Italian company that has been delivering excitement and Italian style to kitchens and homes since 1946.
Tutto ha inizio nel 1775, a Casier in provincia di Treviso, quando la famiglia Tognana è attiva nel settore dei laterizi e vi affianca la produzione delle ceramiche. La vicinanza di un punto di riferimento culturale come Venezia, contribuisce in modo decisivo allo sviluppo di un marchio che pone sempre in primo piano design ed estetica.


Ancora oggi Tognana può vantare le proprie origini di laboratorio artistico, trasmettendo passione ed emozione all’interno di una realtà industriale. Il 1946 è l’anno in cui l’azienda passa dalle maioliche alla porcellana, diventando in breve tempo un prestigioso tassello della migliore manifattura italiana. La forza e la crescita del marchio hanno permesso negli anni di estendere il know how in nuove categorie prodotto, in particolare nel segmento cottura, affermando Tognana come realtà dedita all’innovazione tecnologica.
It all began in Casier, in the province of Treviso, in 1775, when the Tognana family was in the brick sector and worked alongside ceramics manufacturing.
The proximity of Venice as a cultural andmark contributed definitely to the development of a brand that puts design and aesthetics at the forefront.
Even today, Tognana is still proud of its origins as an art workshop, with its infectious brand of enthusiasm and excitement that finds itself in an industrial organisation. The company transitioned from majolica to porcelain in 1946, becoming an illustrious pillar in the best of Italian manufacturing in just a brief period of time. The brand’s strength and growth over the years have allowed it to extend its know-how into new product categories, particularly in the cooking sector, establishing Tognana as a company with a firm focus on technological innovation.
2 3
QUALITÀ CERTIFICATA CERTIFIED QUALITY
Le porcellane Tognana sono sottoposte ad attenti e rigorosi controlli di laboratorio, anche in collaborazione con il Centro Ceramico di Bologna e la Stazione Sperimentale del Vetro di Venezia. L’elevato standard qualitativo dei nostri prodotti è garantito da test di lavaggio con lavastoviglie industriali, di abrasione e di resistenza meccanica. Le nostre vernici, utilizzate anche per i decori, sono verificate dalla Food & Drug Administation americana e soddisfano perfettamente le prescrizioni richieste dalle severe U.S. “Proposition 65” relativamente alla presenza di metalli pesanti. Le porcellane Tognana inoltre possiedono un’elevata capacità di assorbire il calore e di rilasciarlo gradualmente, garantendo che cibi e bevande rimangano caldi nel tempo.
Tutti i prodotti, destinati ai canali alberghiero e ristorazione, hanno il bordo verniciato e il piede levigato al fine di evitare spiacevoli rigature sulle vostre tavole, sui segnaposto o quando i pezzi vengono impilati uno sopra l’altro.
Tognana Porcelain is subjected to careful and rigorous laboratory controls, also in collaboration with the Ceramic Centre of Bologna and the Experimental Station of the Glass of Venezia. The elevated quality standard of our products is guaranteed by tests of washing with industrial dishwashers, of abrasion and of mechanical resistance. Our glazes, including those used for decorations, are verified by the american Food and Drug Administation and perfectly meet the requirements demanded by the strict U.S. Proposition 65” in relation to the presence of heavy metals. Tognana Porcelain also possesses a high capacity of absorbing the heat and of releasing it slowly, ensuring that food and hot-drinks remain hot over time.
All products for hotels and restaurants, have the edge glazed and the foot smoothed in order to avoid any unpleasant scratches on your tables, placeholders or when the pieces are stacked on top of one another.

Tognana si impegna quotidianamente per quanto riguarda le certificazioni del sistema qualità, della salute, della sicurezza sul lavoro e della gestione ambientale e ha ricevuto le certificazioni sotto riportate.
Tognana works daily for the certifications of the quality system, the health and safety at work and the environmental management and received the below certifications.
Certificazione del sistema qualità
UNI EN ISO 9001:2015.
EN ISO 9001:2015 Quality management systems certification
Certificazione della responsabilità sociale SA 8000:2014
SA 8000:2014 Corporate social responsibility certification

Certificazione del sistema di gestione per la salute e sicurezza sul lavoro UNI ISO 45001:2018
UNI ISO 45001:2018 Health and safety at work management system certification
Certificazione del sistema di gestione ambientale ISO 14001:2015
ISO 14001:2015 Environmental management system certification
Le Porcellane Tognana sono realizzate con materiali autofondenti e poco dilatanti, formate con stampi isostatici che garantiscono la perfetta e uniforme densità: non lasciano tensioni residue che possano innescare rotture durante l’uso.
Tognana Porcelain is made of automelting and not much dilated materials, shaped by isostatic molds that guarantee perfect and uniform density: do not leave residual stresses which may trigger damage during use.
BORDI VERNICIATI E PIEDI LAVIGATI GLAZED RIMS AND POLISHED FEET
PORCELLANA FELDSPATICA RESISTENTE RESISTENCE OF FELDSPAR Porcelain

La resistenza delle nostre porcellane è garantita dall’impiego di materiali selezionati, da un rigido sistema di controllo della qualità e dall’esperienza di Tognana.
The resistance of our Porcelain is guaranteed by the use of selected materials, by a rigid system of quality controls and Tognana’s experience.
RESISTENZA ALLA SCALFITURA RESISTANCE TO THE SCRATCH
L’elevata temperatura di cottura a cui è sottoposta la nostra porcellana garantisce una notevole resistenza alle abrasioni e alle scalfitture provocate dai normali utensili da tavola. Ciò è importante non soltanto dal punto di vista estetico ma soprattutto igienico.
The elevated cooking temperature to which our Porcelain is exposed guarantees a high resistance to abrasions and scratches caused by normal table utensils. This is important not only from an aesthetic point of view, but - most important - hygienic.
PERFETTA FUNZIONALITÀ PERFECT FUNCTIONALITY
QUALITÀ TESTATA IN LABORATORIO LABORATORY TESTED QUALITY

RESISTENZA ALLA ROTTURA RESISTANCE TO BREAKAGE
CAPACITÀ DI MANTENERE IL CALORE HEAT RETENTION

DECORI RESISTENTI IN LAVASTOVIGLIE RESISTANT DECORATIONS IN DISHWASHER
Tutti i decori dei prodotti destinati al settore alberghiero e della ristorazione sono resistenti al lavaggio in lavastoviglie: l’elevata temperatura di cottura consente la fusione della vernice in modo che il decoro penetri in essa e vi resti inglobato e quindi protetto, per sempre.
All decorations of products for the hotel and restaurant sector are dishwasher-safe: the elevated cooking temperature allows the fusion of glaze so that the decoration penetrates and remains incorporated and then protected, forever.
4 5
RESISTENZA AGLI SBALZI TERMICI RESISTANCE TO THERMAL SHOCK
RESISTENZZA DEI BORDI RESISTANCE OF THE EDGE
ATTITUDE COLLECTION: GARANZIA 5 ANNI CONTRO LE SBECCATURE
5 YEARS EDGE CHIP WARRANTY
5 Y E ARS
I piatti Attitude* sono progettati per essere utilizzati nell’hotellerie per anni senza pensieri. Il particolare design e la porcellana super resistente rendono i prodotti estremamente durevoli, in particolare sui bordi. A fronte di tale eccellente qualità, Tognana garantisce per 5 anni i piatti piani e fondi contro la sbeccatura dei bordi.
Inoltre, grazie alla speciale verniciatura, è assicurata anche la resistenza ai graffi e all’usura nell’uso quotidiano e nelle lavastoviglie industriali.
*Collezione Attitude alle pagina 13-19, 125-127 di questo catalogo.
Estrema durabilità
Long lasting quality
Resistenza alle sbeccature
Edge chipping resistance
Garanzia 5 anni contro le sbeccature
5 Years edge chip warranty
Resistenza al graffio
Scratch resistance
The Attitude plates* are designed for be used with confidence for years in the hospitality sector. The super strong porcelain and the specific design of the plates guarantee long lasting products, especially on the edge. Furthermore, thanks to the hard glaze coating’s surface, the resistance to scratches and wear in everyday use and in industrial dishwashers are also ensured.

*See Attitude Collection on pages 13-19, 125-127 of this catalogue.
Dettagli garanzia
La garanzia** 5 anni di Tognana Professional riguarda la “sbeccatura” dei bordi non la rottura dei piatti piani, dessert, pane, fondi, fondi gourmet, rettangolari della esclusiva linea Attitude (indicati in questa brochure), per la durata di 5 anni dal momento dell’acquisto.
Tognana si impegna a sostituire il piatto, previa analisi e verifica dello stesso, che riceverà tramite il rivenditore ufficiale di riferimento dal quale è stato effettuato l’acquisto. Per attivare la richiesta è necessario rivolgersi al rivenditore che invierà un’e-mail a quality@tognana.com (con foto del prodotto, documento comprovante l’acquisto e la data dello stesso) e che, successivamente all’approvazione di Tognana, invierà i prodotti per la sostituzione.
Tutte le informazioni sul nostro sito web tognanaprofessional.com
**La garanzia contro le sbeccature si applica solo alle aziende che lavorano nel settore dell’ospitalità e della ristorazione - La garanzia 5 anni non si estende all’uso domestico o ai prodotti venduti nel settore della vendita al dettaglio.
Warranty information
The Tognana Professional 5 years warranty** is against the edge chipping only not breakages of the dinner, dessert, bread, soup, gourmet deep and rectangular plates of the Attitude shape detailed within this folder. The edge warranty is valid for a period of 5 years from the date of the original invoiced order.
Tognana undertakes to substitute the plate, after analyzing and verifying it, which it will be sent by the official dealer from which the purchase was made. To activate the request it is necessary to refer to the official dealer who will send an e-mail to quality@tognana.com (with the photo of the product, the relative document proving the purchase and the date of it). After approval by Tognana, the products will be sent to the company for the replacement.
All information on our web site tognanaprofessional.com
**Edge Chip Warranty only applies to businesses working in hospitality & food service sector - Edge chip warranty does not extend to domestic use or products sold in retail sector.
6 7
WARR A NTY
factory selinunte 12 factory positano 12 factory alicudi 12 factory panarea 12 factory oriental 16 factory origini 16 factory iride 16 factory atollo 16 terra 22 giotto 24 redstrong tuff 28 attitude emerald 30 attitude browny 30 attitude iceland 30 bloom blue & brown 38 reef oyster 42 reef vertigo 44 reef marine 46 elipse 48 jap black 50 jap blue 50 jap new brown 50 terracotta 64 vulcania black 70 vulcania salento 76 vulcania veggie 78 moonlight & rust 86 organica material bronze & green 92 trend split 96 b-rush 98 seaside maiolica 110 TRENDY seaside 114 thesis 116 ambiente 124 CONTEMPORARY WHITE CONTEMPORARY CREAM attitude white 130 jasmin 134 plain 138 infinity 140 perla new bone 148 CLASSIC palace 154 vecchio vienna 158 opera 162 ouverture 166 TIMELESS cinzia 172 az bianco & filo blu 174 acapulco 178 trilogy 182 samba 183 CATERER basic 186 capri 187 h-shape 190 SERVING trento 194 albergo 195 party 196 miniparty 200 forno & dintorni 206 mignon black 208 pl-cook 210 olly 212 COFFEE & MORE albergo 216 scala 218 vesuvio 220 sun 222 iris 225 elegant 226 sphere 228 MELAMINA glossy 232 barrel 236 marina & clay 238 narciso & cefalù 242 colourful 246 show plate 250 gastronorm 260 finger food 264 dinamika premium 270 dinamika 271 FLATWARE tex mex 274 alhambra 280 charme 282 portovenere 284 rapallo 286 viareggio 288 sirolo 290 alassio 292 GLASSWARE vitÆ 296 stars & stripes 298 bubbles 300 marriage 302 bamboo 306 solange 308 gloria 312 kolors 314 madame 317 COOKWARE pro diamond 320 big family 324 vanitosa 326 fusion taste 330 starter kit 18 pz 334 serrano 336 starbamboo 338 tools 342 A INDICE INDEX B C D E F G H I J K M N P R S T acapulco 178 alassio 292 albergo 195 albergo 216 alhambra 280 ambiente 124 attitude browny 30 attitude emerald 30 attitude iceland 30 attitude white 130 az bianco & filo blu 174 V O b-rush 98 bamboo 306 barrel 236 basic 186 big family 324 bloom blue & brown 38 bubbles 300 capri 187 charme 282 cinzia 172 colourful 246 dinamika 271 dinamika premium 270 elegant 226 elipse 48 factory alicudi 12 factory atollo 16 factory iride 16 factory oriental 16 factory origini 16 factory panarea 12 factory positano 12 factory selinunte 12 finger food 264 forno & dintorni 206 fusion taste 330 gastronorm 260 giotto 24 gloria 312 glossy 232 h-shape 190 infinity 140 iris 225 jap black 50 jap blue 50 jap new brown 50 jasmin 134 kolors 314 madame 317 marina & clay 238 marriage 302 mignon black 208 miniparty 200 moonlight & rust 86 narciso & cefalù 242 olly 212 opera 162 organica material bronze & green 92 ouverture 166 palace 154 party 196 perla new bone 148 pl-cook 210 plain 138 portovenere 284 pro diamond 320 rapallo 286 redstrong tuff 28 reef marine 46 reef oyster 42 reef vertigo 44 samba 183 scala 218 seaside 114 seaside maiolica 110 serrano 336 show plate 250 sirolo 290 solange 308 sphere 228 starbamboo 338 stars & stripes 298 starter kit 18 pz 334 sun 222 terra 22 terracotta 64 tex mex 274 thesis 116 tools 342 trend split 96 trento 194 trilogy 182 vanitosa 326 vecchio vienna 158 vesuvio 220 viareggio 288 vitÆ 296 vulcania black 70 vulcania salento 76 vulcania veggie 78
trendy
linee ideali per ogni ambientazione, personalizzano il tuo format di ristorante sempre in tendenza con le ultime novità shapes always trendy and perfect for every atmosphere, customize your restaurant format
























13 Piatto edge Edge plate Piatto edge Edge plate Piatto edge Edge plate Piatto edge Edge plate Piatto edge Edge plate Piatto edge Edge plate Piatto edge Edge plate Piatto edge Edge plate Piatto edge Edge plate Piatto edge Edge plate Piatto edge Edge plate Piatto edge Edge plate TZ001318613 8056444001211 TZ001278613 8056444451146 TZ001218613 8056444456929 TZ001318614 8056444001242 TZ001278614 8056444451153 TZ001218614 8056444456936 TZ001318615 8056444001266 TZ001278615 8056444451160 TZ001218615 8056444456943 TZ001318616 8056444001280 TZ001278616 8056444451177 TZ001218616 8056444456950 cm 31* h 2,8 12 1/4" x h 1 1/4" cm 27* h 2,8 10 3/4" x h 1 1/4" cm 21* h 2,8 8 1/4" x h 1 1/4" cm 31* h 2,8 12 1/4" x h 1 1/4" cm 27* h 2,8 10 3/4" x h 1 1/4" cm 21* h 2,8 8 1/4" x h 1 1/4" cm 31* h 2,8 12 1/4" x h 1 1/4" cm 27* h 2,8 10 3/4" x h 1 1/4" cm 21* h 2,8 8 1/4" x h 1 1/4" cm 31* h 2,8 12 1/4" x h 1 1/4" cm 27* h 2,8 10 3/4" x h 1 1/4" cm 21* h 2,8 8 1/4" x h 1 1/4" inner 6 inner 6 inner 6 inner 6 inner 6 inner 6 inner 6 inner 6 inner 6 inner 6 inner 6 inner 6 master master master master master master master master master master master master Piatto fondo gourmet Gourmet deep plate Piatto fondo gourmet Gourmet deep plate Piatto fondo gourmet Gourmet deep plate Piatto fondo gourmet Gourmet deep plate TZT23288613 8056444437539 TZT23288614 8056444437546 TZT23288615 8056444437553 TZT23288616 8056444437560 cm 28* h 5,2 11" x h 2" cm 28* h 5,2 11" x h 2" cm 28* h 5,2 11" x h 2" cm 28* h 5,2 11" x h 2" inner 6 inner 6 inner 6 inner 6 master master master master 8613 · Selinunte8614 · Positano 8615 · Alicudi 8616 · Panarea factory MADE IN ITALY Selinunte Positano Alicudi Panarea NEW 2024 NEW 2024 NEW 2024
CP001268613 8056444437409
Piatto cous cous Soup plate
AZ022288613 8056444437324
cm 28* h 3
11" x h 1 1/4"
AZ022288614 8056444437331
cm 28* h 3 11" x h 1 1/4"
Piatto piano Dinner plate
Piatto piano Dinner plate
Piatto cous cous Soup plate

8056444437423 cm 26* h 4,6 10 1/4" x h 1 3/4" cm 26* h 4,6 10 1/4" x h 1 3/4" inner 6 inner 6 master master Piatto cous cous Soup plate Piatto cous cous Soup plate CP001268614 8056444437416 CP001268616 8056444437430 cm 26* h 4,6 10 1/4" x h 1 3/4" cm 26* h 4,6 10 1/4" x h 1 3/4" inner 6 inner 6 master master Piatto frutta Dessert plate Piatto frutta Dessert plate Piatto frutta Dessert plate Piatto frutta Dessert plate AZ002198613 8056444001303 AZ002198614 8056444001327 AZ002198615 8056444001358 AZ002198616 8056444001372 cm 20* h 2,5 7 3/4" x h 1" cm 20* h 2,5 7 3/4" x h 1" cm 20* h 2,5 7 3/4" x h 1" cm 20* h 2,5 7 3/4" x h 1" inner 6 inner 6 inner 6 inner 6 master master master master factory MADE IN ITALY Selinunte Positano Alicudi Panarea NEW 2024




AZ022288615 8056444437348
cm 28* h 3 11" x h 1 1/4"
AZ022288616 8056444437355
cm 28* h 3 11" x h 1 1/4"
CI022418613 8056444437485

cm 33* h 2,2
x h 3/4"
CI022418614 8056444437492
cm 33* h 2,2
x h 3/4"
CI022418615 8056444437508
cm 33* h




CI022418616 8056444437515
inner 6 inner 6
master master
Piatto piano Dinner plate
Piatto piano Dinner plate












inner 6 inner 6
master master Piatto pizza Pizza Plate
Piatto pizza Pizza Plate
Piatto pizza Pizza Plate
Piatto pizza Pizza Plate
master master master master
15
13"
13"
13"
3/4"
2,2
x h
13"
3/4"
cm 33* h 2,2 8613 · Selinunte8614 · Positano 8615 · Alicudi 8616 · Panarea
x h
inner 6 inner 6 inner 6 inner 6
CP001268615
























17 Piatto edge Edge plate Piatto edge Edge plate Piatto fondo gourmet Gourmet deep plate Piatto edge Edge plate
edge Edge plate Piatto fondo gourmet Gourmet deep plate Piatto edge Edge plate
edge Edge plate Piatto fondo gourmet Gourmet deep plate Piatto edge Edge plate Piatto edge Edge plate Piatto fondo gourmet Gourmet deep plate TZ001278602 8056444451115 TZ001218602 8056444456882 TZT23288602 8056444456837 TZ001278601 8056444451108 TZ001218601 8056444456899 TZT23288601 8056444453737 TZ001278608 8056444451139 TZ001218608 8056444456912 TZT23288608 8056444453744 TZ001278605 8056444451122 TZ001218605 8056444456905 TZT23288605 8056444456844 cm 27* h 2,8 10 3/4" x h 1 1/4" cm 21* h 2,8 8 1/4" x h 1 1/4" cm 28* h 5,2 11" x h 2" cm 27* h 2,8 10 3/4" x h 1 1/4" cm 21* h 2,8 8 1/4" x h 1 1/4" cm 28* h 5,2 11" x h 2" cm 27* h 2,8 10 3/4" x h 1 1/4" cm 21* h 2,8 8 1/4" x h 1 1/4" cm 28* h 5,2 11" x h 2" cm 27* h 2,8 10 3/4" x h 1 1/4" cm 21* h 2,8 8 1/4" x h 1 1/4" cm 28* h 5,2 11" x h 2" inner 6 inner 6 inner 6 inner 6 inner 6 inner 6 inner 6 inner 6 inner 6 inner 6 inner 6 inner 6 master master master master master master master master master master master master Piatto edge Edge plate Piatto edge Edge plate Piatto edge Edge plate Piatto edge Edge plate TZ001318602 8056444001150 TZ001318601 8056444001136 TZ001318608 8056444001198 TZ001318605 8056444001174 cm 31* h 2,8 12 1/4" x h 1 1/4" cm 31* h 2,8 12 1/4" x h 1 1/4" cm 31* h 2,8 12 1/4" x h 1 1/4" cm 31* h 2,8 12 1/4" x h 1 1/4" inner 6 inner 6 inner 6 inner 6 master master master master 8602 · Oriental 8601 · Origini 8608 · Iride 8605 · Atollo factory MADE IN ITALY Oriental Origini Iride Atollo NEW 2024 NEW 2024 NEW 2024 NEW 2024
Piatto
Piatto



















18 Piatto fondo Soup plate Piatto fondo Soup plate CP001208602 8056444311587 CP001208608 8056444341676 cm 20* h 4,6 7 3/4" x h 1 3/4" cm 20* h 4,6 7 3/4" x h 1 3/4" inner 6 inner 6 master master Piatto fondo Soup plate Piatto fondo Soup plate CP001208601 8056444341652 CP001208605 8056444341669 cm 20* h 4,6 7 3/4" x h 1 3/4" cm 20* h 4,6 7 3/4" x h 1 3/4" inner 6 inner 6 master master Piatto cous cous Soup plate Piatto cous cous Soup plate CP001268602 8056444311587 CP001268608 8056444311662 cm 26* h 4,6 10 1/4" x h 1 3/4" cm 26* h 4,6 10 1/4" x h 1 3/4" inner 6 inner 6 master master Piatto cous cous Soup plate Piatto cous cous Soup plate CP001268601 8056444341713 CP001268605 8056444311655 cm 26* h 4,6 10 1/4" x h 1 3/4" cm 26* h 4,6 10 1/4" x h 1 3/4" inner 6 inner 6 master master Pasta bowl Pasta bowl Pasta bowl Pasta bowl Pasta bowl Pasta bowl Pasta bowl Pasta bowl OL023278602 8056444328325 OL023278601 8056444311679 OL023278608 8056444341744 OL023278605 8056444341737 cm 27* h 5 10 3/4" x h 2" cm 27* h 5 10 3/4" x h 2" cm 27* h 5 10 3/4" x h 2" cm 27* h 5 10 3/4" x h 2" inner 6 inner 6 inner 6 inner 6 master master master master 8602 · Oriental 8601 · Origini 8608 · Iride 8605 · Atollo factory MADE IN ITALY Oriental Origini Iride Atollo





















20 21 Piatto piano Dinner plate Piatto piano Dinner plate Piatto dessert Dessert plate Piatto dessert Dessert plate CP000268602 8056444328363 CP000268608 8056444341553 CP002208602 8056444328363 CP002208608 8056444341614 cm 26* h 3 10 1/4" x h 1 1/4" cm 26* h 3 10 1/4" x h 1 1/4" cm 20* h 2,7 7 3/4" x h 1" cm 20* h 2,7 7 3/4" x h 1" inner 6 inner 6 inner 6 inner 6 master master master master Piatto piano Dinner plate Piatto piano Dinner plate Piatto dessert Dessert plate Piatto dessert Dessert plate CP000268601 8056444341539 CP000268605 8056444341546 CP002208601 8056444341591 CP002208605 8056444341607 cm 26* h 3 10 1/4" x h 1 1/4" cm 26* h 3 10 1/4" x h 1 1/4" cm 20* h 2,7 7 3/4" x h 1" cm 20* h 2,7 7 3/4" x h 1" inner 6 inner 6 inner 6 inner 6 master master master master Piatto pizza Pizza Plate Piatto pizza Pizza Plate Piatto pizza Pizza Plate Piatto pizza Pizza Plate CI022418602 8056444341782 CI022418601 8056444341775 CI022418608 8056444341805 CI022418605 8056444341799 cm 33* h 3,4 13" x h 1 1/4" cm 33* h 3,4 13" x h 1 1/4" cm 33* h 3,4 13" x h 1 1/4" cm 33* h 3,4 13" x h 1 1/4" inner 6 inner 6 inner 6 inner 6 master master master master Rotondo piano Charger Plate Rotondo piano Charger Plate Rotondo piano Charger Plate Rotondo piano Charger Plate CP022318602 8056444311723 CP022318601 8056444311709 CP022318608 8056444311716 CP022318605 8056444311716 cm 31* h 3,4 12 1/4" x h 1 1/4" cm 31* h 3,4 12 1/4" x h 1 1/4" cm 31* h 3,4 12 1/4" x h 1 1/4" cm 31* h 3,4 12 1/4" x h 1 1/4" inner 6 inner 6 inner 6 inner 6 master master master master 8602 · Oriental 8601 · Origini 8608 · Iride 8605 · Atollo 8602 · Oriental 8601 · Origini 8608 · Iride 8605 · Atollo factory MADE IN ITALY Oriental Origini Iride Atollo















23 Piatto pizza Pizza plate Rotondo piano Charger plate Piatto fondo Deep plate Piatto pizza Pizza plate Rotondo piano Charger plate Piatto edge Edge plate Piatto pizza Pizza plate Rotondo piano Charger plate Piatto edge Edge plate CI022418725 8056444397925 AZ022288725 8056444403084 CP001268725 8056444403145 CI022418726 8056444397932 AZ022288726 8056444403091 CP001268726 8056444403152 CI022418727 8056444397949 AZ022288727 8056444403107 CP001268727 8056444403169 cm 33* h 3,4 13" x h 1 1/3" cm 28* h 3 11" x h 1 3/4" cm 26* h 4,6 · cc 1200 10 1/4" x h 1 3/4" · 40 1/4 oz cm 33* h 3,4 13" x h 1 1/3" cm 28* h 3 11" x h 1 3/4" cm 26* h 4,6 · cc 1200 10 1/4" x h 1 3/4" · 40 1/4 oz cm 33* h 3,4 13" x h 1 1/3" cm 28* h 3 11" x h 1 3/4" cm 26* h 4,6 · cc 1200 10 1/4" x h 1 3/4" · 40 1/4 oz inner 6 inner 6 inner 6 inner 6 inner 6 inner 6 inner 6 inner 6 inner 6 master master master master master master master master master 8726 · Blue 8725 · Grey 8727 · Brown
MADE IN ITALY
terra
giotto




collezione di articoli made in Italy dipinti a mano in quattro colori con particolari pennellate circolari ideali per il ristorante moderno giovane e informale collection of hand-painted items made in Italy in four colours with particular circular brushstrokes, ideal for the modern and young restaurant














MADE IN ITALY





24 25 1054 ·
1054
1052
1053
1051
1051
Piatto cous cous Cous cous plate CP001261052 8056444065008 cm 26* h 5* 26 · cc 1100 10 1/4" x h 2" x 10 1/4" · 37 1/4 oz. inner 6 master Piatto fondo coupe Deep coupe plate CP023301052 8056444046335 cm 30* h 4,5* 30 · cc 1500 11 3/4" x h 1 3/4" x 11 3/4" · 50 3/4 oz. inner 6 master 12 Piatto fondo coupe Deep coupe plate CP023301053 8056444049596 cm 30* h 4,5* 30 · cc 1500 11 3/4" x h 1 3/4" x 11 3/4" · 50 3/4 oz. inner 6 master 12 Piatto fondo coupe Deep coupe plate CP023301054 8056444049602 cm 30* h 4,5* 30 · cc 1500 11 3/4" x h 1 3/4" x 11 3/4" · 50 3/4 oz. inner 6 master 12 Piatto fondo coupe Deep coupe plate CP023301051 8056444015768 cm 30* h 4,5* 30 · cc 1500 11 3/4" x h 1 3/4" x 11 3/4" · 50 3/4 oz. inner 6 master 12 Piatto cous cous Cous cous plate CP001261051 8056444013269 cm 26* h 5* 26 · cc 1100 10 1/4" x h 2" x 10 1/4" · 37 1/4 oz. inner 6 master Piatto cous cous Cous cous plate CP001261053 8056444078497 cm 26* h 5* 26 · cc 1100 10 1/4" x h 2" x 10 1/4" · 37 1/4 oz. inner 6 master Piatto cous cous Cous cous plate CP001261054 8056444082487 cm 26* h 5* 26 · cc 1100 10 1/4" x h 2" x 10 1/4" · 37 1/4 oz. inner 6 master Rotondo piano Round plate TY022321051 8056444023473 cm 31* h 2,5* 31 12 1/4" x h 1" x 12 1/4" inner 6 master Rotondo piano Round plate TY022321052 8056444038248 cm 31* h 2,5* 31 12 1/4" x h 1" x 12 1/4" inner 6 master Rotondo piano Round plate TY022321053 8056444038255 cm 31* h 2,5* 31 12 1/4" x h 1" x 12 1/4" inner 6 master Rotondo piano Round plate TY022321054 8056444038262 cm 31* h 2,5* 31 12 1/4" x h 1" x 12 1/4" inner 6 master
piano Dinner plate TY000271051 8056444020823 cm 27,3* h 2* 27,3 10 3/4" x h 3/4" x 10 3/4" inner 12 master 24
piano Dinner plate TY000271052 8056444046298 cm 27,3* h 2* 27,3 10 3/4" x h 3/4" x 10 3/4" inner 12 master 24
piano Dinner plate TY000271053 8056444046304 cm 27,3* h 2* 27,3 10 3/4" x h 3/4" x 10 3/4" inner 12 master 24
piano Dinner plate TY000271054 8056444046311 cm 27,3* h 2* 27,3 10 3/4" x h 3/4" x 10 3/4" inner 12 master 24
Yellow-Giallo
· Yellow-Giallo 1052 · Light blue-Azzurro
· Light blue-Azzurro 1053 · Brick red-Mattone
· Brick red-Mattone
· Grey-Grigio
· Grey-Grigio
Piatto
Piatto
Piatto
Piatto






















26 27 Rotondo pizza Pizza plate CI022411051 8056444004250 cm 32,2* h 2* 32,2 12 3/4" x h 3/4" x 12 3/4" inner 6 master Rotondo pizza Pizza plate CI022411052 8056444036299 cm 32,2* h 2* 32,2 12 3/4" x h 3/4" x 12 3/4" inner 6 master Rotondo pizza Pizza plate CI022411053 8056444036305 cm 32,2* h 2* 32,2 12 3/4" x h 3/4" x 12 3/4" inner 6 master Rotondo pizza Pizza plate CI022411054 8056444036312 cm 32,2* h 2* 32,2 12 3/4" x h 3/4" x 12 3/4" inner 6 master Piatto piano Dinner plate AZ000241051 8056444173550 cm 25 9 3/4" inner 1 master 12 Piatto piano Dinner plate AZ000241054 8056444173581 cm 25 9 3/4" inner 1 master 12 Piatto piano Dinner plate AZ000241053 8056444173574 cm 25 9 3/4" inner 1 master 12 Piatto piano Dinner plate AZ000241052 8056444173567 cm 25 9 3/4" inner 1 master 12 Piatto fondo Soup plate AZ001201052 8056444173642 cm 21 8 1/4" inner 1 master 12 Piatto fondo Soup plate AZ001201051 8056444173635 cm 21 8 1/4" inner 1 master 12 Piatto fondo Soup plate AZ001201053 8056444173659 cm 21 8 1/4" inner 1 master 12 Piatto fondo Soup plate AZ001201054 8056444173666 cm 21 8 1/4" inner 1 master 12 Piatto dessert Dessert plate AZ002191051 8056444173710 cm 20 7 3/4" inner 1 master 12 Piatto dessert Dessert plate AZ002191052 8056444173727 cm 20 7 3/4" inner 1 master 12 Piatto dessert Dessert plate AZ002191053 8056444173734 cm 20 7 3/4" inner 1 master 12 Piatto dessert Dessert plate AZ002191054 8056444173741 cm 20 7 3/4" inner 1 master 12 1054 ·
1054 ·
1052 · Light
1052 · Light blue-Azzurro 1053 ·
1053 ·
1051
1051
giotto MADE IN ITALY
Yellow-Giallo
Yellow-Giallo
blue-Azzurro
Brick red-Mattone
Brick red-Mattone
· Grey-Grigio
· Grey-Grigio
un nuovo materiale all'avanguardia per una forma semplice ma sofisticata, il colore e la texture ricordano il tufo a new avant-garde material with a plain and sofisticated shape tuff texture and colour













28 Piatto piano Dinner plate Piatto piano Dinner plate Piatto piano Dinner plate Piatto piano Dinner plate RDG22325980 8056444457735 RDG00285980 8056444457698 RDG00225980 8056444457650 RDG00175980 8056444457612 cm 32* h 1,5 12 1/2" x h 1/2" cm 27,5* h 1,5 10 3/4" x h 1/2" cm 22,5* h 1,5 8 3/4" x h 1/2" cm 17,5* h 1,5 7" x h 1/2" inner 6 inner 6 inner 6 inner 6 master 12 master 12 master 12 master 12 Piatto fondo coupe Coupe deep plate RDG01235980 8056444457773 cm 23* h 5 9" x h 2" inner 6 master 12 Piatto rettangolare Rectangular plate RDG00275980 8056444457858 cm 26,5* 16 10 1/2" x 6 1/4" inner 6 master 12 Piatto rettangolare Rectangular plate RDG00265980 8056444457810 cm 25,5* 12,5 10" x 5" inner 12 master 24 Bowl Bowl Coppetta Small bowl RDG68155980 8056444457919 RDG04075980 8056444458053 cm 15,5* h 7 6" x h 2 3/4" cm 7* h 3 2 3/4" x h 1 1/4" inner 6 inner 6 master 24 master 60 Insalatiera Salad bowl RDG24205980 8056444457872 cm 20* h 7,5 7 3/4" x h 3" inner 6 master 12 redstrong tuff
* Garantito 5 anni contro la sbeccatura dei bordi (vedi pagina 6) Guaranteed for 5 years against edge chipping (see page 6) WARR A NTY 5 Y E ARS * NEW 2024 NEW 2024 NEW 2024 NEW 2024 NEW 2024 NEW 2024
Emerald Browny Iceland

















31 Piatto piano Dinner plate AT000308072 8056444360097 cm 30 11 3/4" inner 6 master Piatto piano Dinner plate AT000278072 8056444360035 cm 27 10 3/4" inner 6 master Piatto dessert Dessert plate AT002218090 8056444436013 cm 21 8 1/4" inner 12 master Piatto piano Dinner plate AT000238072 8056444359978 cm 23 9" inner 12 master Piatto piano Dinner plate AT000308071 8056444360080 cm 30 11 3/4" inner 6 master Piatto piano Dinner plate AT000278071 8056444360028 cm 27 10 3/4" inner 6 master Piatto dessert Dessert plate AT002218072 8056444359916 cm 21 8 1/4" inner 12 master Piatto piano Dinner plate AT000238071 8056444359961 cm 23 9" inner 12 master Piatto piano Dinner plate AT000308090 8056444436075 cm 30 11 3/4" inner 6 master Piatto piano Dinner plate AT000278090 8056444436051 cm 27 10 3/4" inner 6 master Piatto dessert Dessert plate AT002218071 8056444359909 cm 21 8 1/4" inner 12 master Piatto piano Dinner plate AT000238090 8056444436037 cm 23 9" inner 12 master 8072 · Emerald 8071 · Browny 8090 · Iceland attitude
WARR A NTY 5 Y E ARS *
*
Garantito 5 anni contro la sbeccatura dei bordi (vedi pagina 6)
Guaranteed
for 5 years against edge chipping (see page 6)





















32 Piatto fondo Soup plate AT001258072 8056444360219 cm 25* h 5,5 9 3/4" x h 2 1/4" inner 6 master Piatto fondo Soup plate AT001258071 8056444360202 cm 25* h 5,5 9 3/4" x h 2 1/4" inner 6 master Piatto fondo Soup plate AT001218071 8056444360141 cm 21* h 4,5 8 1/4" x h 1 3/4" inner 6 master Piatto fondo gourmet Gourmet deep plate AT001288071 8056444360325 cm 28* h 6 11" x h 2 1/4" inner 6 master Piatto fondo Soup plate AT001218072 8056444360158 cm 21* h 4,5 8 1/4" x h 1 3/4" inner 6 master Piatto fondo gourmet Gourmet deep plate AT001288072 8056444360332 cm 28* h 6 11" x h 2 1/4" inner 6 master Piatto fondo Soup plate AT001258090 8056444436112 cm 25* h 5,5 9 3/4" x h 2 1/4" inner 6 master Piatto fondo Soup plate AT001218090 8056444436099 cm 21* h 4,5 8 1/4" x h 1 3/4" Piatto fondo gourmet Gourmet deep plate AT001288090 8056444436150 cm 28* h 6 11" x h 2 1/4" inner 6 master 8072 · Emerald 8071 · Browny 8090 · Iceland Piatto fondo gourmet Gourmet deep plate AT001268072 8056444360271 cm 25* h 5,5 9 3/4" x h 2 1/4" inner 6 master Piatto fondo gourmet Gourmet deep plate AT001268071 8056444360264 cm 25* h 5,5 9 3/4" x h 2 1/4" inner 6 master Piatto fondo gourmet Gourmet deep plate AT001268072 8056444360271 cm 25* h 5,5 9 3/4" x h 2 1/4" inner 6 master attitude Emerald
Iceland * Garantito 5 anni contro la sbeccatura dei bordi (vedi pagina 6) Guaranteed for 5 years against edge chipping (see page 6) WARR A NTY 5 Y E ARS *
Browny

















35 Piatto edge Edge plate AT001278072 8056444360578 cm 27* h 2,8 10 3/4" x h 1 1/4" inner 6 master Piatto edge Edge plate AT001238072 8056444360516 cm 23* h 2,5 9" x h 1" inner 6 master Piatto rettangolare Rectangular plate AT022368072 8056444360691 cm 36* 16,5 14 1/4" x 6 1/2" inner 6 master Piatto edge Edge plate AT001278071 8056444360561 cm 27* h 2,8 10 3/4" x h 1 1/4" inner 6 master Piatto edge Edge plate AT001238071 8056444360509 cm 23* h 2,5 9" x h 1" inner 6 master Piatto rettangolare Rectangular plate AT022368071 8056444360684 cm 36* 16,5 14 1/4" x 6 1/2" inner 6 master Piatto edge Edge plate AT001278090 8056444436235 cm 27* h 2,8 10 3/4" x h 1 1/4" inner 6 master Piatto edge Edge plate AT001238090 8056444436211 cm 23* h 2,5 9" x h 1" inner 6 master Piatto rettangolare Rectangular plate AT022368090 8056444436273 cm 36* 16,5 14 1/4" x 6 1/2" inner 6 master 8072 · Emerald 8071 · Browny 8090 · Iceland Piatto rettangolare Rectangular plate AT022248072 8056444360639 cm 24* 15 9 1/2" x 6" inner 12 master Piatto rettangolare Rectangular plate AT022248071 8056444360622 cm 24* 15 9 1/2" x 6" inner 12 master Piatto rettangolare Rectangular plate AT022248090 8056444436259 cm 24* 15 9 1/2" x 6" inner 12 master attitude
*
Guaranteed
WARR A NTY 5 Y E ARS *
Emerald Browny Iceland
Garantito 5 anni contro la sbeccatura dei bordi (vedi pagina 6)
for 5 years against edge chipping (see page 6)
Piattino caffè Coffee saucer




Piattino the The saucer







Piatto pane Bread plate AT003158072 8056444359862





inner 12 master
Piatto pane Bread plate
Piatto pane Bread plate
inner 12 master





36 37 Tazza caffè Coffee cup AT015088072 8056444360752 cc 80 2 3/4 oz. inner 12 master Tazza the The cup AT016108072 8056444360875 cc 220 7 1/4 oz. inner 12 master Piattino caffè Coffee saucer AT005088072 8056444360813 cm 12 4 3/4" inner 12 master Piattino the The saucer AT006108072 8056444360936 cm 16 6 1/4" inner 12 master Coppetta Bowl AT004158072 8056444360455 cm 15* h 5 6" x h 2" inner 12 inner 12 master master Insalatiera Salad bowl AT024228072 8056444360394 cm 22* h 7,5 8 3/4" x h 3" inner 6 master Insalatiera Salad bowl AT024228071 8056444360387 cm 22* h 7,5 8 3/4" x h 3" inner 6 master Coppetta Bowl AT004158071 8056444360448 cm 15* h 5 6" x h 2" Coppetta Bowl AT004158090 8056444436198 cm 15* h 5 6" x h 2" inner 12 master Insalatiera Salad bowl AT024228090 8056444436174 cm 22* h 7,5 8 3/4" x h 3" inner 6 master Tazza caffè Coffee cup AT015088071 8056444360745 cc 80 2 3/4 oz. inner 12 master Tazza the The cup AT016108071 8056444360868 cc 220 7 1/4 oz. inner 12 master Piattino caffè Coffee saucer AT005088071 8056444360806 cm 12 4 3/4" inner 12 master Piattino the The saucer AT006108071 8056444360929 cm 16 6 1/4" inner 12 master Tazza caffè Coffee cup AT015080000 8056444360738
2
7 1/4
cc 80
3/4 oz. inner 12 master Tazza the The cup AT016100000 8056444360851 cc 220
oz. inner 12 master
AT005088090
cm
4 3/4"
8056444436297
12
inner 12 master
AT006108090
cm 16 6 1/4"
8056444436310
inner 12 master
cm
6"
15
AT003158090
cm
6"
8056444435993
15
AT003158071
cm 15 6"
8072 · Emerald 8071 · Browny 8090 · Iceland 8072 · Emerald 8071 · Browny 8090 · Iceland
8056444359855
inner 12 master
bloom blue & brown
suggestioni marine e naturali per queste collezioni di porcellana con colori reattivi






and natural atmosheres with this reactive colours porcelain collection













39 Piatto edge Edge plate BM000098088 8056444448429 cm 8,5* h 2,5 3 1/4" x h 1" inner 6 master 48 Piatto edge Edge plate BM000128088 8056444448474 cm 12*h 2,5 4 3/4" x h 1" inner 4 master 12 Bowl edge Edge bowl BM004128088 8056444448535 cm 12*h 5 4 3/4" x h 2" inner 2 master 16 Piatto edge Edge plate BM000178088 8056444448504 cm 16,8*h 2,5 6 3/4" x h 1" inner 3 master 12 Piatto edge Edge plate BM000268088 8056444375749 cm 27* h 2,5 10 3/4" x h 1" inner 3 master 12 Piatto edge Edge plate BM000208088 8056444375725 cm 20* h 2,5 7 3/4" x h 1" inner 3 master 12
NEW 2024 NEW 2024 NEW 2024 NEW 2024
marines


























40 Piatto piano Dinner plate BM000278088 8056444375589 cm 27 10 3/4" inner 6 master 24 Piatto dessert Dessert plate BM002218088 8056444375565 cm 21 8 1/4" inner 6 master 24 Piatto cous cous Cous cous plate BM001268088 8056444375626 cm 26* h 5 10 1/4" x h 2" inner 6 master 24 Piatto fondo Soup plate BM001218088 8056444375688 cm 21* h 5 8 1/4" x h 2" inner 6 master 24 Piatto ovale Oval plate BM020368088 8056444375664 cm 36,5* 26 14 1/4" x h 3/4" x 10 1/4" inner 4 master 12 Piatto ovale Oval plate BM020308088 8056444375640 cm 30* 21,5 11 3/4" x h 3/4" x 8 1/2" inner 4 master 12 Coppetta Bowl BM004158088 8056444375701 cm 15,5* h 5 6" x h 2" inner 6 master 24 Pasta bowl Pasta bowl BM023268088 8056444375602 cm 26* h 5 10 1/4" x h 2" inner 6 master Ovale edge Edge oval plate BM020318088 8056444448566 cm 30*15*h 2,5 12" x 6" x h 1" inner 3 master 12 Piatto rotondo Round plate BM022318088 8056444448597 cm 30,5*h 2,5 12" x h 1" inner 2 master 12 NEW 2024 NEW 2024
reef oyster















43 Piatto rettangolare Rectangular plate RY022355961 8056444450842 cm 35*20* h 2,5 13 3/4" x 5"x h 2" inner 6 master Coppetta Bowl RY068145961 8056444450873 cm 14* h7 5 1/2" x h 2 3/4" inner 2 master 16 Piatto rotondo Round plate RY022335961 8056444450699 cm 33* h 2,8 13 1/4" x h 1" inner 6 master Piatto piano Dinner plate RY000285961 8056444450729 cm 28* h 2,8 11" x h 1" inner 6 master 24 Piatto rettangolare Rectangular plate RY022235961 8056444450804 cm 23*13* h 2,5 9" x 5"x h 2" inner 6 master 48 Piatto cous cous Cous cous plate RY001245961 8056444450767 cm 24,5* h 5 9 3/4" x h 2" inner 6 master 24
NEW 2024 NEW 2024 NEW 2024 NEW 2024 NEW 2024 NEW 2024











44 Piatto piano Dinner plate RY000325962 8056444450989 cm 32*30*h 2 12 1/2" x 12" x h 3/4" inner 2 master 12 Piatto fondo coupe Deep coupe plate RY001235962 8056444451047 cm 22,9*20*h 7 9" x 7 3/4" x h 2 3/4" inner 6 master 24 Piatto ovale Oval plate RY020305962 8056444451061 cm 29,5*20*h 3 11 1/2" x 7 3/4"x h 1 1/4" inner 4 master 12 Piatto piano Dinner plate RY000295962 8056444451016 cm 29*28*h 3 11 1/2" x 11" x h 1 1/4" inner 3 master 12 reef vertigo NEW 2024 NEW 2024 NEW 2024 NEW 2024
reef marine











47 Piatto piano Dinner plate RY000325960 8056444434149 cm 32*30*h 2 12 1/2" x 12" x h 3/4" inner 2 master 12 Piatto fondo Soup plate RY001235960 8056444434224 cm 23*20*h 7 9" x 7 3/4" x h 2 3/4" inner 6 master 24 Piatto ovale Oval plate RY020305960 8056444434262 cm 30*20*h 3 12" x 7 3/4"x h 1 1/4" inner 2 master 12 Piatto piano Dinner plate RY000295960 8056444434187 cm 29*28*h 3 11 1/2" x 11" x h 1 1/4" inner 3 master 12













48 49 Coppetta Bowl EP104208092 8056444450002 cm 19,5* h 5,5 7 3/4" x h 2 1/4" inner 2 master 16 Coppetta Bowl EP104178092 8056444449952 cm 16,5* h 5 6 1/2" x h 2" inner 2 master 24 Coppetta Bowl EP104128092 8056444449853 cm 11,5* h 4,5 4 1/2" x h 1 3/4" inner 6 master 72 Coppetta Bowl EP104148092 8056444449907 cm 14.5* h 4,5 5 3/4" x h 1 3/4" inner 4 master 48 Coppetta Bowl EP104178093 8056444449969 cm 16,5* h 5 6 1/2" x h 2" inner 2 master 24 Coppetta Bowl EP104208093 8056444450019 cm 19,5* h 5,5 7 3/4" x h 2 1/4" inner 2 master 16 Coppetta Bowl EP104128093 8056444449860 cm 11,5* h 4,5 4 1/2" x h 1 3/4" inner 6 master 72 Coppetta Bowl EP104148093 8056444449914 cm 14.5* h 4,5 5 3/4" x h 1 3/4" inner 4 master 48 Coppetta Bowl EP104178094 8056444449976 cm 16,5* h 5 6 1/2" x h 2" inner 2 master 24 Coppetta Bowl EP104208094 8056444450026 cm 19,5* h 5,5 7 3/4" x h 2 1/4" inner 2 master 16 Coppetta Bowl EP104128094 8056444449877 cm 11,5* h 4,5 4 1/2" x h 1 3/4" inner 6 master 72 Coppetta Bowl EP104148094 8056444449921 cm 14.5* h 4,5 5 3/4" x h 1 3/4" inner 4 master 48 Coppetta Bowl EP104178095 8056444449983 cm 16,5* h 5 6 1/2" x h 2" inner 2 master 24 Coppetta Bowl EP104208095 8056444450033 cm 19,5* h 5,5 7 3/4" x h 2 1/4" inner 2 master 16 Coppetta Bowl EP104128095 8056444449884 cm 11,5* h 4,5 4 1/2" x h 1 3/4" inner 6 master 72 Coppetta Bowl EP104148095 8056444449938 cm 14.5* h 4,5 5 3/4" x h 1 3/4" inner 4 master 48 8092 · White Teal 8092 · White Teal 8094 · Bronze Teal 8094 · Bronze Teal 8093 · Moca Black 8093 · Moca Black 8095 · Bronze Grey 8095 · Bronze Grey elipse bowl in 4 misure per 4 finiture diverse ideali per piatti creativi e di tendenza 4 sizes and 4 colours bowl perfect for creative and trendy recipes White Teal Moca Black Bronze Teal Bronze Grey NEW 2024 NEW 2024 NEW 2024 NEW 2024



















50 51 Coppetta wasabi Wasabi small bowl JP104110779 8056444464375 cm 10,5* h 2*8 4 1/4" x h 3/4"x 3 1/4" inner 8 master 16 Coppetta wasabi Wasabi small bowl JP104110775 8056444464382 cm 10,5* h 2*8 4 1/4" x h 3/4"x 3 1/4" inner 8 master 16 Piattino sushi roll Sushi roll plate JP100220779 8056444464337 cm 22* h 1*8 8 3/4" x h 3/8" x 3 1/4" inner 6 master 24 Piattino sushi roll Sushi roll plate JP100220775 8056444464344 cm 22* h 1*8 8 3/4" x h 3/8" x 3 1/4" inner 6 master 24 Piatto dessert Dessert plate JP102180779 8056444464290 cm 18,5* h 2 7 1/4" x h 3/4" inner 6 master 24 Piatto dessert Dessert plate JP102180775 8056444464306 cm 18,5* h 2 7 1/4" x h 3/4" inner 6 master 24
wasabi Wasabi small bowl JP104110767 8056444464399 cm 10,5* h 2*8 4 1/4" x h 3/4"x 3 1/4" inner 8 master 16
sushi roll Sushi roll plate JP100220767 8056444464351 cm 22* h 1*8 8 3/4" x h 3/8" x 3 1/4" inner 6 master 24 Piatto dessert Dessert plate JP102180767 8056444464313 cm 18,5* h 2 7 1/4" x h 3/4 inner 6 master 24 Rettangolare fondo coupe Deep coupe rectangular JP101260767 8056444464672 cm 27,5* h 4* 18,5 · cc 750 10 3/4" x h 1 1/2" x 7 1/4" · 25 1/4 oz. inner 6 master 24 Rettangolare fondo coupe Deep coupe rectangular JP101260779 8056444048476 cm 27,5* h 4* 18,5 · cc 750 10 3/4" x h 1 1/2" x 7 1/4" · 25 1/4 oz. inner 6 master 24 Rettangolare fondo coupe Deep coupe rectangular JP101260775 8056444398762 cm 27,5* h 4* 18,5 · cc 750 10 3/4" x h 1 1/2" x 7 1/4" · 25 1/4 oz. inner 6 master 24 0779 · Nero-Black 0779 · Nero-Black 0767 · New Brown 0767 · New Brown 0775 · Blu-Blue 0775 · Blu-Blue jap
collezione di articoli in stoneware per la cucina asiatica e fusion
collection of stoneware items
and
Black Blue New Brown NEW 2024 NEW 2024 NEW 2024 NEW 2024
Coppetta
Piattino
una
a
for asian
fusion kitchen

















53 Rettangolare sashimi Sashimi rectangular plate JP100260775 8056444398755 cm 28* h 2,5* 13,5 11" x h 1" x 5 1/4" inner 6 master 36 Rettangolare sashimi Sashimi rectangular plate JP100260779 8056444048490 cm 28* h 2,5* 13,5 11" x h 1" x 5 1/4" inner 6 master 36 Coppetta con coperchio Bowl with lid JP104100767 8056444465037 cm 10 x h 8 · 250 cc 4" x h 3 1/4" · 8 1/4 oz inner 6 master 48 Ramen bowl Ramen bowl JP168180767 8056444465006 cm 18,5* h 8,5* 18,5 · cc 1200 7 1/4" x h 3 1/4" x 7 1/4" · 40 1/2 oz. inner 6 master 24 Piatto rettangolare Rectangular plate JP100210767 8056444468069 cm 21* h 2,5* 12,8 · cc 82 8 1/4" x h 1"x 5" · 2,77 oz. inner 6 master 36 Rettangolare sashimi Sashimi rectangular plate JP100260767 8056444464641 cm 28* h 2,5* 13,5 11" x h 1" x 5 1/4" inner 6 master 36 Ramen bowl Ramen bowl JP168180779 8056444048513 cm 18,5* h 8,5* 18,5 · cc 1200 7 1/4" x h 3 1/4" x 7 1/4" · 40 1/2 oz. inner 6 master 24 Ramen bowl Ramen bowl JP168180775 8056444398878 cm 18,5* h 8,5* 18,5 · cc 1200 7 1/4" x h 3 1/4" x 7 1/4" · 40 1/2 oz. inner 6 master 24 Piatto rettangolare Rectangular plate JP100210775 8056444468052 cm 21* h 2,5* 12,8 · cc 81 8 1/4" x h 1"x 5" · 2,74 oz. inner 6 master 36 Piatto rettangolare Rectangular plate JP100210779 8056444468045 cm 21* h 2,5* 12,8 · cc 80 8 1/4" x h 1"x 5" · 2,71 oz. inner 6 master 36 Coppetta con coperchio Bowl with lid JP104100779 8056444410600 cm 10 x h 8 · 250 cc 4" x h 3 1/4" · 8 1/4 oz inner 6 master 48 Coppetta con coperchio Bowl with lid JP104100775 8056444410594 cm 10 x h 8 · 250 cc 4" x h 3 1/4" · 8 1/4 oz inner 6 master 48 0779 · Nero-Black 0767 · New Brown 0775 · Blu-Blue jap Black Blue New Brown NEW 2024 NEW 2024 NEW 2024 NEW 2024

















54 Riso bowl Rice bowl JP168140767 8056444464979 cm 14,3* h 7* 14,3 · cc 600 5 3/4" x h 2 3/4" x 5 3/4" · 20 1/4 oz. inner 6 master 48 Mini bowl Mini bowl JP104060767 8056444464702 cm 6,7* h 3* 6,7 · cc 60 2 3/4" x h 1 1/4" x 2 3/4" · 2 oz. inner 24 master 192 Bowl piccola Small bowl JP104090767 8056444464764 cm 9,5* h 4,3* 9,5 · cc 160 3 3/4" x h 1 3/4" x 3 3/4" · 5 1/2 oz. inner 12 master 144 Bowl media Medium bowl JP104120767 8056444465068 cm 11,5* h 6,7* · cc 300 4 1/2" x h 2 3/4" · 10 1/4 oz. inner 6 master 72 Mini bowl Mini bowl JP104060779 8056444089165 cm 6,7* h 3* 6,7 · cc 60 2 3/4" x h 1 1/4" x 2 3/4" · 2 oz. inner 24 master 192 Bowl piccola Small bowl JP104090779 8056444048551 cm 9,5* h 4,3* 9,5 · cc 160 3 3/4" x h 1 3/4" x 3 3/4" · 5 1/2 oz. inner 12 master 144 Riso bowl Rice bowl JP168140779 8056444048537 cm 14,3* h 7* 14,3 · cc 600 5 3/4" x h 2 3/4" x 5 3/4" · 20 1/4 oz. inner 6 master 48 Bowl media Medium bowl JP104120779 8056444410662 cm 11,5* h 6,7* · cc 300 4 1/2" x h 2 3/4" · 10 1/4 oz. inner 6 master 72 Mini bowl Mini bowl JP104060775 8056444398779 cm 6,7* h 3* 6,7 · cc 60 2 3/4" x h 1 1/4" x 2 3/4" · 2 oz. inner 24 master 192 Bowl piccola Small bowl JP104090775 8056444398793 cm 9,5* h 4,3* 9,5 · cc 160 3 3/4" x h 1 3/4" x 3 3/4" · 5 1/2 oz. inner 12 master 144 Riso bowl Rice bowl JP168140775 8056444398861 cm 14,3* h 7* 14,3 · cc 600 5 3/4" x h 2 3/4" x 5 3/4" · 20 1/4 oz. inner 6 master 48 Bowl media Medium bowl JP104120775 8056444410679 cm 11,5* h 6,7* · cc 300 4 1/2" x h 2 3/4" · 10 1/4 oz. inner 6 master 72 0779 · Nero-Black 0767 · New Brown 0775 · Blu-Blue jap Black Blue New Brown NEW 2024 NEW 2024 NEW 2024 NEW 2024


















56 Coppetta soja Soya sauce cup JP104080775 8056444398786 cm 8* h 2* 8 · cc 40 3 1/4" x h 3/4" x 3 1/4" · 1 1/4 oz. inner 24 master 192 Bottiglia sake Sake bottle JP1BT140775 8056444398748 cm 7* h 13,8* 7 · cc 260 2 3/4" x h 5 1/2" x 2 3/4" · 8 3/4 oz. inner 6 master 48 Bottiglietta soja Soja bottle JP1BTOL0775 8056444398731 cm 6,5* h 10* · cc 150 2 9/16" x h 3 15/16" · 5 oz. inner 6 master 72 Coppetta soja Soya sauce cup JP104080779 8056444048735 cm 8* h 2* 8 · cc 40 3 1/4" x h 3/4" x 3 1/4" · 1 1/4 oz. inner 24 master 192 Bottiglia sake Sake bottle JP1BT140779 8056444048612 cm 7* h 13,8* 7 · cc 260 2 3/4" x h 5 1/2" x 2 3/4" · 8 3/4 oz. inner 6 master 48 Bottiglietta soja Soja bottle JP1BTOL0779 8056444294019 cm 6,5* h 10* · cc 150 2 9/16" x h 3 15/16" · 5 oz. inner 6 master 72 Bicchiere sake Sake tumbler JP157050767 8056444464948 cm 5,7* h 5* 5,7 · cc 90 2 1/4" x h 2" x 2 1/4" · 3 oz. inner 18 master 216 Bottiglia sake Sake bottle JP1BT140767 8056444464610 cm 7* h 13,8* 7 · cc 260 2 3/4" x h 5 1/2" x 2 3/4" · 8 3/4 oz. inner 6 master 48 Bottiglietta soja Soja bottle JP1BTOL0767 8056444464580 cm 6,5* h 10* · cc 150 2 9/16" x h 3 15/16" · 5 oz. inner 6 master 72 Coppetta soja Soya sauce cup JP104080767 8056444464733 cm 8* h 2* 8 · cc 40 3 1/4" x h 3/4" x 3 1/4" · 1 1/4 oz. inner 24 master 192 Bicchiere sake Sake tumbler JP157050775 8056444398854 cm 5,7* h 5* 5,7 · cc 90 2 1/4" x h 2" x 2 1/4" · 3 oz. inner 18 master 216 Bicchiere sake Sake tumbler JP157050779 8056444048599 cm 5,7* h 5* 5,7 · cc 90 2 1/4" x h 2" x 2 1/4" · 3 oz. inner 18 master 216 0779 · Nero-Black 0767 · New Brown 0775 · Blu-Blue jap Black Blue New Brown NEW 2024 NEW 2024 NEW 2024 NEW 2024




















58 Cucchiaio Spoon JP1CUA10767 8056444465099 cm 13,4* 4 5 1/4" x 1 4/7" inner 24 master 288 Contenitore ovale Oval slanting bowl JP120300767 8056444464825 cm 31,3* h 10,7* 20,3 · cc 700 12 1/4" x h 4 1/4" x 8" · 23 3/4 oz. inner 4 master 12 Contenitore ovale Oval slanting bowl JP120350767 8056444464856 cm 35,8* h 13* 23,2 · cc 1380 14" x h 5" x 9 1/4" · 46 3/4 oz. inner 2 master 6 Contenitore ovale Oval slanting bowl JP120250767 8056444464795 cm 26* h 9,4* 17,5 · cc 450 10 1/4" x h 3 3/4" x 7" · 15 1/4 oz. inner 4 master 16 Contenitore ovale Oval slanting bowl JP120300779 8056444048698 cm 31,3* h 10,7* 20,3 · cc 700 12 1/4" x h 4 1/4" x 8" · 23 3/4 oz. inner 4 master 12 Contenitore ovale Oval slanting bowl JP120350779 8056444048711 cm 35,8* h 13* 23,2 · cc 1380 14" x h 5" x 9 1/4" · 46 3/4 oz. inner 2 master 6 Contenitore ovale Oval slanting bowl JP120250779 8056444048674 cm 26* h 9,4* 17,5 · cc 450 10 1/4" x h 3 3/4" x 7" · 15 1/4 oz. inner 4 master 16 Cucchiaio Spoon JP1CUA10779 8056444410747 cm 13,4* 4 5 1/4" x 1 4/7" inner 24 master 288 Contenitore ovale Oval slanting bowl JP120300775 8056444398816 cm 31,3* h 10,7* 20,3 · cc 700 12 1/4" x h 4 1/4" x 8" · 23 3/4 oz. inner 4 master 12 Contenitore ovale Oval slanting bowl JP120350775 8056444398823 cm 35,8* h 13* 23,2 · cc 1380 14" x h 5" x 9 1/4" · 46 3/4 oz. inner 2 master 6 Contenitore ovale Oval slanting bowl JP120250775 8056444398809 cm 26* h 9,4* 17,5 · cc 450 10 1/4" x h 3 3/4" x 7" · 15 1/4 oz. inner 4 master 16 Cucchiaio Spoon JP1CUA10775 8056444410747 cm 13,4* 4 5 1/4" x 1 4/7" inner 24 master 288 0779 · Nero-Black 0767 · New Brown 0775 · Blu-Blue jap Black Blue New Brown NEW 2024 NEW 2024 NEW 2024 NEW 2024













60 61 NEW 2024 NEW 2024 Set 2 chopstick Set 2 chopstick S09BTS10NER 8056444170450 cm 24,5 9 3/4" inner 20 master 500 Set 2 chopstick Set 2 chopstick S09BTS20NER 8056444170474 cm 22 8 3/4" inner 20 master 500 Chopstick rest Chopstick rest S09BTS30NER 8056444170498 cm 5 * 3,4 2" x 1 1/4" inner 20 master 600 Vassoio rettangolare Rectangular tray JP134280767 8056444464887 cm 29,5* h 2* 12,5 11 1/2" x h 3/4" x 5" inner 6 master 36 Vassoio rettangolare Rectangular tray JP134370767 8056444464917 cm 38,5* h 3* 15,5 15 1/4" x h 1 1/4" x 6" inner 6 master 24 Vassoio rettangolare Rectangular tray JP134370779 8056444048650 cm 38,5* h 3* 15,5 15 1/4" x h 1 1/4" x 6" inner 6 master 24 Vassoio rettangolare Rectangular tray JP134370775 8056444398847 cm 38,5* h 3* 15,5 15 1/4" x h 1 1/4" x 6" inner 6 master 24 Vassoio rettangolare Rectangular tray JP134280779 8056444048636 cm 29,5* h 2* 12,5 11 1/2" x h 3/4" x 5" inner 6 master 36 Vassoio rettangolare Rectangular tray JP134280775 8056444398830 cm 29,5* h 2* 12,5 11 1/2" x h 3/4" x 5" inner 6 master 36 0779 · Nero-Black 0767 · New Brown 0775 · Blu-Blue jap Black Blue New Brown
Poke bowl/Insalatiera Sapa Sapa poke bowl/Salad bowl P4024205676 8056444151138
P4020235675 8056444151206
23 *15,5
1/4" × 6"
Sapa Sapa oval plate



















6 master 24
Ovale piano Sapa Sapa oval plate
1/2"
4 master 16
Coppetta Barcellona Barcellona small bowl






P403421M093 8056444150827
21 * 11,5
Vassoio rettangolare Delhi Delhi rectangular tray


62 63
* * * Ciotola foglia piccola Bowl leaf RE1PI163308 8056444151930 cm 20 * 12 7 3/4" x h 4" inner 6 master 24 Piatto foglia Plate leaf RE1PI173308 8056444151978 cm 26,5* 7* h 3,5 10 1/2" x h 2 3/4"x 1 1/2" inner 6 master 24
foglia grande Bowl leaf RE1PI183308 8056444152012 cm 26 * 14 10 1/2 x h 5 1/2 inner 6 master 18 Piatto foglia Plate leaf RE1PI193308 8056444152050 cm 34 * 18 13 1/2" x h 7"x 1 1/2" inner 6 master 18
Pyramidal oil cruet DE5OLA4TRAS 8056444328264 cm 7 * h 15 · cc 130 2 3/4" x h 6" · 4,5 oz. inner 6 master 24
Pyramidal oil cruet RE16812326A 8056444328462 cm 12 4 3/4" inner 6 master 36
piramidale Pyramidal oil cruet DE5OLA5TRAS 8056444328295 cm 8 * h 21 · cc 280 3 1/4" x h 8 1/4" · 9,5 oz. inner 6 master 24
bolo Pyramidal oil cruet RE16815326A 8056444328493 cm 15 6" inner 6 master 24
Sapa Sapa small bowl P4004125675 8056444151091 cm 12 4 3/4" inner 6 master 36
bowl/Insalatiera Sapa Sapa poke bowl/Salad bowl P4024205677 8056444151169 cm 20 7 3/4" inner 3 master 12 Ovale
* Confezione minima 6 pezzi 3 design assortiti Min quantity 6 pcs 3 designs mix and match
Ciotola
Oliera piramidale
Coppetta bolo
Oliera
Coppetta
Coppetta
Poke
piano
inner
cm
9
11"×7
inner
P4020285675 8056444151244 cm 28 * 19
cm
8
1/4"x 4 1/2" inner 6 master 36
cm
20 7 3/4" inner 3 master 12
4
P400411M094 8056444150865 cm 12
3/4" inner 6 master 36
nuova forma dalle linee pulite e dal gusto retrò. Un prodotto che esteticamente incanta, realizzato in porcellana super resistente.







with a unique mat rusty glaze and round plain shapes Terracotta is made by a super strong brown porcelain






64 65 5780 · Brown biscuit 5780 · Brown biscuit 5781 · Blue storm 5781 · Blue storm Piatto dessert Piatto dessert TC002215780 8056444284799 cm 21* h 3 8 1/4" x 1 1/4" inner 6 master 24 Piatto pane Bread plate TC003165781 8056444284850 cm 16* h 3 6 1/4" x h 1 1/4" inner 6 master 36 Piatto pane Bread plate TC003165780 8056444284843 cm 16* h 3 6 1/4" x h 1 1/4" inner 6 master 36 Rotondo piano Charger Plate TC022315781 8056444285000 cm 31* h 2,1 12 1/4" x 3/4" inner 3 master 12 Rotondo piano Charger Plate TC022315780 8056444284997 cm 31* h 2,1 12 1/4" x 3/4" inner 3 master 12 Piatto piano Dinner plate TC000285781 8056444284751 cm 28* h 3 11" x h 1 1/4" inner 3 master 12 Piatto piano Dinner plate TC000285780 8056444284744 cm 28* h 3 11" x h 1 1/4" inner 3 master 12 Piatto dessert Piatto dessert TC002215781 8056444284805 cm 21* h 3 8 1/4" x 1 1/4" inner 6 master 24
terracotta















66 67 Piatto fondo Soup plate TC001205781 8056444284782 cm 20* h 5 7 3/4" x 2" inner 6 master 18 Piatto fondo Soup plate TC001205780 8056444284775 cm 20* h 5 7 3/4" x 2" inner 6 master 18 Piatto cous cous Cous cous plate TC001255781 8056444284836 cm 25* h 5 9 3/4" x h 2" inner 3 master 18 Piatto cous cous Cous cous plate TC001255780 8056444284829 cm 25* h 5 9 3/4" x h 2" inner 3 master 18 Ovale Oval plate TC020245781 8056444284881 cm 24* h 3* 14 9 1/2" x 1 1/4" x 5 1/2" inner 6 master 24 Ovale Oval plate TC020245780 8056444284874 cm 24* h 3* 14 9 1/2" x 1 1/4" x 5 1/2" inner 6 master 24 Ovale Oval plate TC020335781 8056444284911 cm 33* h 3,5* 18 13" x h 1 1/2" x 7" inner 3 master 12 Ovale Oval plate TC020335780 8056444284904 cm 33* h 3,5* 18 13" x h 1 1/2" x 7" inner 3 master 12 5780 · Brown biscuit 5780 · Brown biscuit 5781 · Blue storm 5781 · Blue storm terracotta

















68 69 Tazza brodo Soup bowl TC018155781 8056444284942 cm 18* h 6,5* 15 · cc 660 9 1/4" x 2" · 22 1/4 oz. inner 4 master 24 Tazza brodo Soup bowl TC018155780 8056444284935 cm 18* h 6,5* 15 · cc 660 9 1/4" x 2" · 22 1/4 oz. inner 4 master 24 Ramequin Ramequin TC042155781 8056444284973 cm 14* h 3,5 · cc 320 5 1/2" x h 1 1/2" · 10 3/4 oz. inner 4 master 24 Ramequin Ramequin TC042155780 8056444284966 cm 14* h 3,5 · cc 320 5 1/2" x h 1 1/2" · 10 3/4 oz. inner 4 master 24 Insalatiera Salad bowl TC024235781 8056444285062 cm 23,5* h 7 · cc 1300 9 1/4" x 2" · 44 oz. inner 6 master 72 Insalatiera Salad bowl TC024235780 8056444285055 cm 23,5* h 7 · cc 1300 9 1/4" x 2" · 44 oz. inner 6 master 72 Coppetta Bowl TC004095781 8056444285031 cm 9* h 5 · cc 170 3 1/2" x h 2" · 5 3/4 oz. inner 3 master 12 Coppetta Bowl TC004095780 8056444285024 cm 9* h 5 · cc 170 3 1/2" x h 2" · 5 3/4 oz. inner 3 master 12 5780 · Brown biscuit 5780 · Brown biscuit 5781 · Blue storm 5781 · Blue storm terracotta
vulcania black








l'unica porcellana nera in pasta con finitura materica simile alla pietra lavica. Ideale nella ristorazione gourmet e casual tipo BBQ

the only black paste porcelain, with a material finish similar to lava stone. Ideal for gourmet and casual BBQ type restaurants






70 71 Piatto fondo gourmet Deep gourmet plate VU023270779 8000257823201 cm 27* h 5,5* 27 · cc 280 10 3/4" x h 2 1/4" x 10 3/4" · 9 1/2 oz. inner 6 master 12 Pasta bowl Pasta bowl VU023250779 8000257806952 cm 25,5* h 4,7* 25,5 · cc 300 10" x h 1 3/4" x 10" · 10 1/4 oz. inner 6 master 18 Pasta bowl Pasta bowl VU023290779 8000257806969 cm 28,5* h 4,7* 28,5 · cc 450 11 1/4" x h 1 3/4" x 11 1/4" · 15 1/4 oz. inner 6 master 12 Piatto fondo gourmet Deep gourmet plate VU001100779 8000257308784 cm 10* h 2,8* 10 · cc 15 4" x h 1" x 4" · 1/2 oz. inner 12 master 120 Piatto fondo gourmet Deep gourmet plate VU001150779 8000257308609 cm 15* h 3,8* 15 · cc 50 6" x h 1 1/2" x 6" · 1 3/4 oz. inner 6 master 60 Piatto fondo gourmet Deep gourmet plate VU001240779 8000257308128 cm 24* h 5,5* 24 · cc 200 9 1/2" x h 2 1/4" x 9 1/2" · 6 3/4 oz. inner 6 master 18 Insalatiera Salad bowl VU024200779 8000257806976 cm 20,5* h 6,5* 20,5 · cc 1250 8" x h 2 1/2" x 8" · 42 1/4 oz. inner 6 master 18 Rotondo piano Charger plate VU022330779 8000257806945 cm 32,2* h 1,5* 32,2 12 3/4" x h 1/2" x 12 3/4" inner 6 master 12 Piatto piano Dinner plate VU000260779 8000257806907 cm 25,7* h 2* 25,7 · cc 380 10" x h 3/4" x 10" · 12 3/4 oz. inner 6 master 12 Piatto dessert Dessert plate VU002210779 8000257806921 cm 21* h 2* 21 8 1/4" x h 3/4" x 8 1/4" inner 6 master 24 Piatto burro Butter plate VU003100779 8000257309514 cm 10* h 1,8* 10 4" x h 3/4" x 4" inner 12 master 144 Piatto pane Bread plate VU003160779 8000257806730 cm 16* h 2* 16 6 1/4" x h 3/4" x 6 1/4" inner 6 master 60 Cocotte rotonda Round cocotte VU0271H0779 8000257309545 cm 14* h 11* 17,5 · cc 580 5 1/2" x h 4 1/4" x 7" · 19 1/2 oz. inner 6 master 12 Piatto piano Dinner plate VU000290779 8000257806914 cm 28,7* h 2,5* 28,7 11 1/4" x h 1" x 11 1/4" inner 6 master 12













72 73 * * Solo vassoio in legno compatibile con MO104100779 Fitting with MO104100779 Piatto rettangolare Rectangular plate VU034200779 8000257309569 cm 20* h 0,7* 15 7 3/4" x h 1/4" x 6" inner 6 master 36 Piatto rettangolare Rectangular plate VU034260779 8000257806983 cm 26,5* h 0,8* 13 10 1/2" x h 1/4" x 5" inner 6 master 24 Piatto rettangolare Rectangular plate VU034290779 8000257806990 cm 29,5* h 0,8* 14,5 11 1/2" x h 1/4" x 5 3/4" inner 6 master 24 Piatto rettangolare Rectangular steak plate VU034330779 8000257807003 cm 33,5* h 0,8* 20,5 13 1/4" x h 1/4" x 8" inner 2 master 12 Coppetta Fruit bowl VU004090779 8000257806938 cm 9* h 5* 9 · cc 170 3 1/2" x h 2" x 3 1/2" · 5 3/4 oz. inner 6 master 72 Vassoietto 3 scomparti 3-sector wooden tray MO83432LEGN 8056444124835 cm 32* h 1,2* 10,8 12 1/2" x h 1/2" x 4 1/4" inner 6 master 48 Piatto bistecca rettangolare Rectangular steak plate VU034340779 8000257807010 cm 32,8* h 1,5* 23,5 13" x h 1/2" x 9 1/4" inner 2 master 12 Piatto bistecca ovale Oval steak plate VU034370779 8000257809397 cm 37,5* h 1,5* 25 14 3/4" x h 1/2" x 9 3/4" inner 2 master 12 Piatto bistecca rettangolare Rectangular steak plate VU034420779 8000257308098 cm 42* h 1,5* 28 16 1/2" x h 1/2" x 11" inner 1 master 6
vulcania black
















74 75 Bicchiere Tumbler VU057160779 8056444023053 cm 8* h 8* 8 · cc 170 3 1/4" x h 3 1/4" x 3 1/4" · 5 3/4 oz. inner 12 master 36 Piattino moka Moca saucer VU005120779 8056444023114 cm 12* h 2* 12 4 3/4" x h 3/4" x 4 3/4" inner 12 master 36 Piattino macchiato/cappuccino Macchiato/cappuccino saucer VU006160779 8056444023138 cm 16* h 2,5* 16 6 1/4" x h 1" x 6 1/4" inner 6 master 24 Tazzina moka Moca small cup VU015060779 8056444023039 cm 6* h 6,3* 8,2 · cc 70 2 1/4" x h 2 1/2" x 3 1/4" · 2 1/4 oz. inner 12 master 36 Tazza macchiato Macchiato cup VU016200779 8056444023077 cm 9* h 7,7* 11,5 · cc 200 3 1/2" x h 3" x 4 1/2" · 6 3/4 oz. inner 6 master 24 Tegame 2 manici Double handled pan VU045120779 8000257306780 cm 12* h 3,5* 15,5 · cc 210 4 3/4" x h 1 1/2" x 6" · 7 oz. inner 12 master 72 Tegame 2 manici Double handled pan VU045240779 8000257807072 cm 23* h 5* 28,5 · cc 1120 9" x h 2" x 11 1/4" · 37 3/4 oz. inner 6 master 12 Ovale forno 2 manici Oval baking dish VU042210779 8000257807300 cm 20,5* h 3* 11,7 · cc 230 8" x h 1 1/4" x 4 1/2" · 7 3/4 oz. inner 6 master 48 Ovale forno 2 manici Oval baking dish VU042230779 8000257807034 cm 23,5* h 3,5* 12,7 · cc 310 9 1/4" x h 1 1/2" x 5" · 10 1/2 oz. inner 6 master 36 Ovale forno 2 manici Oval baking dish VU042280779 8000257807041 cm 28,5* h 3,7* 16 · cc 560 11 1/4" x h 1 1/2" x 6 1/4" · 19 oz. inner 6 master 24 Tazza cappuccino Cappuccino cup VU016280779 8056444023091 cm 10* h 9,5* 13 · cc 300 4" x h 3 3/4" x 5" · 10 1/4 oz. inner 6 master 24 Tegame 2 manici Double handled pan VU045140779 8000257807058 cm 15* h 2,7* 18,5 · cc 290 6" x h 1" x 7 1/4" · 9 3/4 oz. inner 6 master 48 Tegame 2 manici Double handled pan VU045180779 8000257807065 cm d: 17,5* h 3,3* 21,7 · cc 425 d:7" x h 1 1/4" x 8 1/2" · 14 1/4 oz. inner 6 master 36 vulcania
black
vulcania salento







porcellana in pasta colore sabbia, forme irregolari e texture legno. Una collezione ideale per ristoranti gourmet e casual in stile naturale sand









clay porcelain, irregular shapes and wood texture. An ideal collection for gourmet and casual restaurants in a natural style

76 77 Rotondo piano Charger plate VU022295542 8056444008135 cm 29* h 3* 29 11 1/2" x h 1 1/4" x 11 1/2" inner 3 master 12 Rotondo piano Charger plate VU022335542 8056444062359 cm 32,2* h 1,5* 32,2 12 3/4" x h 1/2" x 12 3/4" inner 6 master 12 Pasta bowl Pasta bowl VU023265542 8056444007954 cm 25* h 7,5* 25 · cc 400 9 3/4" x h 3" x 9 3/4" · 13 1/2 oz. inner 3 master 18 Large pasta bowl Large pasta bowl VU023285542 8056444007978 cm 27,5* h 8* 27,5 · cc 1000 10 3/4" x h 3 1/4" x 10 3/4" · 33 3/4 oz. inner 3 master 12 Piatto dessert Dessert plate VU002215542 8056444059922 cm 21* h 2* 21 8 1/4" x h 3/4" x 8 1/4" inner 6 master 36 Coppetta Small cup VU004085542 8056444008159 cm 8* h 2,5* 8 · cc 120 3 1/4" x h 1" x 3 1/4" · 4 oz. inner 12 master 192 Piatto rettangolare Rectangular plate VU034155542 8056444008050 cm 16* h 1,5* 10 6 1/4" x h 1/2" x 4" inner 6 master 60 Piatto rettangolare Rectangular plate VU034235542 8056444008036 cm 23,5* h 2* 15,5 9 1/4" x h 3/4" x 6" inner 4 master 24 Piatto rettangolare Rectangular plate VU034285542 8056444008012 cm 29* h 2* 20 11 1/2" x h 3/4" x 7 3/4" inner 3 master 18 Piatto rettangolare Rectangular plate VU034325542 8056444007992 cm 32,5* h 2* 23 12 3/4" x h 3/4" x 9" inner 3 master 12 Piatto quadrato Square plate VU000165542 8056444008098 cm 16* h 2* 16 6 1/4" x h 3/4" x 6 1/4" inner 6 master 36 Piatto quadrato Square plate VU000255542 8056444008074 cm 25* h 2* 25 9 3/4" x h 3/4" x 9 3/4" inner 3 master 12 Baker Baker VU003205542 8056444008111 cm 16* h 4* 20 6 1/4" x h 1 1/2" x 7 3/4" inner 3 master 18
colour
VU034315575
Piatto



















78 79
Rectangular plate
8056444051483 cm 30* h 1* 15 11 3/4" x h 1/2" x 6" inner 4 master 24
rettangolare Rectangular plate
Piatto rettangolare
VU034315576
Piatto
8056444051476 cm 30* h 1* 15 11 3/4" x h 1/2" x 6" inner 4 master 24
rettangolare Rectangular plate
8056444051469 cm 30* h 1* 15 11 3/4" x h 1/2" x 6" inner 4 master 24
piccolo Small 2 handled pan
8056444051407 cm 15* h 3* 18,7 · cc 270 6" x h 1 1/4" x 7 1/4" · 9 1/4 oz. inner 6 master 48
2 handled pan VU045175576 8056444051445 cm d: 17,5* h 3,5* 21,7 · cc 400 d:7" x h 1 1/2" x 8 1/2" · 13 1/2 oz. inner 6 master 36
manici piccolo Small 2 handled pan VU045155575 8056444051391 cm 15* h 3* 18,7 · cc 270 6" x h 1 1/4" x 7 1/4" · 9 1/4 oz. inner 6 master 48 Tegame 2 manici grande 2 handled pan VU045175575 8056444051438 cm d: 17,5* h 3,5* 21,7 · cc 400 d:7" x h 1 1/2" x 8 1/2" · 13 1/2 oz. inner 6 master 36 Tegame 2 manici piccolo Small 2 handled pan VU045155574 8056444051384 cm 15* h 3* 18,7 · cc 270 6" x h 1 1/4" x 7 1/4" · 9 1/4 oz. inner 6 master 48 Tegame 2 manici grande 2 handled pan VU045175574 8056444051421 cm d: 17,5* h 3,5* 21,7 · cc 400 d:7" x h 1 1/2" x 8 1/2" · 13 1/2 oz. inner 6 master 36 Piatto rettangolare Rectangular plate VU034305576 8056444051520 cm 30* h 1,7* 10 11 3/4" x h 3/4" x 4" inner 4 master 24 Piatto rettangolare Rectangular plate VU034305575 8056444051513 cm 30* h 1,7* 10 11 3/4" x h 3/4" x 4" inner 4 master 24 Piatto rettangolare Rectangular plate VU034305574 8056444051506 cm 30* h 1,7* 10 11 3/4" x h 3/4" x 4" inner 4 master 24 5576 · Green-Verde 5576 · Green-Verde 5575 · Yellow-Giallo 5575 · Yellow-Giallo 5574 · Orange-Arancio 5574 · Orange-Arancio vulcania veggie
VU034315574
Tegame 2 manici
VU045155576
Tegame 2 manici grande
Tegame 2













80 81 Tumbler alto Hight tumbler VU004225576 8056444284546 cm 8* h 7,5* · cc 200 3 1/4" x h 3" · 6 3/4 oz. inner 6 master 72 Tumbler basso Small tumbler VU004155575 8056444284591 cm 8* h 5* · cc 150 3 1/4" x h 2" · 5 oz. inner 6 master 72 Tumbler alto Hight tumbler VU004225575 8056444284560 cm 8* h 7,5* · cc 200 3 1/4" x h 3" · 6 3/4 oz. inner 6 master 72 Tumbler alto Hight tumbler VU004225574 8056444284553 cm 8* h 7,5* · cc 200 3 1/4" x h 3" · 6 3/4 oz. inner 6 master 72 Tumbler basso Small tumbler VU004155574 8056444284584 cm 8* h 5* · cc 150 3 1/4" x h 2" · 5 oz. inner 6 master 72 Tumbler basso Small tumbler VU004155576 8056444284607 cm 8* h 5* · cc 150 3 1/4" x h 2" · 5 oz. inner 6 master 72
vulcania veggie

















82 83 Coppetta piccola Small cup VU004065576 8056444051247 cm 6* h 3* 6 · cc 40 2 1/4" x h 1 1/4" x 2 1/4" · 1 1/4 oz. inner 12 master 120 Coppetta bassa Low cup VU004075576 8056444051322 cm 8* h 2,5* 8 · cc 65 3 1/4" x h 1" x 3 1/4" · 2 1/4 oz. inner 12 master 120 Coppetta piccola Small cup VU004065575 8056444051230 cm 6* h 3* 6 · cc 40 2 1/4" x h 1 1/4" x 2 1/4" · 1 1/4 oz. inner 12 master 120 Coppetta bassa Low cup VU004075575 8056444051315 cm 8* h 2,5* 8 · cc 65 3 1/4" x h 1" x 3 1/4" · 2 1/4 oz. inner 12 master 120 Coppetta piccola Small cup VU004065574 8056444051223 cm 6* h 3* 6 · cc 40 2 1/4" x h 1 1/4" x 2 1/4" · 1 1/4 oz. inner 12 master 120 Coppetta bassa Low cup VU004075574 8056444051308 cm 8* h 2,5* 8 · cc 65 3 1/4" x h 1" x 3 1/4" · 2 1/4 oz. inner 12 master 120 Coppetta alta High cup VU004115576 8056444051360 cm 8* h 4* 8 · cc 100 3 1/4" x h 1 1/2" x 3 1/4" · 3 1/2 oz. inner 12 master 120 Ramequin costolato Ramequin VU004135576 8056444051285 cm 9* h 5* 9 · cc 140 3 1/2" x h 2" x 3 1/2" · 4 3/4 oz. inner 6 master 72 Coppetta alta High cup VU004115575 8056444051353 cm 8* h 4* 8 · cc 100 3 1/4" x h 1 1/2" x 3 1/4" · 3 1/2 oz. inner 12 master 120 Ramequin costolato Ramequin VU004135575 8056444051278 cm 9* h 5* 9 · cc 140 3 1/2" x h 2" x 3 1/2" · 4 3/4 oz. inner 6 master 72 Coppetta alta High cup VU004115574 8056444051346 cm 8* h 4* 8 · cc 100 3 1/4" x h 1 1/2" x 3 1/4" · 3 1/2 oz. inner 12 master 120 Ramequin costolato Ramequin VU004135574 8056444051261 cm 9* h 5* 9 · cc 140 3 1/2" x h 2" x 3 1/2" · 4 3/4 oz. inner 6 master 72 5576 · Green-Verde 5576 · Green-Verde 5575 · Yellow-Giallo 5575 · Yellow-Giallo 5574 · Orange-Arancio 5574 · Orange-Arancio vulcania veggie
Ciotola Bowl VU004145576 8056444134759

14,5* h 7* 14,5 · cc 660 5 3/4" x h 2 3/4" x 5 3/4" · 22 1/4 oz.
Ciotola Bowl VU004145575 8056444134742










14,5* h 7* 14,5 · cc 660 5 3/4" x h 2 3/4" x 5 3/4" · 22 1/4 oz.
14,5* h 7* 14,5 · cc 660
3/4" x h 2 3/4" x 5 3/4" · 22 1/4 oz.
6 master 24
6 master 24
6 master 24
12* h 10* 12 · cc 750 4 3/4" x h 4" x 4 3/4" · 25 1/4 oz.


24
24




84 85
inner
cm
inner
cm
cm
inner
Vaso
inner
inner
inner 4
24
Taco
8056444134711 cm 16,5*
6 1/2"
1/2 oz. inner 6
Taco
VU020165575 8056444134704 cm 16,5*
6*
280 6 1/2"
1/4"
4 1/4" · 9 1/2 oz. inner 6 master 36 Piatto taco Taco plate VU020165574 8056444134698 cm 16,5* h 6* 11 · cc 280 6 1/2" x h 2 1/4" x 4 1/4" · 9 1/2 oz. inner 6 master 36 Piatto ovale Oval plate VU020215574 8056444134599 cm 21,5* h 4* 12 cc · 240 8 1/2" x h 1 1/2" x 4 3/4" · 8 oz. inner 6 master 36 Piatto ovale Oval plate VU020215575 8056444134605 cm 21,5* h 4* 12 cc · 240 8 1/2" x h 1 1/2" x 4 3/4" · 8 oz. inner 6 master 36 Piatto ovale Oval plate VU020215576 8056444134612 cm 21,5* h 4* 12 · cc 240 8 1/2" x h 1 1/2" x 4 3/4" · 8 oz. inner 6 master 36 5576 · Green-Verde 5576 · Green-Verde 5575 · Yellow-Giallo 5575 · Yellow-Giallo 5574 · Orange-Arancio 5574 · Orange-Arancio vulcania
Ciotola Bowl VU004145574 8056444134735
5
Vase VU068125576 8056444134575 cm
4 master
Vaso Vase VU068125575 8056444134568 cm 12* h 10* 12 · cc 750 4 3/4" x h 4" x 4 3/4" · 25 1/4 oz.
4 master
Vaso Vase VU068125574 8056444134551 cm 12* h 10* 12 · cc 750 4 3/4" x h 4" x 4 3/4" · 25 1/4 oz.
master
Piatto taco
plate VU020165576
h 6* 11 · cc 280
x h 2 1/4" x 4 1/4" · 9
master 36 Piatto taco
plate
h
11 · cc
x h 2
x
veggie











88 Piatto edge Edge plate MX001183130 8056444237184 cm 18 * h 2,5 7" x h 7" inner 6 master 24 Piatto edge Edge plate MX001243130 8056444237221 cm 25 * h 3,5 9,75" x h 9 3/4" inner 6 master 24 Piatto edge Edge plate MX001223130 8056444237269 cm 22 * h 3 8,75" x h 8 3/4" inner 6 master 12 Piatto edge Edge plate RW001183245 8056444176957 cm 18 * h 2,5 7" x h 7 inner 6 master 24 Piatto edge Edge plate RW001223245 8056444176995 cm 22 * h 3 8,75" x h 8 3/4" inner 6 master 18 Piatto edge Edge plate RW001243245 8056444175158 cm 25 * h 3,5 9,75" x h 9 3/4" inner 3 master 12 Insalatiera Salad bowl MX024203130 8056444125498 cm 20* h 8,2* 20 · cc 1000 7 3/4" x h 3 1/4" x 7 3/4" · 33 3/4 oz. inner 6 master 24 Insalatiera Salad bowl MX024253130 8056444125535 cm 25,3* h 9* 25,3 · cc 1820 10" x h 3 1/2" x 10" · 61 1/2 oz. inner 3 master 12 Insalatiera Salad bowl MX024233130 8056444237061 cm 23,5* h 7* 23,5 · cc 1180 9 1/4" x h 2 3/4" x 9 1/4" · 40 oz. inner 4 master 12 Insalatiera Salad bowl RW024253245 8056444237528 cm 25,3* h 9* 25,3 · cc 1820 10" x h 3 1/2" x 10" · 61 1/2 oz. inner 3 master 12 Insalatiera Salad bowl RW024233245 8056444085754 cm 23,5* h 7* 23,5 · cc 1180 9 1/4" x h 2 3/4" x 9 1/4" · 40 oz. inner 4 master 12 Insalatiera Salad bowl RW024203245 8056444237443 cm 20* h 8,2* 20 · cc 1000 7 3/4" x h 3 1/4" x 7 3/4" · 33 3/4 oz. inner 6 master 12 Coppetta gourmet Gourmet bowl MX004103130 8056444237146 inner 6 master 36 cm 9,2* h 9* 9,2 · cc 140 3 1/2" x h 3 1/2" x 3 1/2" · 4 3/4 oz. Coppetta gourmet Gourmet cup RW004103245 8056444085792 cm 9,2* h 9* 9,2 · cc 140 3 1/2" x h 3 1/2" x 3 1/2" · 4 3/4 oz. inner 6 master 36 3130 · Moonlight 3245 · Rust moonlight
& rust













90 91 Bolo Bowl MX068183130 8056444125511 cm 17,6* h 7,8* 17,6 · cc 700 7" x h 3" x 7" · 23 3/4 oz. inner 6 master 24 Ovale piano Oval tray MX020253130 8056444237306 cm 25 9,75" inner 6 master 12 Piatto pane Bread plate MX003163130 8056444237344 cm 16 6 1/4" inner 6 master 24 Coppetta olio Oil cup MX004083130 8056444125573 cm 7,20* h 4* 7,20 · cc 80 2 3/4" x h 1 1/2" x 2 3/4" · 2 3/4 oz. inner 12 master 144 Ovale piano Oval tray RW020253245 8056444237566 inner 6 master 12 cm 25 9,75" Piatto pane Bread plate RW003163245 8056444237603 inner 6 master 24 cm 16 6 1/4" Bolo Bowl RW068183245 8056444237481 cm 17,6* h 7,8* 17,6 · cc 700 7" x h 3" x 7" · 23 3/4 oz. inner 6 master 24 Coppetta olio Oil cup RW004083245 8056444085778 cm 7,2* h 4* 7,2 · cc 80 2 3/4" x h 1 1/2" x 2 3/4" · 2 3/4 oz. inner 12 master 144 3130 · Moonlight 3130 · Moonlight 3245 · Rust 3245 · Rust moonlight & rust
organica material bronze & green
forme organiche e irregolari in colore bronzo ossidato e verde acqua materico per queste collezioni in porcellana







organic and irregular shapes in materic oxidized bronze colour and in tactile teal for these porcelain collections






92 5578 · Green-Verde 5577 · Bronze-Bronzo Piatto piano Dinner plate OC000285577 8056444052145 cm 28* h 3* 28 11" x h 1 1/4" x 11" inner 4 master 16 Piatto piano Dinner plate OC000285578 8056444052152 cm 28* h 3* 28 11" x h 1 1/4" x 11" inner 4 master 16 Piatto piano Dinner plate OC000245577 8056444052176 cm 23,5* h 3* 23,5 9 1/4" x h 1 1/4" x 9 1/4" inner 6 master 12 Piatto piano Dinner plate OC000245578 8056444052183 cm 23,5* h 3* 23,5 9 1/4" x h 1 1/4" x 9 1/4" inner 6 master 12 Gourmet plate piccolo Small gourmet plate OC001185577 8056444052268 cm 18* h 3* 18 · cc 160 7" x h 1 1/4" x 7" · 5 1/2 oz. inner 6 master 36 Gourmet plate piccolo Small gourmet plate OC001185578 8056444052275 cm 18* h 3* 18 · cc 160 7" x h 1 1/4" x 7" · 5 1/2 oz. inner 6 master 36 Piatto dessert Dessert plate OC002185577 8056444052206 cm 17,7* h 3* 17,7 7" x h 1 1/4" x 7" inner 6 master 36 Piatto dessert Dessert plate OC002185578 8056444052213 cm 17,7* h 3* 17,7 7" x h 1 1/4" x 7" inner 6 master 36
material bronze & green













94 Coppetta Small bowl OC004125577 8056444052299 cm 12* h 5* 12 · cc 210 4 3/4" x h 2" x 4 3/4" · 7 oz. inner 6 master 48 Coppetta Small bowl OC004125578 8056444052305 cm 12* h 5* 12 · cc 210 4 3/4" x h 2" x 4 3/4" · 7 oz. inner 6 master 48 Piatto fondo basso Low deep plate OC001245577 8056444052237 cm 25* h 5* 25 · cc 980 9 3/4" x h 2" x 9 3/4" · 33 1/4 oz. inner 2 master 24 Piatto fondo basso Low deep plate OC001245578 8056444052244 cm 25* h 5* 25 · cc 980 9 3/4" x h 2" x 9 3/4" · 33 1/4 oz. inner 2 master 24 Piatto fondo alto High deep plate OC001255577 8056444052350 cm 24* h 7* 24 · cc 1180 9 1/2" x h 2 3/4" x 9 1/2" · 40 oz. inner 2 master 24 Piatto fondo alto High deep plate OC001255578 8056444052367 cm 24* h 7* 24 · cc 1180 9 1/2" x h 2 3/4" x 9 1/2" · 40 oz. inner 2 master 24 Piatto bistecca Steak plate OC034335577 8056444052329 cm 34* h 3* 25 13 1/2" x h 1 1/4" x 9 3/4" inner 3 master 12 Piatto bistecca Steak plate OC034335578 8056444052336 cm 34* h 3* 25 13 1/2" x h 1 1/4" x 9 3/4" inner 3 master 12 5578 · Green-Verde 5577 · Bronze-Bronzo organica
trend split








forma di articoli in porcellana con colorazione reagente turchese mare, la peppatura e il bordo ruggine le danno un look informale e vintage

a shape of porcelain articles with sea turquoise reagent coloring, the peppatura and the rust edge give them an informal and vintage look









96 97 Piatto piano Dinner plate TA000293277 8056444022384 cm 29* h 3,3* 29 11 1/2" x h 1 1/4" x 11 1/2" inner 6 master 12 Piatto fondo gourmet Deep gourmet plate TA001273277 8000257914275 cm 27,5* h 7* 27,5 · cc 410 10 3/4" x h 2 3/4" x 10 3/4" · 13 3/4 oz. inner 3 master 12 Ovale piano Oval plate TA020303277 8000257914343 cm 30,3* h 2* 21 12" x h 3/4" x 8 1/4" inner 3 master 12 Ovale piano Oval plate TA020353277 8000257914213 cm 35* h 2,3* 24,6 13 3/4" x h 1" x 9 3/4" inner 3 master 12 Ovale piano Oval plate TA020203277 8000257914312 cm 19,8* h 1,5* 17,8 7 3/4" x h 1/2" x 7" inner 6 master 36 Insalatiera Salad bowl TA024223277 8000257914244 cm 22* h 7,5* 22 · cc 1150 8 3/4" x h 3" x 8 3/4" · 39 oz. inner 4 master 12 Piattino ovale Oval saucer TA003133277 8000257970288 cm 12* h 1,5* 10 4 3/4" x h 1/2" x 4" inner 6 master 72 Coppetta quadra Square bowl TA004073277 8000257972886 cm 7* h 3,5* 7 · cc 70 2 3/4" x h 1 1/2" x 2 3/4" · 2 1/4 oz. inner 6 master 108 Coppetta ovale Oval bowl TA004103277 8000257969688 cm 10* h 5* 7 · cc 100 4" x h 2" x 2 3/4" · 3 1/2 oz. inner 12 master 108 Piattino rettangolare Rectangular saucer TA003123277 8000257970233 cm 12* h 1,5* 8,5 4 3/4" x h 1/2" x 3 1/4" inner 12 master 96
una collezione completa di articoli in porcellana stile rustico dipinto a mano in quattro colori moderno e casual, ogni articolo diverso dall'altro come si addice ad un prodotto artigianale ed unico


a complete collection of rustic-style porcelain items hand-painted in four colours in a modern and casual style, each item different from the other as it is an artisanal and unique product



















98 3264 · Grey-Grigio4711 · Green-Verde 3265 · Light blue-Azzurro 3657 · Orange-Arancio Piatto dessert Dessert plate BI002213265 8056444047769 cm 20,2* h 2* 18,5 8" x h 3/4" x 7 1/4" inner 6 master 36 Piatto dessert Dessert plate BI002213264 8056444047752 cm 20,2* h 2* 18,5 8" x h 3/4" x 7 1/4" inner 6 master 36 Piatto dessert Dessert plate BI002214711 8056444107135 cm 20,2* h 2* 18,5 8" x h 3/4" x 7 1/4" inner 6 master 36 Piatto dessert Dessert plate BI002213657 8056444107012 cm 20,2* h 2* 18,5 8" x h 3/4" x 7 1/4" inner 6 master 36 Piattino drop Saucer BI003123264 8056444047905 cm 12,2* h 1,5* 10 5" x h 1/2" x 4" inner 6 master 72 Piattino drop Saucer BI003123265 8056444047912 cm 12,2* h 1,5* 10 5" x h 1/2" x 4" inner 6 master 72 Piattino drop Saucer BI003123265 8056444047912 cm 12,2* h 1,5* 10 5" x h 1/2" x 4" inner 6 master 72 Piattino drop Saucer BI003124711 8056444107142 cm 12,2* h 1,5* 10 4 3/4" x h 1/2" x 4" inner 6 master 72 Rotondo piano Charger plate BI022313264 8056444049398 cm 31* h 3* 28,5 12 1/4" x h 1 1/4" x 11 1/4" inner 4 master 12 Rotondo piano Charger plate BI022313265 8056444049404 cm 31* h 3* 28,5 12 1/4" x h 1 1/4" x 11 1/4" inner 4 master 12 Rotondo piano Charger plate BI022313657 8056444107074 cm 31* h 3* 28,5 12 1/4" x h 1 1/4" x 11 1/4" inner 4 master 12 Rotondo piano Charger plate BI022314711 8056444107197 cm 31* h 3* 28,5 12 1/4" x h 1 1/4" x 11 1/4" inner 4 master 12 Piatto piano Dinner plate BI000273264 8056444047783 cm 26,5* h 2,2* 25 10 1/2" x h 3/4" x 9 3/4" inner 6 master 24 Piatto piano Dinner plate BI000273265 8056444047790 cm 26,5* h 2,2* 25 10 1/2" x h 3/4" x 9 3/4" inner 6 master 24 Piatto piano Dinner plate BI000273657 8056444106978 cm 26,5* h 2,2* 25 10 1/2" x h 3/4" x 9 3/4" inner 6 master 24 Piatto piano Dinner plate BI000274711 8056444107098 cm 26,5* h 2,2* 25 10 1/2" x h 3/4" x 9 3/4" inner 6 master 24
b-rush























100 101 3264 · Grey-Grigio4711 · Green-Verde 3265 · Light blue-Azzurro 3657 · Orange-Arancio Piatto fondo gourmet Gourmet deep plate BI001273264 8056444047639 cm 27* h 6,5* 27 · cc 300 10 3/4" x h 2 1/2" x 10 3/4" · 10 1/4 oz. inner 2 master 8 Piatto fondo gourmet Gourmet deep plate BI001273265 8056444047646 cm 27* h 6,5* 27 · cc 300 10 3/4" x h 2 1/2" x 10 3/4" · 10 1/4 oz. inner 2 master 8 Piatto fondo gourmet Gourmet deep plate BI001274711 8056444107128 cm 27* h 6,5* 27 · cc 300 10 3/4" x h 2 1/2" x 10 3/4" · 10 1/4 oz. inner 2 master 8 Piatto fondo gourmet Gourmet deep plate BI001273657 8056444107005 cm 27* h 6,5* 27 · cc 300 10 3/4" x h 2 1/2" x 10 3/4" · 10 1/4 oz. inner 2 master 8 Piatto fondo coupe Coupe deep plate BI001213264 8056444047813 cm 21* h 4,5* 19,5 · cc 530 8 1/4" x h 1 3/4" x 7 3/4" · 18 oz. inner 4 master 24
fondo
Coupe deep plate BI001213265 8056444047820 cm 21* h 4,5* 19,5 · cc 530 8 1/4" x h 1 3/4" x 7 3/4" · 18 oz. inner 4 master 24
Coupe deep plate BI001213657 8056444106992 cm 21* h 4,5* 19,5 · cc 530 8 1/4" x h 1 3/4" x 7 3/4" · 18 oz. inner 4 master 24 Piatto fondo coupe Coupe deep plate BI001214711 8056444107111 cm 21* h 4,5* 19,5 · cc 530 8 1/4" x h 1 3/4" x 7 3/4" · 18 oz. inner 4 master 24 Ovale piano Oval plate BI020363265 8056444047738 cm 35,5* h 2,5* 25 14" x h 1" x 9 3/4" inner 4 master 16 Ovale piano Oval plate BI020363264 8056444047721 cm 35,5* h 2,5* 25 14" x h 1" x 9 3/4" inner 4 master 16 Ovale piano Oval plate BI020363657 8056444107067 cm 35,5* h 2,5* 25 14" x h 1" x 9 3/4" inner 4 master 16 Ovale piano Oval plate BI020364711 8056444107180 cm 35,5* h 2,5* 25 14" x h 1" x 9 3/4" inner 4 master 16 Ovale
Oval plate BI020313264 8056444047691 cm 30,5* h 2,2* 21 12" x h 3/4" x 8 1/4" inner 4 master 16 Ovale piano Oval plate BI020313265 8056444047707 cm 30,5* h 2,2* 21 12" x h 3/4" x 8 1/4" inner 4 master 16 Ovale
Oval plate BI020314711 8056444107173 cm 30,5* h 2,2* 21 12" x h 3/4" x 8 1/4" inner 4 master 16
Oval plate BI020313657 8056444107050 cm 30,5* h 2,2* 21 12" x h 3/4" x 8 1/4" inner 4 master 16
Piatto
coupe
Piatto fondo coupe
piano
piano
Ovale piano
3264 · Grey-Grigio4711 · Green-Verde 3265 · Light blue-Azzurro 3657 · Orange-Arancio
b-rush





















102 103 Ovale piano Oval plate BI020263264 8056444047660 cm 25,5* h 2* 17,7 10" x h 3/4" x 7" inner 6 master 24 Ovale piano Oval plate BI020263265 8056444047677 cm 25,5* h 2* 17,7 10" x h 3/4" x 7" inner 6 master 24 Ovale piano Oval plate BI020263657 8056444107043 cm 25,5* h 2* 17,7 10" x h 3/4" x 7" inner 6 master 24 Ovale piano Oval plate BI020264711 8056444107166 cm 25,5* h 2* 17,7 10" x h 3/4" x 7" inner 6 master 24 Insalatiera Salad bowl BI024233264 8056444047936 cm 22,5* h 8* 21,2 · cc 1200 8 3/4" x h 3 1/4" x 8 1/4" · 40 1/2 oz. inner 2 master 12 Insalatiera Salad bowl BI024233265 8056444047943 cm 22,5* h 8* 21,2 · cc 1200 8 3/4" x h 3 1/4" x 8 1/4" · 40 1/2 oz. inner 2 master 12 Insalatiera Salad bowl BI024234711 8056444107203 cm 22,5* h 8* 21,2 · cc 1200 8 3/4" x h 3 1/4" x 8 1/4" · 40 1/2 oz. inner 2 master 12 Insalatiera Salad bowl BI024233657 8056444107081 cm 22,5* h 8* 21,2 · cc 1200 8 3/4" x h 3 1/4" x 8 1/4" · 40 1/2 oz. inner 2 master 12 Bowl Bowl BI024203264 8056444218213 cm 20* h 7" 7 3/4" x h 3" inner 6 master 12 Bowl Bowl BI024203265 8056444218206 cm 20* h 7" 7 3/4" x h 3" inner 6 master 12 Bowl Bowl BI024203657 8056444218237 cm 20* h 7" 7 3/4" x h 3" inner 6 master 12 Bowl Bowl BI024204711 8056444218220 cm 20* h 7" 7 3/4" x h 3" inner 6 master 12 Bowl Bowl BI024173264 8056444218084 cm 17* h 6,50 6 3/4" x h 2 1/2" inner 6 master 18 Bowl Bowl BI024173265 8056444218077 cm 17* h 6,5 6 3/4" x h 2 1/2" inner 6 master 18 Bowl Bowl BI024173657 8056444218107 cm 17* h 6,5 6 3/4" x h 2 1/2" inner 6 master 18 Bowl Bowl BI024174711 8056444218091 cm 17* h 6,50 6 3/4" x h 2 1/2" inner 6 master 18 3264 · Grey-Grigio4711 · Green-Verde 3265 · Light blue-Azzurro 3657 · Orange-Arancio 3264 ·
· Green-Verde 3265 · Light
3657 · Orange-Arancio b-rush
Grey-Grigio4711
blue-Azzurro





















104 105 Coppetta Small bowl BI004103264 8056444047875 cm 10* h 4,5* 7,5 · cc 110 4" x h 1 3/4" x 3" · 3 3/4 oz. inner 6 master 72 Coppetta Small bowl BI004103265 8056444047882 cm 10* h 4,5* 7,5 · cc 110 4" x h 1 3/4" x 3" · 3 3/4 oz. inner 6 master 72 Coppetta Small bowl BI004103657 8056444107036 cm 10* h 4,5* 7,5 · cc 110 4" x h 1 3/4" x 3" · 3 3/4 oz. inner 6 master 72 Coppetta Small bowl BI004104711 8056444107159 cm 10* h 4,5* 7,5 · cc 110 4" x h 1 3/4" x 3" · 3 3/4 oz. inner 6 master 72 Cereal bowl Cereal bowl inner 6 master 48 BI001143265 8056444047851 cm 14* h 6* 13 · cc 360 5 1/2" x h 2 1/4" x 5" · 12 1/4 oz. Cereal bowl Cereal bowl inner 6 master 48 BI001143264 8056444047844 cm 14* h 6* 13 · cc 360 5 1/2" x h 2 1/4" x 5" · 12 1/4 oz. Cereal bowl Cereal bowl inner 6 master 48 BI001143657 8056444106985 cm 14* h 6* 13 · cc 360 5 1/2" x h 2 1/4" x 5" · 12 1/4 oz. Cereal bowl Cereal bowl inner 6 master 48 BI001144711 8056444107104 cm 14* h 6* 13 · cc 360 5 1/2" x h 2 1/4" x 5" · 12 1/4 oz. Tazza caffè Coffee cup BI015103264 8056444124033 cm 6,7* h 5,5* 8,5 · cc 105 2 3/4" x h 2 1/4" x 3 1/4" · 3 1/2 oz. inner 6 master 36 Tazza caffè Coffee cup BI015104711 8056444124064 cm 6,7* h 5,5* 8,5 · cc 105 2 3/4" x h 2 1/4" x 3 1/4" · 3 1/2 oz. inner 6 master 36 Tazza caffè Coffee cup BI015103657 8056444124057 cm 6,7* h 5,5* 8,5 · cc 105 2 3/4" x h 2 1/4" x 3 1/4" · 3 1/2 oz. inner 6 master 36 Tazza caffè Coffee cup BI015103265 8056444124040 cm 6,7* h 5,5* 8,5 · cc 105 2 3/4" x h 2 1/4" x 3 1/4" · 3 1/2 oz. inner 6 master 36 Tazza cappuccino Cappuccino cup BI016203264 8056444124071 cm 8,5* h 7,2* 11 · cc 220 3 1/4" x h 2 3/4" x 4 1/4" · 7 1/2 oz. inner 6 master 36 Tazza cappuccino Cappuccino cup BI016204711 8056444124101 cm 8,5* h 7,2* 11 · cc 220 3 1/4" x h 2 3/4" x 4 1/4" · 7 1/2 oz. inner 6 master 36 Tazza cappuccino Cappuccino cup BI016203265 8056444124088 cm 8,5* h 7,2* 11 · cc 220 3 1/4" x h 2 3/4" x 4 1/4" · 7 1/2 oz. inner 6 master 36 Tazza cappuccino Cappuccino cup BI016203657 8056444124088 cm 8,5* h 7,2* 11 · cc 220 3 1/4" x h 2 3/4" x 4 1/4" · 7 1/2 oz. inner 6 master 36
3264 · Grey-Grigio4711 · Green-Verde
3265 · Light blue-Azzurro 3657 · Orange-Arancio
3264 · Grey-Grigio4711 · Green-Verde
b-rush
3265 · Light blue-Azzurro 3657 · Orange-Arancio
Piattino cappuccino/colazione Cappuccino/breakfast saucer BI006153264













1/2" x h 1/2" x 5 1/2"
BI006154711 8056444124149 cm 14* h 1,5* 14 5 1/2" x h 1/2" x 5 1/2"

Piattino cappuccino/colazione Cappuccino/breakfast saucer
inner 6 master 36
inner 6 master 36




Piattino cappuccino/colazione Cappuccino/breakfast saucer
BI006153265 8056444124125 cm 14* h 1,5* 14


1/2" x h 1/2" x 5 1/2"
Piattino cappuccino/colazione
Cappuccino/breakfast saucer
36

106 107 Piattino caffè Coffee saucer BI005123264 8056444123999 cm 11,5* h 1,5* 11,5 4 1/2" x h 1/2" x 4 1/2" inner 6 master 36 Piattino caffè Coffee saucer BI005124711 8056444124026 cm 11,5* h 1,5* 11,5 4 1/2" x h 1/2" x 4 1/2" inner 6 master 36 Piattino caffè Coffee saucer BI005123265 8056444124002 cm 11,5* h 1,5* 11,5 4 1/2" x h 1/2" x 4 1/2" inner 6 master 36 Piattino caffè Coffee saucer BI005123657 8056444124019 cm 11,5* h 1,5* 11,5 4 1/2" x h 1/2" x 4 1/2" inner 6 master 36 Tazza colazione Breakfast cup BI017533264 8056444123951 cm 8,7* h 8* 11,5 · cc 280 3 1/2" x h 3 1/4" x 4 1/2" · 9 1/2 oz. inner 6 master 36 Tazza colazione Breakfast cup BI017534711 8056444123982 cm 8,7* h 8* 11,5 · cc 280 3 1/2" x h 3 1/4" x 4 1/2" · 9 1/2 oz. inner 6 master 36 Tazza colazione Breakfast cup BI017533265 8056444123968 cm 8,7* h 8* 11,5 · cc 280 3 1/2" x h 3 1/4" x 4 1/2" · 9 1/2 oz. inner 6 master 36 Tazza colazione Breakfast cup BI017533657 8056444123975 cm 8,7* h 8* 11,5 · cc 280 3 1/2"
x h 3 1/4" x 4 1/2" · 9 1/2 oz. inner 6 master 36
8056444124132 cm
5
inner
BI006153657
14* h 1,5* 14
1/2" x h 1/2" x 5 1/2"
6 master 36
8056444124118 cm
5
14* h 1,5* 14
cm
6"
inner
BI018153265 8056444124163 cm
6,5*
6"
2
7
inner 4
cm
6,5*
6"
inner 4
BI018153657 8056444124170 cm
6,5*
6"
inner 4
5
inner 6 master
Tazza brodo Soup cup BI018153264 8056444124156
15* h 6,5* 18,2 · cc 680
x h 2 1/2" x 7 1/4" · 23 oz.
4 master 24 Tazza brodo Soup cup
15* h
18,2 · cc 680
x h
1/2" x
1/4" · 23 oz.
master 24 Tazza brodo Soup cup BI018154711 8056444124187
15* h
18,2 · cc 680
x h 2 1/2" x 7 1/4" · 23 oz.
master 24 Tazza brodo Soup cup
15* h
18,2 · cc 680
x h 2 1/2" x 7 1/4" · 23 oz.
master 24
3264 · Grey-Grigio4711 · Green-Verde 3265 · Light blue-Azzurro 3657 · Orange-Arancio
b-rush
3264 · Grey-Grigio4711 · Green-Verde 3265 · Light blue-Azzurro 3657 · Orange-Arancio



















108 109 Ovale forno Oval baking dish BI040263264 8056444140293 cm 25,5* h 4,5* 14 · cc 400 10" x h 1 3/4" x 5 1/2" · 13 1/2oz. inner 4 master 24 Ovale forno Oval baking dish BI040264711 8056444140323 cm 25,5* h 4,5* 14 · cc 400 10" x h 1 3/4" x 5 1/2" · 13 1/2oz. inner 4 master 24 Ovale forno Oval baking dish BI040263265 8056444140309 cm 25,5* h 4,5* 14 · cc 400 10" x h 1 3/4" x 5 1/2" · 13 1/2oz. inner 4 master 24 Ovale forno Oval baking dish BI040263657 8056444140316 cm 25,5* h 4,5* 14 · cc 400 10" x h 1 3/4" x 5 1/2" · 13 1/2oz. inner 4 master 24 Ovale forno Oval baking dish BI040233264 8056444140347 cm 23* h 4* 13 · cc 250 9" x h 1 1/2" x 5" · 8 1/2 oz. inner 6 master 36 Ovale forno Oval baking dish BI040234711 8056444140378 cm 23* h 4* 13 · cc 250 9" x h 1 1/2" x 5" · 8 1/2 oz. inner 6 master 36 Ovale forno Oval baking dish BI040233657 8056444140361 cm 23* h 4* 13 · cc 250 9" x h 1 1/2" x 5" · 8 1/2 oz. inner 6 master 36 Ovale forno Oval baking dish BI040233265 8056444140354 cm 23* h 4* 13 · cc 250 9" x h 1 1/2" x 5" · 8 1/2 oz. inner 6 master 36 Ovale forno Oval baking dish BI040203264 8056444140392 cm 20* h 4* 11,5 · cc 300 7 3/4" x h 1 1/2" x 4 1/2" · 10 oz. inner 6 master 36 Ovale forno Oval baking dish BI040203265 8056444140408 cm 20* h 4* 11,5 · cc 300 7 3/4" x h 1 1/2" x 4 1/2" · 10 oz. inner 6 master 36 Ovale forno Oval baking dish BI040204711 8056444140422 cm 20* h 4* 11,5 · cc 300 7 3/4" x h 1 1/2" x 4 1/2" · 10 oz. inner 6 master 36 Ovale forno Oval baking dish BI040203657 8056444140415 cm 20* h 4* 11,5 · cc 300 7 3/4" x h 1 1/2" x 4 1/2" · 10 oz. inner 6 master 36
3264 · Grey-Grigio4711 · Green-Verde 3265 · Light blue-Azzurro 3657 · Orange-Arancio
b-rush
3264 · Grey-Grigio4711 · Green-Verde 3265 · Light blue-Azzurro 3657 · Orange-Arancio
seaside maiolica
una serie unica di piatti decorati in stile maiolica con tecnica digital printing ideale per un perfetto mood italiano
an unique collection of "maiolica" decorated carged plates and pasta bowl ideal for tour italian mood restaurant




* *
PX02231M088 8056444136784 cm 30,8* h 2,5* 30,8 12" x h 1" x 12"
Sottopiatto maiolica Maiolica charger plate




inner 6 master 12
PX003145684 8056444176902 cm 14* 5 1/2"
Piatto pane Bread plate
inner 6 master 36



PX02327M088 8056444136814 cm 26,6* h 5,5* 26,6 10 1/2" x h 2 1/4" x 10 1/2"
* Confezione minima 6 pezzi 3 design assortiti Min quantity 6 pcs 3 designs mix and match

Pasta bowl maiolica Maiolica pasta bowl
inner 6 master 12
111
contemporary white
forme di porcellana bianca, dura e resistente alle sbeccature ideali per la ristorazione moderna, gourmet o informale per la banchettistica e l'hotellerie
strong and chipping-resistant white porcelain shapes ideal for modern or informal gourmet cuisine, catering, banqueting and hotels

forma rotonda coupe con texture materica che ricorda le onde del

round















shape with material texture that remind the waves of the

114 115 Piatto piano Dinner plate PX000260000 8056444129724 cm 25,8* h 2,5* 25,8 10 1/4" x h 1" x 10 1/4" inner 6 master 18 Piatto dessert Dessert plate PX002200000 8056444129731 cm 19,5* h 2* 19,5 7 1/2" x h 3/4" x 7 1/2" inner 6 master 24 Piatto pane Bread plate PX003140000 8056444129779 cm 14,2* h 2,3* 14,2 5 1/2" x h 1" x 5 1/2" inner 6 master 36 Piatto piano Dinner plate PX000280000 8056444129717 cm 27,2* h 2,5* 27,2 10 3/4" x h 1" x 10 3/4" inner 6 master 18 Piatto fondo gourmet Gourmet deep plate PX023270000 8056444129755 cm 26,6* h 5,5* 26,6 10 1/2" x h 2" x 10 1/2" · 6 3/4 oz. inner 4 master 12 Piatto fondo gourmet Gourmet deep plate PX023240000 8056444129748 cm 23,3* h 5,4* 23,3 9 1/4" x h 2" x 9 1/4" · 10 oz. inner 4 master 12 Sottopiatto coupe Charger coupe plate PX022310000 8056444129762 cm 30,8* h 2,5* 30,8 12" x h 1" x 12" inner 6 master 12 Tazza caffè Coffee cup PX015100000 8056444129786 cm 6* h 6,4* 8,4 2 1/4" x h 2 1/2" x 3 1/4" · 2 oz. inner 6 master 36 Tazza tè Tea cup PX016220000 8056444129809 cm 8,2* h 7* 11,7 3 1/4" x h 2 3/4" x 4 1/2" · 5 1/4 oz. inner 6 master 36
Coffee saucer PX005120000 8056444129793 cm 12* h 2* 12 4 3/4" x h 3/4" x 4 3/4" inner 6 master 36 Piattino tè Tea saucer PX006150000 8056444129816 cm 14* h 2* 14 5 1/2" x h 3/4" x 5 1/2" inner 6 master 36 Coppetta Bowl PX068130000 8056444129960 cm 13* h 7,5* 13 5" x h 3" x 5" · 10 oz. inner 6 master 36
Piattino caffè
seaside
sea
mare
coupe
forma a falda per una collezione unica caratterizzata da un design sofisticato e completa di articoli in stile contemporaneo perfetto per hotels e ristoranti flat shape for a complete and unique collection characterized by a sophisticated design in a contemporary style, perfect for hotels and restaurants















116 117 Piatto fondo Soup plate TZ001240000 8000257579443 cm 24* h 4* 24 · cc 280 9 1/2" x h 1 1/2" x 9 1/2" · 9 1/2 oz. inner 6 master 24 Piatto piano falda lavorata Dinner plate TZ000270000 8000257829722 cm 28,2* h 3,1* 28,2 11" x h 1 1/4" x 11" inner 6 master Piatto piano Dinner plate TZ000280000 8000257579436 cm 28* h 2,7* 28 11" x h 1" x 11" inner 6 master 12 Piatto piano Dinner plate TZ000250000 8000257579412 cm 25,3* h 2,5* 25,3 10" x h 1" x 10" inner 6 master 24 Piatto dessert Dessert plate TZ002210000 8000257579504 cm 21* h 2,5* 21 8 1/4" x h 1" x 8 1/4" inner 6 master 24 Piatto pane Bread plate TZ003160000 8000257579511 cm 16* h 2,2* 16 6 1/4" x h 3/4" x 6 1/4" inner 6 master 24 Piatto piano gourmet Gourmet dinner plate TZ000290000 8000257829623 cm 28* h 2,7* 28 11" x h 1" x 11" inner 6 master 12 Rotondo piano Charger plate TZ022310000 8000257580067 cm 30,2* h 2,7* 30,2 12" x h 1" x 12" inner 6 master 12 Piatto edge Edge plate Piatto edge Edge plate Piatto edge Edge plate TZ001270000 8056444450965 TZ001210000 8056444456875 TZ001310000 8056444001129 cm 27* h 2,8 10 3/4" x h 1 1/4" cm 21* h 2,8 8 1/4" x h 1 1/4" cm 31* h 2,8 12 1/4" x h 1 1/4" inner 6 inner 6 inner 6 master master master thesis
NEW 2024















119 TZ023240000 Ø cm 24 TZ023300000 Ø cm 30 TZ023290000 Ø cm 28 TZ023280000 Ø cm 28 TZ023260000 Ø cm 26 Ovale piano Oval plate TZ020320000 8000257832098 cm 32* h 3* 28 12 1/2" x h 1 1/4" x 11" inner 6 master Piatto fondo gourmet Gourmet deep plate TZ023240000 8000257830087 cm 24* h 4,5* 24 · cc 340 9 1/2" x h 1 3/4" x 9 1/2" · 11 1/2 oz. inner 6 master Piatto fondo gourmet Gourmet deep plate TZ023260000 8000257580074 cm 26* h 6* 26 · cc 360 10 1/4" x h 2 1/4" x 10 1/4" · 12 1/4 oz. inner 6 master 12 Piatto fondo gourmet Gourmet deep plate TZ023280000 8000257830063 cm 28* h 5* 28 · cc 400 11" x h 2" x 11" · 13 1/2 oz. inner 6 master Piatto fondo gourmet Gourmet deep plate TZ023290000 8000257830070 cm 28* h 5,2* 28 · cc 300 11" x h 2" x 11" · 10 1/4 oz. inner 6 master Piatto fondo gourmet Gourmet deep plate TZ023300000 8000257580081 cm 30,3* h 6,5* 30,5 · cc 600 12" x h 2 1/2" x 12" · 20 1/4 oz. inner 6 master 12 Insalatiera Salad bowl TZ024180000 8000257580098 cm 18* h 4,5* 18 · cc 430 7" x h 1 3/4" x 7" · 14 1/2 oz. inner 6 master 24 Insalatiera Salad bowl TZ024220000 8000257580104 cm 22,7* h 6* 22,7 · cc 600 9" x h 2 1/4" x 9" · 20 1/4 oz. inner 6 master 24 Insalatiera Salad bowl TZ024260000 8000257580197 cm 25,7* h 6,7* 25,7 · cc 900 10" x h 2 3/4" x 10" · 30 1/2 oz. inner 1 master 12 Ovale piano Oval plate TZ020360000 8000257580036 cm 36* h 2,7* 24,5 14 1/4" x h 1" x 9 3/4" inner 6 master 12 Ovale piano Oval plate TZ020420000 8000257580050 cm 42* h 2,7* 28 16 1/2" x h 1" x 11" inner 1 master 12 Ovale piano Oval plate TZ020290000 8000257580012 cm 29* h 2* 21 11 1/2" x h 3/4" x 8 1/4" inner 6 master 12
thesis















120 121 Tazza caffè Coffee cup TZ015090000 8000257579559 cm 6,5* h 5,2* 9 · cc 100 2 1/2" x h 2" x 3 1/2" · 3 1/2 oz. inner 6 master 24 Tazza tè Tea cup TZ016220000 8000257579610 cm 9,5* h 5,5* 12 · cc 220 3 3/4" x h 2 1/4" x 4 3/4" · 7 1/2 oz. inner 6 master 24 Tazza colazione impilabile Breakfast cup TZ017330000 8000257579788 cm 10,8* h 6* 13,5 · cc 300 4 1/4" x h 2 1/4" x 5 1/4" · 10 oz. inner 6 master 24 Tazza tè Tea cup TZ016190000 8000257579580 cm 7,5* h 7* 10 · cc 190 3" x h 2 3/4" x 4" · 6 1/2 oz. inner 6 master 24 Lattiera Milk jug TZ032050000 8000257580562 cm 4,7* h 7,5* 8 · cc 80 1 3/4" x h 3" x 3 1/4" · 2 3/4 oz. inner 6 master 24 Lattiera Milk jug TZ032230000 8000257580593 cm 7* h 10,5* 11,5 · cc 320 2 3/4" x h 4 1/4" x 4 1/2" · 10 3/4 oz. inner 6 master 24 Lattiera Milk jug TZ032110000 8000257580579 cm 6,5* h 8,5* 10 · cc 180 2 1/2" x h 3 1/4" x 4" · 6 oz. inner 6 master 24 Piattino caffè Coffee saucer TZ005130000 8000257579535 cm 13,5* h 2* 13,5 5 1/4" x h 3/4" x 5 1/4" inner 6 master 24 Piattino tè Tea saucer TZ006160000 8000257579542 cm 16* h 2* 16 6 1/4" x h 3/4" x 6 1/4" inner 6 master 24 * * Utilizzabile con TZ017330000 + TZ018330000 + TZ016220000 + TZ016190000 + TZ018340000 Fitting with TZ017330000 + TZ018330000 + TZ016220000 + TZ016190000 + TZ018340000
impilabile Stackable bowl TZ004150000 8000257829685 cm 15* h 6,8* 15 · cc 700 6" x h 2 3/4" x 6" · 23 3/4 oz. inner 6 master 24 Tazza brodo Soup cup TZ018330000 8000257579795 cm 11* h 6,5* 15,5 · cc 310 4 1/4" x h 2 1/2" x 6" · 10 1/2 oz. inner 6 master 24 Tazza brodo senza manico No handle soup cup TZ018340000 805644281811 cm 11* h 6,5* 10 · cc 330 4 1/4" x h 2 1/2" x 4" · 11 1/4 oz inner 6 master 24 thesis
Coppetta

















122 123 Teiera Tea pot TZ033030000 8000257580722 cm 11* h 8,5* 15,5 · cc 350 4 1/4" x h 3 1/4" x 6" · 11 3/4 oz. inner 6 master 24 Teiera Tea pot TZ033050000 8000257582122 cm 14* h 10,5* 19 · cc 500 5 1/2" x h 4 1/4" x 7 1/2" · 17 oz. inner 1 master 6 Coperchio caffettiera Lid for coffee pot TZ069B10000 8000257829692 cm 7,5* h 2,5* 7,5 3" x h 1" x 3" inner 12 master 48 Coperchio teiera Lid for tea pot TZ069D10000 8000257829630 cm 7* h 2,2* 7 2 3/4" x h 3/4" x 2 3/4" inner 12 master 48 Caffettiera Coffee pot TZ030040000 8000257580500 cm 8,5* h 13,5* 13 · cc 400 3 1/4" x h 5 1/4" x 5" · 13 1/2 oz. inner 1 master 6 Portauovo Egg cup TZ046060000 8000257829654 cm 4,5* h 5,7* 4,5 1 3/4" x h 2 1/4" x 1 3/4" inner 6 master 24 Coppetta ovale olio Oil cup TZ004090000 8000257829708 cm 10* h 2,2* 7 · cc 30 4" x h 3/4" x 2 3/4" · 1 oz. inner 6 master 24 Portabustine Sugar holder TZ004110000 8000257829661 cm 11* h 4* 7,5 · cc 160 4 1/4" x h 1 1/2" x 3" · 5 1/2 oz. inner 6 master 24 Coppetta Fruit bowl TZ004140000 8000257579528 cm 14* h 3,5* 14 · cc 120 5 1/2" x h 1 1/2" x 5 1/2" · 4 oz. inner 6 master 24 thesis
forma a falda per una collezione completa di articoli in stile contemporaneo ideali per hotel e ristoranti
flat shape for a complete collection of contemporary style items ideal for hotels and restaurants












124 125 Rotondo piano Charger plate AM022300000 8000257840260 cm 30,7* h 2,8* 30,7 12" x h 1" x 12" inner 6 master 12 Piatto piano Dinner plate AM000270000 8000257840277 cm 27,2* h 2,5* 27,2 10 3/4" x h 1" x 10 3/4" inner 6 master 12 Piatto dessert Dessert plate AM002190000 8000257840284 cm 19,5* h 2* 19,5 7 3/4" x h 3/4" x 7 3/4" inner 6 master 24 Piatto fondo Soup plate AM001230000 8000257840291 cm 23,5* h 4* 23,5 · cc 330 9 1/4" x h 1 1/2" x 9 1/4" · 11 1/4 oz. inner 6 master 24 Ovale piano Oval plate AM020370000 8000257840369 cm 37* h 2,2* 26,3 14 1/2" x h 3/4" x 10 1/4" inner 6 master 12 Ovale piano Oval plate AM020260000 8000257840383 cm 26* h 2,3* 18,7 10 1/4" x h 1" x 7 1/4" inner 6 master 12 Ovale piano Oval plate AM020320000 8000257840376 cm 32* h 2,7* 22,3 12 1/2" x h 1" x 8 3/4" inner 6 master 12
bowl Pasta bowl AM023270000 8000257840253 cm 27,3* h 5* 27,3 · cc 400 10 3/4" x h 2" x 10 3/4" · 13 1/2 oz. inner 6 master 18
Pasta
ambiente















126 127 Insalatiera impilabile Stackable salad bowl AM024180000 8000257840352 cm 18,5* h 7,3* 18,5 · cc 1230 7 1/4" x h 2 3/4" x 7 1/4" · 41 1/2 oz. inner 6 master 12 Coppetta impilabile Stackable fruit bowl AM004110000 8000257021997 cm 11,3* h 5* 11,3 · cc 300 4 1/2" x h 2" x 4 1/2" · 10 1/4 oz. inner 6 master 24 Coppetta cereali impilabile Stackable cereal bowl TZ004150000 8000257829685 cm 15* h 6,8* 15 · cc 700 6" x h 2 3/4" x 6" · 23 3/4 oz. inner 6 master 24 Tazza caffè impilabile Stackable coffee cup AM015090000 8000257840499 cm 6,5* h 5* 8,5 · cc 90 2 1/2" x h 2" x 3 1/4" · 3 oz. inner 6 master 24 Tazza tè impilabile Stackable tea cup AM016220000 8000257840314 cm 8,5* h 6,5* 11 · cc 220 3 1/4" x h 2 1/2" x 4 1/4" · 7 1/2 oz. inner 6 master 24 Piattino caffè Coffee saucer AM005120000 8000257840307 cm 12* h 2* 12 4 3/4" x h 3/4" x 4 3/4" inner 6 master 24 Piattino tè Tea saucer AM006150000 8000257840321 cm 14,7* h 2* 14,7 5 3/4" x h 3/4" x 5 3/4" inner 6 master 24 ambiente
contemporary cream
forme di porcellana in caldo color crema, resistente alle sbeccature ed ideale per la ristorazione moderna gourmet o informale, la banchettistica e l'hotellerie
porcelain shapes in warm strong creamy colour, chipping-resistant and ideal for modern gourmet or informal cuisine, banquets and hotels












131 Piatto pane Bread plate AT003150000 8056444359848 cm 15 6" inner 12 master Piatto piano Dinner plate AT000300000 8056444360073 cm 30 11 3/4" inner 6 master Piatto piano Dinner plate AT000270000 8056444360011 cm 27 10 3/4" inner 6 master Piatto dessert Dessert plate AT002210000 8056444359893 cm 21 8 1/4" inner 12 master Piatto piano Dinner plate AT000230000 8056444359954 cm 23 9" inner 12 master
attitude white
WARR A NTY 5 Y E ARS *
* Garantito 5 anni contro la sbeccatura dei bordi (vedi pagina 6) Guaranteed for 5 years against edge chipping (see page 6)






























132 133 Piatto edge Edge plate AT001270000 8056444360554 cm 27* h 2,8 10 3/4" x h 1 1/4" inner 6 master Piatto edge Edge plate AT001230000 8056444360493 cm 23* h 2,5 9" x h 1" inner 6 master Piatto fondo Soup plate AT001250000 8056444360196 cm 25* h 5,5 9 3/4" x h 2 1/4" inner 6 master Piatto fondo Soup plate AT001210000 8056444360134 cm 21* h 4,5 8 1/4" x h 1 3/4" inner 6 master Piatto fondo gourmet Gourmet deep plate AT001260000 8056444360257 cm 25* h 5,5 9 3/4" x h 2 1/4" inner 6 master Piatto fondo gourmet Gourmet deep plate AT001280000 8056444360318 cm 28* h 6 11" x h 2 1/4" inner 6 master Tazza the The cup AT016100000 8056444360851 cc 220 7 1/4 oz. inner 12 master Piattino the The saucer AT006100000 8056444360912 cm 16 6 1/4" inner 12 master Piatto rettangolare Rectangular plate AT022360000 8056444360677 cm 36* 16,5 14 1/4" x 6 1/2" inner 6 master Piatto rettangolare Rectangular plate AT022240000 8056444360615 cm 24* 15 9 1/2" x 6" inner 12 master Coppetta Bowl AT004150000 8056444360431 cm 15* h 5 6" x h 2" inner 12 master Insalatiera Salad bowl AT024220000 8056444360370 cm 22* h 7,5 8 3/4" x h 3" inner 6 master Tazza caffè Coffee cup AT015080000 8056444360738 cc 80 2 3/4 oz. inner 12 master Piattino caffè Coffee saucer AT005080000 8056444360790 cm 12 4 3/4" inner 12 master
eleganza classica e senza tempo per una linea tavola perfetta per le cerimonie più raffinate. Jasmin si distingue per un decoro a rilievo tono su tono, di ispirazione floreale.






Jasmin with is unique flowery relief, classic and timeless elegance is perfect for wedding and banqueting environments









134 135 Rotondo piano Charger Plate JA022310000 8056444294224 cm 31* h 2* 12 1/4" x h 3/4" inner 6 master 18 Piatto piano Dinner plate JA000280000 8056444294101 cm 28* h 2,5* 11" x h 1" inner 6 master 12 Piatto piano Dinner plate JA000250000 8056444294194 cm 25* h 2,5* 9 3/4" x h 1" inner 6 master 18 Piatto dessert Dessert plate JA002190000 8056444294163 cm 20,5* h 2,5* 8" x h 1" inner 6 master 36 Piatto fondo gourmet Gourmet deep plate JA023290000 8056444294347 cm 29,5* h 5,5* · cc 480 11 1/2" x h 2 1/2" · 16 1/4 oz. inner 4 master 12 Piatto fondo gourmet Gourmet deep plate JA001250000 8056444294316 cm 25* h 5* · cc 430 9 3/4" x h 2" · 14 1/4 oz. inner 6 master 18 Piatto fondo Soup plate JA001220000 8056444294286 cm 23* h 4 · cc 780 9" x h 1 1/2" · 26 1/4 oz. inner 6 master 24 Piatto pane Bread plate JA003160000 8056444294149 cm 16* h 2* 6 1/4" x h 3/4" inner 12 master 72
jasmin
jasmin

















137 Insalatiera Salad bowl JA024200000 8056444294439 cm 20* h 7,5* · cc 140 7 3/4" x h 3" · 49 oz. inner 4 master 16 Coppetta Bowl JA004150000 8056444294408 cm 16* h 6,5* · cc 700 6 1/4" x h 2 1/2" · 23 3/4 oz. inner 6 master 24 Piatto rettangolare Rectangular plate JA034300000 8056444294255 cm 30,5* h 2,5* 20,5 12" x h 1" x 8 1/2" inner 6 master 18 Ovale Oval plate JA020300000 8056444294378 cm 30,5* h 2,5* 21,5 12" x h 1" x 8 1/2" inner 6 master 18 Tazza the Tea cup JA016200000 8056444294521 cm 11* h 6* 9 · cc 200 4 1/4" x h 2 1/2" x 3 1/2" · 6 3/4 oz. inner 12 master 72 Tazza caffé Coffee cup JA015090000 8056444294460 cm 9* h 5* 7 · cc 90 3 1/2" x h 2" x 2 3/4" · 3 oz. inner 12 master 144 Piattino the Tea saucer JA006160000 8056444294552 cm 16* h 2* 6 1/4" x h 3/4" inner 12 master 72 Piattino caffé Coffee saucer JA005110000 8056444294491 cm 11,5* h 1,5 4 1/2" x h 1/2" inner 12 master 144
Piatto quadro Square plate
6 master 12
Piatto quadro Square plate
Piatto quadro Square plate PV000150000 8000257308944
6 master 72
forme rettangolari e quadrate per questa linea moderna, ideale per ristoranti e bar
square







Piatto quadro Square plate
6 master 24
6 master 18 Piatto quadro Square plate
6 master 36
Piatto quadro Square plate






Piatto quadro Square plate PV000100000 8000257308708
x h 1/2" x 4"
12 master 72
6 master 144
Piatto fondo Soup plate

for this modern line, ideal for restaurants and bar

138 139
PV000300000
cm
12"
inner
8000257309187
30,3* h 2,5* 30,3
x h 1" x 12"
PV000220000
cm
8
inner
8000257309033
22* h 2* 22
3/4" x h 3/4" x 8 3/4"
PV000250000 8000257309170 cm
10"
inner
PV000190000 8000257309019 cm
7
inner
25,5* h 2,2* 25,5
x h 3/4" x 10"
19* h 1,7* 19
1/2" x h 3/4" x 7 1/2"
cm
4"
10* h 1,2* 10
inner
cm
5"
PV000130000 8000257308722
12,7* h 1,2* 12,7
x h 1/2" x 5" inner
cm
6"
15* h 1,4* 15
x h 1/2" x 6" inner
PV001200000 8000257729848 cm
8 1/2"
h 1 3/4"
8 1/2"
oz. inner 6
PV020100000 8000257729862 cm 33,7* h 1,2* 10 13 1/4" x h 1/2" x 4" inner 6
36
PV020230000 8000257309477 cm 22,8* h 1,7* 14,8 9" x h 3/4" x 5 3/4" inner
8000257309484 cm
1,7*
11"
3/4"
7" inner 6
PV020330000 8000257309491 cm
13"
inner
PV020380000 8000257309521 cm
inner 6
12 Insalatiera rettangolare Rectangular salad bowl PV024180000 8000257309590 cm 18* h 5* 13 · cc 480 7" x h 2" x 5" · 16 1/4 oz. inner 6 master 24 Insalatiera rettangolare Rectangular salad bowl PV024280000 8000257309675 cm 28* h 5* 21 · cc 1450 11" x h 2" x 8 1/4" · 49 oz. inner 1 master 18 Piattino caffè Coffee saucer PV005100000 8000257309194 cm 10,3* h 1,5* 10,3 4" x h 1/2" x 4" inner 6 master 162 Piattino tè Tea saucer PV006130000 8000257309347 cm 13,3* h 1,5* 13,5 5 1/4" x h 1/2" x 5 1/4" inner 6 master 108 Piattino colazione Breakfast saucer PV007150000 8000257309392 cm 15,3* h 1,5* 15,3 6" x h 1/2" x 6" inner 6 master 72 * * * * Utilizzabile con tazze Infinity FR017330000 + FR016230000 + FR015080000 Fitting with Infinity cups FR017330000 + FR016230000 + FR015080000 plain
21,5* h 4,5* 21,5 · cc 740
x
x
· 25
master 24 Piano rettangolare Rectangular plate
master
Piano rettangolare Rectangular plate
6 master 36 Piano rettangolare Rectangular plate PV020280000
27,7* h
17,5
x h
x
master 24 Piano rettangolare Rectangular plate
33* h 2,3* 20,3
x h 1" x 8"
6 master 18 Piano rettangolare Rectangular plate
38* h 2,3* 22,8 15" x h 1" x 9"
master
cuisinetangular and
shapes
forme
e quadrate per questa linea moderna, ideale per ristoranti e bar
rectangular








for this modern line, ideal for restaurants and bar




140 141 Piatto piano Dinner plate FR000290000 8000257619088 cm 29,3* h 2,7* 29 11 1/2" x h 1" x 11 1/2" inner 6 master 18 Piatto piano Dinner plate FR000260000 8000257618814 cm 26,3* h 2,2* 26,3 10 1/4" x h 3/4" x 10 1/4" inner 6 master 24 Piatto dessert Dessert plate FR002210000 8000257619330 cm 21,2* h 1,9* 21,2 8 1/4" x h 3/4" x 8 1/4" inner 6 master 36 Piatto burro Butter plate FR003110000 8000257618845 cm 11,5* h 1,6* 11,5 4 1/2" x h 3/4" x 4 1/2" inner 12 master 144 Piatto fondo Soup plate FR001190000 8000257618937 cm 19,5* h 4,2* 19,5 · cc 630 7 3/4" x h 1 3/4" x 7 3/4" · 21 1/4 oz. inner 6 master 36 Piatto fondo Soup plate FR001260000 8000257599496 cm 25,8* h 4,5* 25,8 · cc 1500 10 1/4" x h 1 3/4" x 10 1/4" · 50 3/4 oz. inner 6 master 18 Piatto pane Bread plate FR003140000 8000257618838 cm 14,2* h 1,8* 14,2 5 1/2" x h 3/4" x 5 1/2" inner 6 master 108 Insalatiera Salad bowl FR024170000 8000257618906 cm 16,8* h 6,6* 16,5 · cc 670 6 1/2" x h 2 1/2" x 6 1/2" · 22 1/2 oz. inner 6 master 24 Insalatiera Salad bowl FR024200000 8000257618890 cm 20,2* h 7,5* 20 · cc 1240 8" x h 3" x 7 3/4" · 42 oz. inner 6 master 24 Insalatiera Salad bowl FR024240000 8000257618883 cm 24* h 8,9* 23,3 · cc 2330 9 1/2" x h 3 1/2" x 9 1/4" · 78 3/4 oz. inner 4 master 16 Portata rettangolare Rectangular plate FR020280000 8000257618876 cm 28,5* h 2* 17,7 11 1/4" x h 3/4" x 7" inner 6 master 30 Portata rettangolare Rectangular plate FR020330000 8000257618869 cm 33,5* h 2,4* 20,3 13 1/4" x h 1" x 8" inner 6 master 18 Portata rettangolare Rectangular plate FR020400000 8000257618852 cm 37,9* h 2,7* 23,2 15" x h 1" x 9 1/4" inner 6 master 12 infinity
rettangolari
and square shapes















142 143 Tazza caffè Coffee cup FR015080000 8000257619019 cm 6* h 5,6* 8,8 · cc 80 2 1/4" x h 2 1/4" x 3 1/2" · 2 3/4 oz. inner 6 master 144 Tazza tè Tea cup FR016230000 8000257619040 cm 8,4* h 8,7* 11,8 · cc 230 3 1/4" x h 3 1/2" x 4 3/4" · 7 3/4 oz. inner 6 master 96 Tazza brodo Soup cup FR018390000 8000257619217 cm 13,4* h 5,4* 17,3 · cc 390 5 1/4" x h 2 1/4" x 6 3/4" · 13 1/4 oz. inner 6 master 72 Tazza colazione Breakfast cup FR017330000 8000257619064 cm 9,2* h 8,3* 12 · cc 330 3 1/2" x h 3 1/4" x 4 3/4" · 11 1/4 oz. inner 6 master 48 Mug conico Conical mug FR014360000 8000257618982 cm 8,8* h 11,3* 11,8 · cc 360 3 1/2" x h 4 1/2" x 4 3/4" · 12 1/4 oz. inner 6 master 48 Piattino caffè Coffee saucer FR005110000 8000257619002 cm 11,3* h 1,7* 11,3 4 1/2" x h 3/4" x 4 1/2" inner 6 master 162 Piattino tè Tea saucer FR006140000 8000257619033 cm 14,2* h 1,8* 14 5 1/2" x h 3/4" x 5 1/2" inner 6 master 72 Piattino colazione Breakfast saucer FR007160000 8000257619057 cm 16* h 2* 15,7 6 1/4" x h 3/4" x 6 1/4" inner 6 master 72 Piatto brodo Soup saucer FR007170000 8000257619200 cm 17* h 1,9* 17 6 3/4" x h 3/4" x 6 3/4" inner 6 master 54 Coppetta quadra Square bowl FR004090000 8000257618920 cm 9* h 4* 9 · cc 120 3 1/2" x h 1 1/2" x 3 1/2" · 4 oz. inner 12 master 192 Coppetta quadra Square bowl FR004120000 8000257618913 cm 11,8* h 5,4* 11,8 · cc 300 4 3/4" x h 2 1/4" x 4 3/4" · 10 1/4 oz. inner 12 master 96 infinity
*utilizzabile con tazze Infinity /fitting with Infinity cups: FR017330000 + FR016230000 + FR015080000











144 145 Porta tovaglioli Napkin holder FR0471H0000 8000257619132 cm 10,5* h 8,2* 4 4 1/4" x h 3 1/4" x 1 1/2" inner 6 master 72 Burriera c/coperchio Butter dish w/lid FR0BR170000 8000257619194 cm 17,5* h 10* 12 7" x h 4" x 4 3/4" inner 6 master 36 Teiera Tea pot FR033850000 8000257619323 cm 12,3* h 16* 23 · cc 830 4 3/4" x h 6 1/4" x 9" · 28 oz. inner 1 master 24 Teiera Tea pot FR033320000 8000257619286 cm 9,5* h 10,5* 16,5 · cc 325 3 3/4" x h 4 1/4" x 6 1/2" · 11 oz. inner 6 master 48 Teiera Tea pot FR033540000 8000257619279 cm 11* h 13,3* 19 · cc 540 4 1/4" x h 5 1/4" x 7 1/2" · 18 1/4 oz. inner 1 master 36 Lattiera Milk jug FR032110000 8000257618944 cm 9,5* h 8,2* 5,8 · cc 110 3 3/4" x h 3 1/4" x 2 1/4" · 3 3/4 oz. inner 6 master 108 Lattiera Milk jug FR032230000 8000257618951 cm 7,5* h 9,7* 11,5 · cc 210 3" x h 3 3/4" x 4 1/2" · 7 oz. inner 6 master 72 Lattiera Milk jug FR032450000 8000257618968 cm 14,5* h 11,6* 9,7 · cc 430 5 3/4" x h 4 1/2" x 3 3/4" · 14 1/2 oz. inner 6 master 48 * Piattino caffè Coffee saucer RS005120000 8000257310435 cm 12,5* h 1,5* 12,5 5 “ x h 1/2 “ 5 “ inner 6 master 162 * Piattino tè Tea saucer RS006150000 8000257310466 cm 15,2* h 1,6* 15,2 6 “ x h 3/4 “ 6 “ inner 6 master 108 * Piattino colazione Breakfast saucer RS007160000 8000257310480 cm 16,5* h 2* 16,5 6 1/2 “ x h 3/4 “ 6 1/2 “ inner 6 master 72
infinity









146 Zuccheriera Sugar bowl FR031210000 8000257619163 cm 9,3* h 10* 9,3 · cc 210 3 3/4" x h 4" x 3 3/4" · 7 oz. inner 6 master 48 Portauovo quadro Square egg cup FR046100000 8000257618975 cm 10* h 2,5* 10 4" x h 1" x 4" inner 6 master 144 Set sale/pepe Salt/pepper 2pcs FR0SA080000 8000257619125 cm 4* h 7,5* 4 · cc 80 1 1/2" x h 3" x 1 1/2" · 2 3/4 oz. inner 6 master 108 Vaso Vase FR0VA170000 8000257619095 cm 5* h 17,2* 5 · cc 210 2" x h 6 3/4" x 2" · 7 oz. inner 6 master 108 infinity
PE622320000
8000257304809
cm 30,3* h 3,5* 30,3
12" x h 1 1/2" x 12"
PE600270000
8000257267890
cm 27* h 3,5* 27
10 3/4" x h 1 1/2" x 10 3/4"
PE600240000
8000257477664
cm 23,7* h 3* 23,7
9 1/4" x h 1 1/4" x 9 1/4"
PE602200000
8000257236988
cm 20,3* h 2,5* 20,3
8" x h 1" x 8"
PE603150000
8000257476995
cm 14,7* h 1,8* 14,7
5 3/4" x h 3/4" x 5 3/4"
perla new bone
linea classica coupe senza tempo in new bone china, ideale per l'hotel e il ristorante
classic timeless coupe shape in creamy colour porcelain, ideal for hotels and restaurants
Rotondo coupe
Coupe Charger plate
Piatto piano coupe
Coupe dinner plate
Piatto piano coupe
Coupe dinner plate




Piatto dessert coupe

Coupe dessert plate
Piatto pane Bread plate
inner 1 master 12
inner 6 master
inner 6 master 24
inner 6 master
inner 6 master 48
PE601200000 8000257267906



cm 20* h 5* 20 · cc 720 7 3/4" x h 2" x 7 3/4" · 24 1/4 oz.
Piatto fondo coupe Coupe soup plate

inner 6 master
PE620370000
8000257304762
cm 36* h 3* 25,5 14 1/4" x h 1 1/4" x 10"
Ovale coupe
Coupe oval plate
inner 1 master 12
148













150 151 Insalatiera Salad bowl PE624240000 8000257268026 cm 23* h 6,5* 23 · cc 1270 9" x h 2 1/2" x 9" · 43 oz. inner 1 master 12 Coppetta Ceral bowls PE604140000 8000257304861 cm 16* h 5* 16 · cc 290 6 1/4" x h 2" x 6 1/4" · 9 3/4 oz. inner 1 master 12 Conf. 6 tazze caffè c/piattino Set 6 coffee cups & saucers PE685010000 8000257304816 cm 12,5* h 6* 12,5 · cc 95 5" x h 2 1/4" x 5" · 3 1/4 oz. inner 1 master 8 Conf. 4 tazze tè c/piattino Set 4 tea cups & saucers PE685130000 8000257304823 cm 15* h 7,5* 15 · cc 250 6" x h 3" x 6" · 8 1/2 oz. inner 1 master 12 Lattiera Milk jug PE632050000 8000257330556 cm 5* h 6* 7,5 · cc 50 2" x h 2 1/4" x 3" · 1 3/4 oz. inner 24 master 192 Lattiera Milk jug PE632100000 8000257330563 cm 6* h 7* 9 · cc 100 2 1/4" x h 2 3/4" x 3 1/2" · 3 1/2 oz. inner 12 master 96 Teiera Tea pot PE633020000 8000257330617 cm 9* h 10* 15 · cc 270 3 1/2" x h 4" x 6" · 9 1/4 oz. inner 4 master 48 Teiera Tea pot PE633050000 8000257330648 cm 11* h 12* 18 · cc 500 4 1/4" x h 4 3/4" x 7" · 17 oz. inner 2 master 24 perla new
bone

classic
porcellana crema, forma classica a falda lavorata in stile barocco perfetta per una ristorazione formale. Ideale per la banchettistica e per l'hotel in stile classico






cream porcelain, classic flat shape worked in baroque style perfect for a formal catering. Ideal for banquets and for classic hotels








154 Piatto piano Dinner plate P5600270000 8000257998404 cm 27,5* h 2,5* 27,5 10 3/4" x h 1" x 10 3/4" inner 6 master 24 Piatto dessert Dessert plate P5602200000 8000257998428 cm 20,5* h 2* 20,5 8" x h 3/4" x 8" inner 6 master 36 Piatto pane Bread plate P5603160000 8000257998435 cm 16* h 2* 16 6 1/4" x h 3/4" x 6 1/4" inner 12 master 48 Piatto fondo Soup plate P5601210000 8000257998411 cm 21,5* h 3,5* 21,5 · cc 170 8 1/2" x h 1 1/2" x 8 1/2" · 5 3/4 oz. inner 6 master 36 Pasta bowl Pasta bowl P5623280000 8000257998442 cm 28* h 5* 28 · cc 400 11" x h 2" x 11" · 13 1/2 oz. inner 4 master 12 Rotondo piano Charger plate P5622300000 8000257998459 cm 30,5* h 2,5* 30,5 12" x h 1" x 12" inner 4 master 12 Ovale piano Oval plate P5620300000 8000257998473 cm 30,5* h 2,7* 21,5 12" x h 1" x 8 1/2" inner 4 master 12 Ovale piano Oval plate P5620350000 8000257998466 cm 35,5* h 3,5* 25 14" x h 1 1/2" x 9 3/4" inner 4 master 12 Coppetta Fruit bowl P5604130000 8000257998831 cm 13* h 4* 13 · cc 220 5" x h 1 1/2" x 5" · 7 1/2 oz. inner 12 master 36 Coppetta Fruit bowl P5604160000 8000257998480 cm 16,3* h 5* 16,3 · cc 400 6 1/2" x h 2" x 6 1/2" · 13 1/2 oz. inner 6 master 36 155 palace

















156 Piattino caffè Coffee saucer P5605130000 8000257998923 cm 13* h 1,8* 13 5" x h 3/4" x 5" inner 12 master 72 Piattino tè Tea saucer P5606160000 8000257998909 cm 16* h 2* 16 6 1/4" x h 3/4" x 6 1/4" inner 6 master 48 Tazza caffè Coffee cup P5615090000 8000257998916 cm 7* h 5* 8,5 · cc 95 2 3/4" x h 2" x 3 1/4" · 3 1/4 oz. inner 12 master 72 Tazza tè Tea cup P5616230000 8000257998893 cm 9* h 6,5* 11,5 · cc 230 3 1/2" x h 2 1/2" x 4 1/2" · 7 3/4 oz. inner 12 master 48 Lattiera Milk jug P5632120000 8000257998886 cm 6* h 6,5* 9 · cc 120 2 1/4" x h 2 1/2" x 3 1/2" · 4 oz. inner 6 master 48 Lattiera Milk jug P5632260000 8000257998879 cm 7,5* h 8* 12,5 · cc 260 3" x h 3 1/4" x 5" · 8 3/4 oz. inner 6 master 48 Teiera Tea pot P5633050000 8000257998862 cm 9,5* h 12,5* 17,5 · cc 500 3 3/4" x h 5" x 7" · 17 oz. inner 6 master 24 Coperchio teiera Lid for tea pot P5669D10000 8000257998855 cm 7* h 4* 7 2 3/4" x h 1 1/2" x 2 3/4" inner 12 master 72 157 palace
vecchio vienna




porcellana bianca made in Italy, classica lavorata con dettagli in stile, ideale per la ristorazione formale, la banchettistica e l'hotellerie in stile classico white porcelain made in Italy, classic style worked with stylish details, ideal for catering, banquets and hotels in a classic style














MADE

158 Piatto fondo Soup plate VW001230772 8000257421872 cm 23,5* h 3,7* 23,5 · cc 260 9 1/4" x h 1 1/2" x 9 1/4" · 8 3/4 oz. inner 6 master 24 Piatto dessert Dessert plate VW002210772 8000257421896 cm 21,7* h 2* 21,7 8 1/2" x h 3/4" x 8 1/2" inner 6 master 24 Piatto fondo Soup plate VW001230792 8000257422213 cm 23,5* h 3,7* 23,5 · cc 260 9 1/4" x h 1 1/2" x 9 1/4" · 8 3/4 oz. inner 6 master 24 Piatto dessert Dessert plate VW002210792 8000257422237 cm 21,7* h 2* 21,7 8 1/2" x h 3/4" x 8 1/2" inner 6 master 24 Piatto fondo Soup plate VW001230000 8000257284637 cm 23,5* h 3,7* 23,5 · cc 260 9 1/4" x h 1 1/2" x 9 1/4" · 8 3/4 oz. inner 12 master Piatto dessert Dessert plate VW002210000 8000257267029 cm 21,7* h 2* 21,7 8 1/2" x h 3/4" x 8 1/2" inner 12 master Piatto fondo Soup plate VW001230841 8000257422039 cm 23,5* h 3,7* 23,5 · cc 260 9 1/4" x h 1 1/2" x 9 1/4" · 8 3/4 oz. inner 6 master 24 Piatto dessert Dessert plate VW002210841 8000257422060 cm 21,7* h 2* 21,7 8 1/2" x h 3/4" x 8 1/2" inner 6 master 24 0000 · White-Bianco 0000 · White-Bianco 0792 · Powder pink-Rosa cipria 0792 · Powder pink-Rosa cipria 0772 · London smoke-Grigio Londra 0772 · London smoke-Grigio Londra 0841 · Sage green-Verde salvia 0841 · Sage green-Verde salvia Piatto piano Dinner plate VW000280000 8000257578569 cm 28* h 2,8* 28 11" x h 1" x 11" inner 6 master 12 Piatto pane Bread plate VWT03150000 8056444391244 cm 15,5* h 1,7* 15,5 6" x h 3/4" x 6" inner 12 master 72 Piatto pane Bread plate VWT03150772 8056444391268 cm 15,5* h 1,7* 15,5 6" x h 3/4" x 6" inner 12 master 72 Piatto pane Bread plate VWT03150841 8056444391251 cm 15,5* h 1,7* 15,5 6" x h 3/4" x 6" inner 12 master 72 Piatto pane Bread plate VWT03150792 8056444391275 cm 15,5* h 1,7* 15,5 6" x h 3/4" x 6" inner 12 master 72 Piatto piano Dinner plate VW000280772 8000257421681 cm 28* h 2,8* 28 11" x h 1" x 11" inner 6 master 12 Piatto piano Dinner plate VW000280792 8000257422107 cm 28* h 2,8* 28 11" x h 1" x 11" inner 6 master 12 Piatto piano Dinner plate VW000280841 8000257422022 cm 28* h 2,8* 28 11" x h 1" x 11" inner 6 master 12 159
ITALY
IN

























160 Insalatiera Salad bowl VW024250000 8000257267128 cm 24,7* h 6,5* 24,7 · cc 1110 9 3/4" x h 2 1/2" x 9 3/4" · 37 1/2 oz. inner 6 master Insalatiera Salad bowl VW024250772 8000257443867 cm 24,7* h 6,5* 24,7 · cc 1110 9 3/4" x h 2 1/2" x 9 3/4" · 37 1/2 oz. inner 1 master Insalatiera Salad bowl VW024250792 8000257444444 cm 24,7* h 6,5* 24,7 · cc 1110 9 3/4" x h 2 1/2" x 9 3/4" · 37 1/2 oz. inner 1 master Insalatiera Salad bowl VW024250841 8000257445670 cm 24,7* h 6,5* 24,7 · cc 1110 9 3/4" x h 2 1/2" x 9 3/4" · 37 1/2 oz. inner 1 master Ovale piano Oval plate VW020300000 8000257267081 cm 31,5* h 3,5* 21 12 1/2" x h 1 1/2" x 8 1/4" inner 6 master Ovale piano Oval plate VW020350000 8000257284682 cm 35* h 4* 23 13 3/4" x h 1 1/2" x 9" inner 6 master Ovale piano Oval plate VW020400000 8000257284699 cm 40* h 4,5* 26 15 3/4" x h 1 3/4" x 10 1/4" inner 6 master Insalatiera Salad bowl VW024200772 8000257443850 cm 20* h 7* 20 · cc 750 7 3/4" x h 2 3/4" x 7 3/4" · 25 1/4 oz. inner 6 master Insalatiera Salad bowl VW024200841 8000257445021 cm 20* h 7* 20 · cc 750 7 3/4" x h 2 3/4" x 7 3/4" · 25 1/4 oz. inner 6 master Rotondo piano Charger plate VW022310000 8000257284705 cm 31* h 2,8* 31 12 1/4" x h 1" x 12 1/4" inner 6 master 12 Rotondo piano Charger plate VW022310772 8000257421971 cm 31* h 2,8* 31 12 1/4" x h 1" x 12 1/4" inner 1 master
piano Charger plate VW022310792 8000257422282 cm 31* h 2,8* 31 12 1/4" x h 1" x 12 1/4" inner 1 master Rotondo piano Charger plate VW022310841 8000257422084 cm 31* h 2,8* 31 12 1/4" x h 1" x 12 1/4" inner 1 master Insalatiera Salad bowl VW024200000 8000257267111 cm 20* h 7* 20 · cc 750 7 3/4" x h 2 3/4" x 7 3/4" · 25 1/4 oz. inner 6 master Insalatiera
cm
7 3/4" x h 2 3/4" x 7 3/4"
25 1/4 oz. inner 6
6
inner
Rotondo
Salad bowl VW024200792 8000257444338
20* h 7* 20 · cc 750
·
master Piattino tè Tea saucer VW006160000 8000257526904 cm 15,6* h 2,6* 15,6
1/4" x h 1" x 6 1/4"
12 master 72
cm
12,4 5" x h 3/4" x 5" inner 12 master 96 Piatto piano Dinner plate VW000260000 8000257266992 cm 26,5* h 2,5* 26,5 10 1/2" x h 1" x 10 1/2" inner 12 master Tazza caffè Coffee cup VW015090000 8000257526973 cm 6,7* h 5,3* 8,6 · cc 80 2 3/4" x h 2" x 3 1/2" · 2 3/4 oz. inner 12 master 72
Fruit bowl VW004160000 8000257267036 cm 15,8* h 5* 15,8 · cc 220 6 1/4" x h 2" x 6 1/4" · 7 1/2 oz. inner 12 master 48 Tazza tè Tea cup VW016240000 8000257526997 cm 8,6* h 6,5* 11,2 · cc 205 3 1/2" x h 2 1/2" x 4 1/2" · 7 oz. inner 12 master 48 0000 · White-Bianco 0792 · Powder pink-Rosa cipria 0772 · London smoke-Grigio Londra 0841 · Sage green-Verde salvia 161 vecchio vienna MADE IN ITALY
Piattino caffè Coffee saucer VW005130000 8000257524467
12,4* h 2*
Coppetta
porcellana bianca durissima anti sbeccature per una collezione di articoli ideali per la ristorazione di grandi numeri very strong and anti-chipping white porcelain for a collection of items ideal for large-scale catering
















Piatto piano Dinner plate OP300260000 8000257962061 cm 26,4* h 2,9* 26,4 10 1/2" x h 1 1/4" x 10 1/2" inner 6 master 12 Piatto piano Dinner plate OP300280000 8000257962078 cm 28,7* h 3,4* 28,7 11 1/4" x h 1 1/4" x 11 1/4" inner 6 master 24 Piatto dessert Dessert plate OP302220000 8000257962108 cm 21,7* h 2,3* 21,7 8 1/2" x h 1" x 8 1/2" inner 6 master 36 Piatto pane Bread & butter plate OP303160000 8000257962115 cm 16* h 2* 16 6 1/4" x h 3/4" x 6 1/4" inner 12 master 36 Piatto fondo Soup plate OP301200000 8000257962085 cm 20,5* h 4* 20,5 · cc 450 8" x h 1 1/2" x 8" · 15 1/4 oz. inner 6 master 24 Piatto fondo Soup plate OP301230000 8000257962092 cm 24* h 4* 24 9 1/2" x h 1 1/2" x 9 1/2" inner 6 master 24 Ovale piano Oval plate OP320260000 8000257962207 cm 26* h 3,4* 19,5 10 1/4" x h 1 1/4" x 7 3/4" inner 6 master 12 Rotondo piano Charger plate OP322320000 8000257962238 cm 32* h 2,5* 32 12 1/2" x h 1" x 12 1/2" inner 6 master 12 Insalatiera Salad bowl OP324180000 8000257962252 cm 18* h 5,5* 18 · cc 450 7" x h 2 1/4" x 7" · 15 1/4 oz. inner 6 master 12 Coppetta Fruit bowl OP304150000 8000257962122 cm 15,5* h 4* 15,5 · cc 260 6" x h 1 1/2" x 6" · 8 3/4 oz. inner 6 master 24 163
opera









164 Piattino caffè Coffee saucer OP305120000 8000257962139 cm 12,6* h 1,8* 12,6 5" x h 3/4" x 5" inner 12 master 48 Tazza caffè Coffee cup OP315110000 8000257962177 cm 7,2* h 5,8* 9 · cc 105 2 3/4" x h 2 1/4" x 3 1/2" · 3 1/2 oz. inner 12 master 48 Piattino tè Tea saucer OP306160000 8000257962146 cm 16,6* h 2,5* 16,6 6 1/2" x h 1" x 6 1/2" inner 12 master 36 Tazza tè Tea cup OP316240000 8000257962184 cm 9,3* h 7* 11,5 · cc 230 3 3/4" x h 2 3/4" x 4 1/2" · 7 3/4 oz. inner 12 master 48 165 opera
porcellana bianca e stile classico per una forma compatta e studiata per la banchettistica e la ristorazione
white





and classic style for a compact shape designed for banquents and catering







166 Piatto piano Dinner plate OV000270000 8000257504193 cm 27* h 2* 27 10 3/4" x h 3/4" x 10 3/4" inner 6 master 12 Piatto dessert Dessert plate OV002190000 8000257504216 cm 19,5* h 2* 19,5 7 3/4" x h 3/4" x 7 3/4" inner 6 master 24 Piatto pane Bread plate OV003160000 8000257510965 cm 16* h 1,5* 16 6 1/4" x h 1/2" x 6 1/4" inner 6 master 24 Piatto fondo Soup plate OV001230000 8000257504209 cm 24* h 4* 24 · cc 340 9 1/2" x h 1 1/2" x 9 1/2" · 11 1/2 oz. inner 6 master 24 Coppetta Cereal bowl OV004160000 8000257510958 cm 15* h 4* 15 · cc 290 6" x h 1 1/2" x 6" · 9 3/4 oz. inner 6 master 24 Rotondo piano Charger plate OV022310000 8000257510873 cm 32* h 2* 32 12 1/2" x h 3/4" x 12 1/2" inner 1 master 12 Insalatiera Salad bowl OV024200000 8000257510934 cm 20,5* h 5,5* 20,5 · cc 760 8" x h 2 1/4" x 8" · 25 3/4 oz. inner 6 master 24 Insalatiera Salad bowl OV024260000 8000257510941 cm 25,5* h 7* 25,5 · cc 1540 10" x h 2 3/4" x 10" · 52 oz. inner 1 master 6 167 ouverture
porcelain













168 Tazza caffè impilabile Stackable coffee cup OV015080000 8000257510989 cm 6,7* h 5* 8,5 · cc 80 2 3/4" x h 2" x 3 1/4" · 2 3/4 oz. inner 6 master 24 Tazza tè impilabile Stackable tea cup OV016210000 8000257511016 cm 8,5* h 6,3* 10,7 · 210 3 1/4" x h 2 1/2" x 4 1/4" · 7 oz. inner 6 master 24 Piattino caffè Coffee saucer OV005120000 8000257510972 cm 12* h 1,7* 12 · 4 3/4" x h 3/4" x 4 3/4" · inner 6 master 24 Piattino té Tea saucer OV006150000 8000257511009 cm 15* h 2,2* 15 6" x h 3/4" x 6" inner 6 master 24 Piattino brodo Soup saucer OV008180000 8000257511047 cm 18,7* h 1,7* 18,7 7 1/4" x h 3/4" x 7 1/4" inner 6 master 24 Tazza brodo Soup cup OV018360000 8000257511054 cm 11* h 6,3* 15,5 · cc 330 4 1/4" x h 2 1/2" x 6" · 11 1/4 oz. inner 6 master 24 169 ouverture

timeless
cinzia
il piatto pizza in porcellana super resistente in varie tonalità e decori

the super resistant porcelain pizza plate in various shades and decorations



MADE IN ITALY
CI022350000


8000257169163
cm 35,5* h 2* 35,5
14" x h 3/4" x 14"
CI022410000
8000257189086
cm 32,4* h 2,2* 32,4
12 3/4" x h 3/4" x 12 3/4"
CI022310000
8000257211893
cm 31* h 2,1* 31
12 1/4" x h 3/4" x 12 1/4"
CI022280000
8000257033389
cm 29* h 2* 29
11 1/2" x h 3/4" x 11 1/2"
Rotondo pizza
Pizza plate
Rotondo pizza
Pizza plate
Rotondo pizza
Pizza plate
Rotondo pizza
Pizza plate
inner 6 master
inner 6 master
inner 6 master
inner 6 master
CIR2233AB44
8000257271651
cm 32,5* h 2,2* 32,5
12 3/4" x h 3/4" x 12 3/4"
Rotondo pizza
Pizza plate
inner 6 master
AB44 · Cuoio 173
az bianco & filo blu




da oltre cinquant'anni un classico senza tempo, bianco o filo blu in porcellana bianca made in Italy
for over fifty years a timeless classic white or blue ring in white porcelain made in Italy









MADE IN ITALY

174 Piatto piano Dinner plate AZ000240000 8000257005621 cm 25* h 3* 25 9 3/4" x h 1 1/4" x 5" inner 12 master Piatto piano Dinner plate AZ000260000 8000257005768 cm 26,3* h 3* 26,3 10 1/4" x h 1 1/4" x 10 1/4" inner 12 master Piatto fondo Soup plate AZ001180000 8000257005829 cm 18,5* h 5* 18,5 · cc 570 7 1/4" x h 2" x 7 1/4" · 19 1/4 oz. inner 12 master Piatto fondo Soup plate AZ001200000 8000257005881 cm 20,5* h 4,5* 20,5 · cc 540 8" x h 1 3/4" x 8" · 18 1/4 oz. inner 12 master
Dessert plate AZ002190000 8000257006154 cm 20* h 2,5* 20 7 3/4" x h 1" x 7 3/4" inner 12 master
piano Charger plate AZ022280000 8000257222486 cm 28* h 3* 28 11" x h 1 1/4" x 11" inner 6 master Insalatiera Salad bowl AZ024240000 8000257007212 cm 24,5* h 8,5* 24,5 · cc 1800 9 3/4" x h 3 1/4" x 9 3/4" · 60 3/4 oz. inner 6 master Piatto piano Dinner plate AZ000247420 8000257005669 cm 25* h 3* 25 9 3/4" x h 1 1/4" x 9 3/4" inner 12 master Piatto piano Dinner plate AZ000267420 8000257005799 cm 26,3* h 2* 26,3 10 1/4" x h 3/4" x 10 1/4" inner 12 master Piatto dessert Dessert plate AZ002197420 8000257006192 cm 20* h 2,5* 20 7 3/4" x h 1" x 7 3/4" inner 12 master Piatto fondo Soup plate AZ001207420 8000257005928 cm 20,5* h 4,5* 20,5 · cc 540 8" x h 1 3/4" x 8" · 18 1/4 oz. inner 12 master Piatto fondo Soup plate AZ001187420 8000257005850 cm 18,5* h 5* 18,5 · cc 570 7 1/4" x h 2" x 7 1/4" · 19 1/4 oz. inner 12 master Rotondo piano Charger plate AZ022287420 8000257007120 cm 28* h 3* 28 11" x h 1 1/4" x 11" inner 6 master Insalatiera Salad bowl AZ024247420 8000257007250 cm 24,5* h 8,5* 24,5 · cc 1800 9 3/4" x h 3 1/4" x 9 3/4" · 60 3/4 oz. inner 6 master 7420· Filo Blu 0000 · Bianco 175
Piatto dessert
Rotondo














176 Ovale piano Oval plate AZ020347420 8000257006833 cm 34* h 2,5* 22 13 1/2" x h 1" x 8 3/4" inner 6 master Ovale piano Oval plate AZ020267420 8000257006680 cm 26* h 2* 16 10 1/4" x h 3/4" x 6 1/4" inner 6 master Ovale piano Oval plate AZ020297420 8000257006765 cm 30* h 2* 20 11 3/4" x h 3/4" x 7 3/4" inner 6 master Ovale piano Oval plate AZ020260000 8000257006659 cm 26* h 2* 16 10 1/4" x h 3/4" x 6 1/4" inner 6 master Ovale piano Oval plate AZ020290000 8000257006734 cm 30* h 2* 20 11 3/4" x h 3/4" x 7 3/4" inner 6 master Ovale piano Oval plate AZ020340000 8000257006796 cm 34* h 2,5* 22 13 1/2" x h 1" x 8 3/4" inner 6 master Coppetta Fruit bowl AZ004157420 8000257006338 cm 16* h 4* 16 · cc 290 6 1/4" x h 1 1/2" x 6 1/4" · 9 3/4 oz. inner 12 master 48 Tazza caffè Coffee cup AZ015087420 8000257643618 cm 6,6* h 5,4* 8,5 · cc 95 2 1/2" x h 2 1/4" x 3 1/4" · 3 1/4 oz. inner 12 master 72 Piattino caffè Coffee saucer AZ005127420 8000257817507 cm 12,9* h 1,8* 12,9 5" x h 3/4" x 5" inner 12 master 72 Tazza tè Tea cup AZ016197420 8000257343372 cm 8,7* h 6,2* 11 · cc 210 3 1/2" x h 2 1/2" x 4 1/4" · 7 oz. inner 6 master 48 Piattino tè Tea saucer AZ006167420 8000257222936 cm 16,5* h 2* 16,5 6 1/2" x h 3/4" x 6 1/2" inner 12 master 48 Tazza colazione Breakfast cup AZ017337420 8000257643861 cm 10,6* h 6,5* 13 · cc 330 4 1/4" x h 2 1/2" x 5" · 11 1/4 oz. inner 6 master 24 Piattino colazione Breakfast saucer AZ007177420 8000257642765 cm 17,6* h 2,2* 17,6 7" x h 3/4" x 7" inner 12 master 36 7420· Filo Blu 0000 · Bianco 177 az bianco & filo blu MADE IN ITALY
forma







a falda e porcellana bianca ideale per essere personalizzata
and white porcelain ideal for customization








classic flat

MADE IN ITALY
178
piano Dinner plate AC000250000 8000257185248 cm 25,2* h 2,5* 25,2 10" x h 1" x 10" inner 12 master
piano Dinner plate AC000270000 8000257732749 cm 27* h 2* 27 10 3/4" x h 3/4" x 10 3/4" inner 12 master 24
dessert Dessert plate AC002210000 8000257733135 cm 21,2* h 2,2* 21,2 8 1/4" x h 3/4" x 8 1/4" inner 12 master Piatto fondo Soup plate AC001230000 8000257185255 cm 22,5* h 3,8* 22,5 · cc 280 8 3/4" x h 1 1/2" x 8 3/4" · 9 1/2 oz. inner 12 master Coppetta rettangolare Rectangular bowl AC004110000 8000257043173 cm 11* h 4* 7 4 1/4" x h 1 1/2" x 2 3/4" inner 12 master 48 Rotondo piano Charger plate AC022400000 8000257735320 cm 30* h 3* 30 11 3/4" x h 1 1/4" x 11 3/4" inner 6 master Tazza caffè impilabile Stackable coffee cup AC015080000 8000257228099 cm 6,5* h 4,5* 9 · cc 90 2 1/2" x h 1 3/4" x 3 1/2" · 3 oz. inner 12 master 72 Tazza caffè impilabile Stackable coffee cup AC015180000 8000257734453 cm 8* h 6* 10,5 · cc 185 3 1/4" x h 2 1/4" x 4 1/4" · 6 1/4 oz. inner 12 master 48
caffè Coffee saucer AC005120000 8000257228082 cm 11,6* h 1,8* 11,6 4 1/2" x h 3/4" x 4 1/2" inner 12 master 72 179 acapulco
Piatto
Piatto
Piatto
Piattino
classica
shape











Tazza tè impilabile Stackable tea cup AC016220000 8000257734521 cm 9* h 6* 11,5 · cc 250 3 1/2" x h 2 1/4" x 4 1/2" · 8 1/2 oz. inner 12 master 48 Tazza colazione impilabile Stackable breakfast cup AC017300000 8000257734637 cm 10,5* h 6,1* 13 · cc 325 4 1/4" x h 2 1/2" x 5" · 11 oz. inner 6 master 48 Piattino colazione * Breakfast saucer AC007160000 8000257733722 cm 16* h 2,3* 16 6 1/4" x h 1" x 6 1/4" inner 6 master 48 Tazza brodo impilabile Stackable soup cup AC018300000 8000257734750 cm 10,6* h 6* 15,5 · cc 325 4 1/4" x h 2 1/4" x 6" · 11 oz. inner 6 master 48 Piattino tè Tea saucer AC006150000 8000257733616 cm 14,4* h 2,1* 14,4 5 3/4" x h 3/4" x 5 3/4" inner 12 master 48 * * Utilizzabile con tazze AC0018300000 + AC017300000 fitting with cups AC0018300000 + AC017300000 181
MADE IN ITALY
acapulco
il piatto Trilogy una forma unica ed estremamente eclettica in porcellana bianca

a unique and extremely eclettic shape in white









182 Piatto piano Dinner plate TY000270000 8000257048468 cm 27* h 2* 27 10 3/4" x h 3/4" x 10 3/4" inner 12 master Piatto dessert Dessert plate TY002210000 8000257048475 cm 21* h 2,7* 21 8 1/4" x h 1" x 8 1/4" inner 12 master Rotondo piano Charger plate TY022320000 8000257048482 cm 31* h 2,5* 31 12 1/4" x h 1" x 12 1/4" inner 6 master Piatto piano ovale Oval dinner plate SB000260000 8000257152011 cm 27* h 3,3* 23,3 10 3/4" x h 1 1/4" x 9 1/4" inner 6 master 24 Piatto dessert ovale Oval dessert plate SB002230000 8000257152035 cm 23,1* h 3* 21 9" x h 1 1/4" x 8 1/4" inner 6 master Ovale grigliata Oval plate SB022300000 8000257467108 cm 30* h 3,9* 26 11 3/4" x h 1 1/2" x 10 1/4" inner 6 master 183
trilogy
the Trilogy plate
porcelain samba MADE IN ITALY MADE IN ITALY
caterer

ideale per la ristorazione commerciale robusto e leggero
ideal for commercial catering strong and light
da sempe presente classico o moderno in porcellana bianca con piccola falda
always present classic or modern in white porcelain with small rim
Dinner plate BC000250000 8000257132020 cm 25* h 3* 25 9 3/4" x h 1 1/4" x 9 3/4"





BC002200000 8000257013817 cm 20* h 2* 20 7 3/4" x h 3/4" x 7 3/4"
Piatto piano
inner 12 master 24
Piatto dessert
Dessert plate
inner 12 master 24
BC001210000 8000257132037 cm 20,5* h 4* 20,5 · cc 350
x h 1 1/2" x 8" · 11 3/4 oz.
Piatto fondo Soup plate

inner 12 master 24
CA000260000 8000257645445 cm 26,6* h 2,7* 26,6 10 1/2" x h 1" x 10 1/2"
CA000240000 8000257645025 cm 24,2* h 2,4* 24,2 9 1/2" x h 1" x 9 1/2"
CA002210000 8000257646381 cm 21* h 2 8" x h 1"
CA002190000





8000257739526
cm 19,6* h 2* 19,6 7 3/4" x h 3/4" x 7 3/4"
Piatto piano
Dinner plate
Piatto piano
Dinner plate
Piatto dessert
Dessert plate
Piatto dessert

Dessert plate
inner 12 master 18
inner 12 master 24
inner 12 master 24
inner 12 master 24
CA001200000 8000257732039
Fondina Soup plate
186
8"
cm 21* h 3,8* 21 · cc 520 8 1/4" x h 1 1/2" x 8 1/4" · 17 1/2 oz. inner 12 master 24 Piatto fondo Soup plate CA001210000 8000257645681 cm 21,5* h 4* 21,5 · cc 560 8 1/2" x h 1 1/2" x 8 1/2" · 19 oz. inner 12 master 24 Piatto pane Bread plate CA003150000 8000257646084 cm 16,2* h 2* 16,2 6 1/2" x h 3/4" x 6 1/2" inner 12 master 48 187
basic
capri













188 Rotondo piano Charger plate CA022290000 8000257653587 cm 28,5* h 2,9* 28,5 11 1/4" x h 1 1/4" x 11 1/4" inner 6 master Ovale piano Oval plate CA020350000 8000257653082 cm 34* h 2,5* 21 13 1/2" x h 1" x 8 1/4" inner 6 master Coppetta impilabile Stackable fruit bowl CA004110000 8000257739618 cm 11,3* h 5* 11,3 · cc 310 4 1/2" x h 2" x 4 1/2" · 10 1/2 oz. inner 12 master 48 Coppetta impilabile Stackable fruit bowl CA004130000 8000257646763 cm 13* h 5,5* 13 · cc 440 5" x h 2 1/4" x 5" · 15 oz. inner 6 master 48 Coppetta impilabile Stackable fruit bowl CA004150000 8000257647210 cm 15,3* h 6,6* 15,3 · cc 750 6" x h 2 1/2" x 6" · 25 1/4 oz. inner 12 master 48 Coppetta svasata Fruit bowl CA0S4140000 8000257644806 cm 14* h 3,7* 14 · cc 260 5 1/2" x h 1 1/2" x 5 1/2" · 8 3/4 oz. inner 12 master 96 Coppetta svasata Fruit bowl CA0S4160000 8000257739397 cm 16,3* h 4* 16,3 · cc 400 6 1/2" x h 1 1/2" x 6 1/2" · 13 1/2 oz. inner 6 master 48 Coppetta svasata Fruit bowl CA0S4180000 8000257644837 cm 18,3* h 5* 18,3 · cc 600 7 1/4" x h 2" x 7 1/4" · 20 1/4 oz. inner 12 master Insalatiera impilabile Stackable salad bowl CA024180000 8000257654157 cm 18* h 7* 18 · cc 1160 7" x h 2 3/4" x 7" · 39 1/4 oz. inner 6 master 24 Insalatiera impilabile Stackable salad bowl CA024210000 8000257654652 cm 21,5* h 8* 21,5 · cc 2120 8 1/2" x h 3 1/4" x 8 1/2" · 71 3/4 oz. inner 4 master 24 Insalatiera impilabile Stackable salad bowl CA024240000 8000257655109 cm 24* h 9,4* 24 · cc 2740 9 1/2" x h 3 3/4" x 9 1/2" · 92 3/4 oz. inner 6 master Insalatiera/calotta Salad bowl TE024140000 8000257436340 cm 24,8* h 6,7* 24,8 · cc 830 9 3/4" x h 2 3/4" x 9 3/4" · 28 oz. inner 6 master 189 capri













190 Piatto piano Dinner plate HA000230000 8056444047271 cm 22,8* h 2,8* 22,8 9" x h 1" x 9" inner 6 master 24 Piatto piano Dinner plate HA000250000 8056444047264 cm 25,2* h 2,7* 25,2 10" x h 1" x 10" inner 6 master 18 Piatto fondo Soup plate HA001200000 8056444047288 cm 20* h 4,5* 20 7 3/4" x h 1 3/4" x 7 3/4" inner 6 master 24 Piatto dessert Dessert plate HA002200000 8056444047295 cm 20,2* h 2,5* 20,2 8" x h 1" x 8" inner 6 master 24 Piattino tè Tea saucer HA006150000 8056444452433 cm 14,4* h 2,5* 5 3/4" x h 1" inner 6 master 48 Piattino caffè Coffee saucer HA005120000 8056444452372 cm 11,8* h 2,6* 11,8 4 3/4" x h 1" x 4 3/4" inner 6 master 48 Tazza tè impilabile Stackable tea cup HA016220000 8056444452402 cm 8,5* h 6,5* 11 · cc 220 3 1/4" x h 2 9/16" x 4 1/4" · 7 1/2 oz. inner 6 master 48 Tazza caffè impilabile Stackable coffee cup HA015080000 8056444452341 cm 6,5* h 5* 8,5 · cc 80 2 9/16" x h 2" x 3 1/4 “ · 2 3/4 oz. inner 6 master 48 Mug Mug HA014350000 8056444456806 cm 8,5* h 10* 11 · cc 330 3 1/4" x h 4" x 4 1/4 · 11 1/4 oz. inner 6 master 48 191 h-shape NEW 2024 NEW 2024 NEW 2024 NEW 2024 NEW 2024
accessorizes

trento




le insalatiere in porcellana the salad bowls in white porcelain

i piatti ovali in porcellana bianca ultra resistenti the oval plates in white porcelain super resistant





194 195 Insalatiera Salad bowl TR024270000 8000257932392 cm 27* h 9,5* 27 · cc 3400 10 3/4" x h 3 3/4" x 10 3/4" · 115 oz. inner 6 master Insalatiera Salad bowl TR024320000 8000257859248 cm 32,5* h 11* 32,5 · cc 4850 12 3/4" x h 4 1/4" x 12 3/4" · 164 oz. inner 6 master Insalatiera Salad bowl TR024170000 8000257182865 cm 17,2* h 6,2* 17,2 · cc 780 6 3/4" x h 2 1/2" x 6 3/4" · 26 1/4 oz. inner 6 master 24 Insalatiera Salad bowl TR024200000 8000257015736 cm 20* h 7,3* 20 · cc 1200 7 3/4" x h 2 3/4" x 7 3/4" · 40 1/2 oz. inner 6 master 24 Insalatiera Salad bowl TR024230000 8000257182872 cm 23* h 8* 23 · cc 2100 9" x h 3 1/4" x 9" · 71 oz. inner 6 master Ovale piano Oval plate AL020770000 8000257205571 cm 42* h 5,5* 28 16 1/2" x h 2 1/4" x 11" inner 2 master 6 Ovale piano Oval plate AL020750000 8000257205557 cm 34,6* h 5* 22,8 13 1/2" x h 2" x 9" inner 6 master Ovale piano Oval plate AL020760000 8000257205564 cm 38* h 5,4* 25,2 15" x h 2 1/4" x 10" inner 6 master 12 Ovale piano Oval plate AL020710000 8000257205519 cm 23,6* h 3,1* 15,7 · cc 80 9 1/4" x h 1 1/4" x 6 1/4" · 2 3/4 oz. inner 6 master 24 Ovale piano Oval plate AL020720000 8000257205526 cm 24,6* h 3,1* 17,5 · cc 110 9 3/4" x h 1 1/4" x 7" · 3 3/4 oz. inner 6 master 24 Ovale piano Oval plate AL020730000 8000257205533 cm 28,4* h 3,6* 18,8 · cc 120 11 1/4" x h 1 1/2" x 7 1/2" · 4 oz. inner 6 master 18 Ovale piano Oval plate AL020740000 8000257205540 cm 31,9* h 4,3* 21,7 · cc 170 12 1/2" x h 1 3/4" x 8 1/2" · 5 3/4 oz. inner 6 master 18
albergo
una serie unica di accessori in porcellana bianca a unique series of accessories in white porcelain

























196 197 Antipastiera Hors-d’oeuvre plate PY0AD110000 8000257142333 cm 27,5* h 2,5* 14 10 3/4" x h 1" x 5 1/2" inner 6 master 36 Antipastiera Hors-d’oeuvre plate PY0AD120000 8000257142340 cm 37* h 3* 19 14 1/2" x h 1 1/4" x 7 1/2" inner 6 master 24 Portaolive Olive boat PY0AD150000 8000257142371 cm 18* h 4,5* 7,5 7" x h 1 3/4" x 3" inner 6 master 72 Vassoio rettangolare Rectangular tray PY0AD230000 8000257161501 cm 28,8* h 1,8* 12,4 11 1/4" x h 3/4" x 5" inner 6 master 24 Vassoio rettangolare Rectangular tray PY0AD240000 8000257161518 cm 37,6* h 2,7* 15,4 14 3/4" x h 1" x 6" inner 6 master 24 Piatto party cm 27x22 Party plate 27x22 HH300270000 8000257180687 cm 28* h 2* 23,5 11" x h 1/2" x 9" inner 6 master 24 Piattino Saucer PY004080000 8000257236872 cm 8* h 2* 8 · cc 30 3 1/4" x h 3/4" x 3 1/4" · 1 oz. inner 24 master 288 Coppetta creme brulè Creme brulee bowl PY004120000 8000257251851 cm 12,5* h 3* 12,5 · cc 180 5" x h 1 1/4" x 5" · 6 oz. inner 12 master 48 Portauovo Egg cup PY046060000 8000257217673 cm 5,5* h 5,5* 5,5 2 1/4" x h 2 1/4" x 2 1/4" inner 12 master 96 Bolo tete de lion Tete de lion bowl PY068060000 8000257184869 cm 11* h 9,5* 15 · cc 580 4 1/4" x h 3 3/4" x 6" · 19 1/2 oz. inner 6 master 24 Bolo Bowl cm 14 BL068140000 8000257030111 cm 14 5 1/2" inner 6 master Ciotola quadra Square bowl PY0AD190000 8000257142425 cm 9* h 2,5* 9 · cc 50 3 1/2" x h 1" x 3 1/2" · 1 3/4 oz. inner 12 master 96 Ciotola triangolare Triangular bowl PY0AD200000 8000257142432 cm 10,6* h 3* 10,6 · cc 150 4 1/4" x h 1 1/4" x 4 1/4" · 5 oz. inner 12 master 96 Ciotola rettangolare impilabile stackable rectangular bowl RT004190000 8000257307527 cm 18* h 3,7* 11 · cc 300 7" x h 1 1/2" x 4 1/4" · 10 1/4 oz. inner 6 master 48 Ciotola quadra impilabile Stackable fruit bowl RT004130000 8000257307534 cm 12* h 4,5* 12 · cc 140 4 3/4" x h 1 3/4" x 4 3/4" · 4 3/4 oz. inner 6 master 48 party
Bolo




























198 199 Piatto ovale fonduta Oval fondue plate PY0AF570000 8000257184876 cm 28,7* h 2,8* 24 11 1/4" x h 1" x 9 1/2" inner 6 master 24 Antipastiera 4 impronte Hors d’oeuvre 4 sector PY0AH010000 8000257217888 cm 34,5* h 3* 13 13 1/2" x h 1 1/4" x 5" inner 6 master 24 Antipastiera 3 bowl Hors-d’oeuvre plate 3 sector PY0AF440000 8000257181158 cm 37* h 5,5* 12,5 · cc 280 14 1/2" x h 2 1/4" x 5" · 9 1/2 oz. inner 6 master 24 Antipastiera 3 bowl Hors-d’oeuvre plate 3 sector PY0AF990000 8000257217871 cm 24,2* h 3,5* 7,5 9 1/2" x h 1 1/2" x 3" inner 6 master 24 Mug impilabile Stackable mug RT017270000 8000257256030 cm 8* h 8* 10 · cc 270 3 1/4" x h 3 1/4" x 4" · 9 1/4 oz. inner 6 master 36 Piatto 4 scomparti ovale Oval 4-sector plate GU020340000 8000257788678 cm 34,5* h 3* 29 · 13 1/2" x x h 1 1/4" x 4 1/2" · inner 2 master 8 Bolo Bowl RT068140000 8000257307541 cm 13,5* h 7* 13,5 · cc 320 5 1/4" x h 2 3/4" x 5 1/4" · 10 3/4 oz. inner 6 master 48 Antipastiera ovale 3 scomparti Oval hors-d’oeuvre plate 3 sector PY0AF250000 8000257180908 cm 35,5* h 3,5* 9 14" x h 1 1/2" x 3 1/2" inner 6 master 24 Vassoio sushi Sushi tray PY0AH160000 8000257219837 cm 10* h 3* 6,5 4" x h 1 1/4" x 2 1/2" inner 12 master 72 Shape fruits S shaped deep plate PY0AD130000 8000257142357 cm 24* h 3,5* 10 9 1/2" x h 1 1/2" x 4" inner 6 master 48 Shape fruits S shaped deep plate PY0AD140000 8000257142364 cm 31* h 5* 13 · cc 400 12 1/4" x h 2" x 5" · 13 1/2 oz. inner 6 master 24 Rhombus plate Rhombus plate PY0AD170000 8000257142395 cm 21* h 2* 14,5 8 1/4" x h 3/4" x 5 3/4" inner 6 master 48
goccia Drop bowl PY0AF370000 8000257181080 cm 30* h 6* 20 · cc 1030 11 3/4" x h 2 1/4" x 7 3/4" · 34 3/4 oz. inner 6 master 24 Bolo barchetta Boat shaped bowl PY0AF170000 8000257180861 cm 36* h 9* 18 · cc 1180 14 1/4" x h 3 1/2" x 7" · 40 oz. inner 6 master 24 Bolo barchetta Boat shaped bowl PY0AF180000 8000257180878 cm 32* h 8* 15,8 · cc 770 12 1/2" x h 3 1/4" x 6 1/4" · 26 oz. inner 6 master 24 Bolo barchetta Boat shaped bowl PY0AF190000 8000257180885 cm 28,5* h 6,5* 13 · cc 500 11 1/4" x h 2 1/2" x 5" · 17 oz. inner 6 master 24 Contenitore ovale Oval slanting bowl PY0AF090000 8000257180786 cm 25* h 9* 17 · cc 460 9 3/4" x h 3 1/2" x 6 3/4" · 15 1/2 oz. inner 4 master 12 Portagrissini Baguette oval tray PY0AF240000 8000257180892 cm 36* h 3,5* 9,3 14 1/4" x h 1 1/2" x 3 3/4" inner 6 master 24 Vassoio quadrato Square tray PY0AH600000 8000257220444 cm 15*15 6" x 6" inner 6 master 48 Bolo goccia Drop bowl PY0AF380000 8000257181097 cm 26* h 5,2* 16,5 · cc 600 10 1/4" x h 2" x 6 1/2" · 20 1/4 oz. inner 6 master 24 Bolo goccia Drop bowl PY0AF390000 8000257181103 cm 20* h 4,5* 13 · cc 320 7 3/4" x h 1 3/4" x 5" · 10 3/4 oz. inner 6 master 24
un'infinita collezione di accessori in porcellana colore crema ideali per il finger food















200 201 Antipastiera esse S-shaped bowl MY0AN520000 8000257287355 cm 14* h 4,7* 10 · cc 145 5 1/2" x h 1 3/4" x 4" · 5 oz. inner 6 master 108 Antipastiera esse S-shaped bowl MY0AN530000 8000257287362 cm 11,6* h 3,6* 8 · cc 70 4 1/2" x h 1 1/2" x 3 1/4" · 2 1/4 oz. inner 6 master 216 Piatto quadro Square plate MY0AN540000 8000257287379 cm 12* h 2* 12 4 3/4" x h 3/4" x 4 3/4" inner 12 master 144
Rectangular bowl MY0AN570000 8000257287409 cm 10,5* h 4* 7,2 · cc 100 4 1/4" x h 1 1/2" x 2 3/4" · 3 1/2 oz. inner 8 master 192
Barchetta bowl MY0AN580000 8000257287416 cm 11,5* h 3,5* 10,5 · cc 110 4 1/2" x h 1 1/2" x 4 1/4" · 3 3/4 oz. inner 10 master 120 Piatto goccia Drop plate MY0AN630000 8000257287461 cm 15* h 1,6* 13,5 6" x h 3/4" x 5 1/4" inner 12 master 96 Bowl quadrangolare Quadrangular bowl MY0AN640000 8000257287478 cm 11,5* h 4,5* 10 · cc 240 4 1/2" x h 1 3/4" x 4" · 8 oz. inner 12 master 120 Bowl quadrangolare Quadrangular bowl MY0AN650000 8000257287485 cm 11,8* h 3* 10,6 · cc 100 4 3/4" x h 1 1/4" x 4 1/4" · 3 1/2 oz. inner 16 master 144
a goccia Drop plate MY0AN660000 8000257287492 cm 14* h 2,3* 13 5 1/2" x h 1" x 5" inner 12 master 96
a goccia Drop plate MY0AN670000 8000257287508 cm 16,2* h 2,3* 15,2 6 1/2" x h 1" x 6" inner 8 master 96
Coppetta rettangolare
Coppetta barchetta
Piatto
Piatto
miniparty
an
endless collection of accessories in creamy coloured porcelain ideal for finger food
Coppetta quadra Square bowl
Coppetta quadra Square bowl

Piatto quadro ala Square plate rimmed
Piatto quadro ala Square plate rimmed
MY0AN880000
8000257287713
cm 11* h 5* 8 · cc 100
4 1/4" x h 2"
Ciotola drop Drop bowl







Piatto
square Square plate


Piatto















Ciotola a goccia Drop bowl





202 203
MY0AN680000 8000257287515 cm 11* h 4,5*
cc 280 4 1/4" x h 1 3/4" x 4 1/4" · 9 1/2 oz. inner
master
11 ·
8
96
8000257287522 cm 9,3* h 3,5* 9,3 · cc 120 3 3/4" x h 1 1/2" x 3 3/4" · 4 oz. inner 12 master 144
MY0AN700000 8000257287539 cm 13,5* h 1,6* 13,5 5 1/4" x h 3/4" x 5 1/4" inner
master 144
MY0AN710000 8000257287546 cm 16,2* h 1,6* 16,2 6 1/2" x h 3/4" x 6 1/2" inner 12 master 72 Piatto
MY0AN720000 8000257287553 cm 15* h 1,5* 15 6" x h 1/2" x 6" inner
master 96
MY0AN690000
12
12
MY0AN730000 8000257287560 cm 13,8* h 4,2* 12,2 · cc 130 5 1/2" x h 1 3/4" x 4 3/4" · 4 1/2 oz. inner 10 master 80
a goccia Drop bowl MY0AN740000 8000257287577 cm 11* h 3,5* 9,5 · cc 75 4 1/4" x h 1 1/2" x 3 3/4" · 2 1/2 oz. inner 12 master 96
a goccia Drop bowl MY0AN750000 8000257287584 cm 8,5* h 3,3* 7,3 · cc 35 3 1/4" x h 1 1/4" x 2 3/4" · 1 1/4 oz. inner 18 master 144
Rectangular bowl MY0AN760000 8000257287591 cm 12,5* h 4* 10 · cc 80 5" x h 1 1/2" x 4" · 2 3/4 oz. inner 10 master 80 Ciotola
Rectangular bowl MY0AN770000 8000257287607 cm 9,7* h 3,5* 8 · cc 50 3 3/4" x h 1 1/2" x 3 1/4" · 1 3/4 oz. inner 12 master
Ciotola
Ciotola
Ciotola rettangolare
square
144
8000257287614 cm 13*
5" x h 3/4" x 4" inner
master
rettangolare Rectangular plate MY0AN780000
h 1,6* 10
16
192
MY0AN790000 8000257287621 cm 16* h 2* 12,4 6 1/4" x h 3/4" x 5" inner
master
rettangolare Rectangular plate
12
96
x 3 1/4" · 3 1/2 oz. inner 8 master 288
Drop bowl MY0AN890000 8000257287720 cm 14,2* h 5* 10,5 · cc 150 5 1/2" x h 2" x 4 1/4" · 5 oz. inner 8 master 128
Square bowl MY0AN920000 8000257287782 cm 14* h 4,3* 14 · cc 190 5 1/2" x h 1 3/4" x 5 1/2" · 6 1/2 oz. inner 10 master 80 Ciotola square Square bowl MY0AN930000 8000257287799 cm 11,5* h 4,5* 11,5 · cc 120 4 1/2" x h 1 3/4" x 4 1/2" · 4 oz. inner 10 master 120 Ciotola cuore alta Heart shaped bowl MY0AP010000 8000257287850 cm 10,5* h 5* 11 · cc 110 4 1/4" x h 2" x 4 1/4" · 3 3/4 oz. inner 8 master 192 Ciotola cuore bassa Heart shaped bowl MY0AP020000 8000257287867 cm 11* h 3* 10,4 · cc 50 4 1/4" x h 1 1/4" x 4" · 1 3/4 oz. inner 8 master 216 Ciotola quadra Square bowl MY0AN830000 8000257287669 cm 14* h 3* 14 · cc 130 5 1/2" x h 1 1/4" x 5 1/2" · 4 1/2 oz. inner 10 master 80 Ciotola a uovo Egg shaped bowl MY0AN860000 8000257287683 cm 13,5* h 5* 9,5 · cc 190 5 1/4" x h 2" x 3 3/4" · 6 1/2 oz. inner 8 master 96 Ciotola a uovo Egg shaped bowl MY0AN870000 8000257287706 cm 10* h 4* 8 4" x h 1 1/2" x 3 1/4" inner 8 master 192 Ciotola age Bowl age MY0AN970000 8000257287836 cm 12,2* h 2,8* 11,2 · cc 80 4 3/4" x h 1" x 4 1/2" · 2 3/4 oz. inner 12 master 288 Piatto a cuore Heart shaped plate MY0AP030000 8000257287874 cm 13,5* h 2,2* 13 · cc 50 5 1/4" x h 3/4" x 5" · 1 3/4 oz. inner 8 master 144
Ciotola drop
Ciotola square
































204 205
degustazione midi Midi spoon MY0AS130000 8000257330532 inner 24 master 288 cm 10,3* h 1,5* 5 4" x h 1/2" x 2" cm 12* h 2* 6 4 3/4" x h 3/4" x 2 1/4"
degustazione mini Mini spoon MY0AS140000 8000257330549 inner 36 master 432 Cucchiaio degustazione Spoon MY0AS370000 8000257365978 cm 10* h 3,5* 4 4" x h 1 1/2" x 1 1/2" inner 24 master 432 Vassoio goccia Drop tray MY0AS380000 8000257366005 cm 12,6* h 2,4* 8 5" x h 1" x 3 1/4" inner 24 master 192 Vassoio goccia Drop tray MY0AS390000 8000257366012 cm 14,8* h 2,6* 9,5 5 3/4" x h 1" x 3 3/4" inner 16 master 192
Cucchiaio
Cucchiaio
Rectangular tray MY0AP070000 8000257981895 cm 10* h 2,7* 6,5 4" x h 1" x 2 1/2" inner 12 master 96 Piatto quadro Small square plate MY0AY200000 8000257502397 cm 6* h 1,5* 6 2 1/4" x h 1/2" x 2 1/4" inner 24 master 144 Piatto rettangolare Rectangular plate MY0AY210000 8000257502403 cm 13* h 1,9* 6,6 5" x h 3/4" x 2 1/2" inner 12 master 144 Piatto rettangular Rectangular plate MY0AY220000 8000257502410 cm 28* h 2* 18 11" x h 3/4" x 7" inner 6 master 24 Cucchiaio fingerfood Spoon fingerfood MY0AY300000 8000257502588 cm 11* h 3* 5 4 1/4" x h 1 1/4" x 2" inner 24 master 288 Coppetta quadra Square bowl MY0AY230000 8000257502427 cm 10,7* h 4,7* 11,7 · cc 190 4 1/4" x h 1 3/4" x 4 1/2" · 6 1/2 oz. inner 12 master 96 Coppetta quadra Square bowl MY0AY240000 8000257502434 cm 11,8* h 5,3* 11,8 · cc 280 4 3/4" x h 2" x 4 3/4" · 9 1/2 oz. inner 12 master 72 Coppetta rettangolqre Rectangular bowl MY0AY250000 8000257502441 cm 10* h 3,8* 6,3 · cc 60 4" x h 1 1/2" x 2 1/2" · 2 oz. inner 12 master 144 Coppetta rettangolare Rectangular bowl MY0AY260000 8000257502458 cm 12* h 4,4* 8,2 · cc 140 4 3/4" x h 1 3/4" x 3 1/4" · 4 3/4 oz. inner 12 master 96 Coppetta rettangolare Rectangular bowl MY0AY270000 8000257502472 cm 15* h 5* 9,3 · cc 210 6" x h 2" x 3 3/4" · 7 oz. inner 12 master 72 Coppetta rotonda Round small bowl MY0AY280000 8000257502502 cm 6,5* h 4* 6,5 · cc 70 2 1/2" x h 1 1/2" x 2 1/2" · 2 1/4 oz. inner 24 master 144 Coppetta fingerfood Bowl fingerfood MY0AY290000 8000257502571 cm 10,7* h 3,6* 6,5 · cc 50 4 1/4" x h 1 1/2" x 2 1/2" · 1 3/4 oz. inner 24 master 192 Bolo Bowl EL068150000 8000257944685 cm 15* h 7 6" x h 4 1/4" inner 24 master 192
Small cylindric glass MY0AY310000 8000257502625 cm 3,5* h 5,6* 4,5 · cc 50 1 1/2" x h 2 1/4" x 1 3/4" · 1 3/4 oz. inner 24 master 144 Bottiglia per salsa di
Soja bottle MY0BTOL0000 8000257853697 cm 4,2* h 11* 6,6 · cc 90 1 3/4" x h 4 1/4" x 2 1/2" · 3 oz. inner 12 master 96 Poggiaposate Cutlery rest MY0POM90000 8056444224832 cm 8* h 1,20* 2,20 · inner 48 master 144
Vassoietto rettangolare
Bicchierino cilindrico
soia
FD1271A4746 8000257381886 cm 10,4* h 8* 14 · cc 200
x h 3 1/4" x 5 1/2" · 6 3/4 oz.
FD1271A0779 8000257443911 cm 10,4* h 8* 14 · cc 200
x h 3 1/4" x 5 1/2" · 6 3/4 oz.
FD1271A0000 8000257381473 cm 10,4* h 8* 14 · cc 200 4" x h 3 1/4" x 5 1/2" · 6 3/4 oz.









Mininova lory Mininova lori
Mininova lory Mininova lori
FD1271B4746



inner 1 master 24
inner 1 master 24
Mininova lory Mininova lori

inner 1 master 24
FD1271B0779 8000257443928 cm 10,3* h 8,5* 12,3 · cc 215
x h 3 1/4" x 4 3/4" · 7 1/4 oz.
FD1271B0000 8000257381480 cm 10,3* h 8,5* 12,3 · cc 215
x h 3 1/4" x 4 3/4" · 7 1/4 oz.
Mininova lizzy Mininova lizzy
Mininova lizzy Mininova lizzy
Mininova lizzy Mininova lizzy
inner 1 master 24
inner 1 master 24
206 207
4"
4"
4"
4"
8000257381893 cm 10,3* h 8,5* 12,3 · cc 215 4" x h 3 1/4" x 4 3/4" · 7 1/4 oz. inner 1 master 24 Mininova lexa Mininova lexa FD1271C0000 8000257381497 cm 12,7* h 9,5* 17 · cc 400 5" x h 3 3/4" x 6 3/4" · 13 1/2 oz. inner 1 master 16 Mininova lexa Mininova lexa FD1271C0779 8000257443935 cm 12,7* h 9,5* 17 · cc 400 5" x h 3 3/4" x 6 3/4" · 13 1/2 oz. inner 1 master 16 Mininova lexa Mininova lexa FD1271C4746 8000257381909 cm 12,7* h 9,5* 17 · cc 400 5" x h 3 3/4" x 6 3/4" · 13 1/2 oz. inner 1 master 16 0BIA · White-Bianco 0BIA · White-Bianco 4746 · Red-Rosso 4746 · Red-Rosso 0779 · Black-Nero 0779 · Black-Nero forno
dintorni
casseruole in porcellana colorata
bianca
casseroles
white porcelain
&
piccole
e
small
coloured and
mignon black





















208 209 Solo vassoio in legno compatibile con MO145210779 - MO145220779 Fitting with MO145210779 - MO145220779 Tegame rettangolare Rectangular baker MO145210779 8056444050707 cm 22* h 4,5* 13 · cc 560 8 3/4" x h 1 3/4" x 5" · 19 oz. inner 2 master 24 Tegame quadrato Square baker MO145190779 8056444050523 cm 15* h 4,3* 17,7 · cc 450 6" x h 1 3/4" x 7" · 15 1/4 oz. inner 2 master 24 Padellino rotondo Round pan MO104220779 8056444050769 cm 16* h 3* 21,7 · cc 250 6 1/4" x h 1 1/4" x 8 1/2" · 8 1/2 oz. inner 4 master 24 Padellino quadrato Square pan MO104210779 8056444050615 cm 22,5* h 3* 16 · cc 300 8 3/4" x h 1 1/4" x 6 1/4" · 10 1/4 oz. inner 4 master 24 Tegame rotondo Round baker MO145200779 8056444050745 cm 16,5* h 4* 19,2 · cc 780 6 1/2" x h 1 1/2" x 7 1/2" · 26 1/4 oz. inner 2 master 24 Coppetta Small cup MO104100779 8056444050783 cm 10* h 5* 11,5 · cc 220 4" x h 2" x 4 1/2" · 7 1/2 oz. inner 4 master 48 Tagliere rettangolare Rectangular wooden board MO8TA18LEGN 8056444124811 cm 26,5* h 1,5* 15 10 1/2" x h 1/2" x 6" inner 6 master 36 Vassoietto 3 scomparti 3-sector wooden tray MO83432LEGN 8056444124835 cm 32* h 1,2* 10,8 12 1/2" x h 1/2" x 4 1/4" inner 6 master 48 Piatto rettangolare Rectangular plate MO100240779 8056444060027 cm 24* h 2,5* 17 9 1/2" x h 1" x 6 3/4" inner 4 master 16 Tegame ovale Oval baker MO145220779 8056444050721 cm 22* h 4,5* 13,5 · cc 440 8 3/4" x h 1 3/4" x 5 1/4" · 15 oz. inner 2 master 24 *2 *1 *1 *2 *1 Solo vassoio in legno compatibile con MO104100779 Fitting with MO104100779
tegamini, padellini e piatti stoneware color nero effetto metallico black stoneware bakers, pans and plates with metallic effect
i piatti ovali in porcellana bianca the baking plates in white









210 211 Ovale forno Oval baking dish PL040250000 8000257191164 cm 25* h 5,2* 16,5 · cc 870 9 3/4" x h 2" x 6 1/2" · 29 1/2 oz. inner 1 master Ovale forno Oval baking dish PL040280000 8000257191157 cm 29* h 6* 18,3 · cc 1250 11 1/2" x h 2 1/4" x 7 1/4" · 42 1/4 oz. inner 1 master Ovale forno Oval baking dish PL040340000 8000257191140 cm 35* h 7* 21,5 · cc 2220 13 3/4" x h 2 3/4" x 8 1/2" · 75 oz. inner 1 master Ovale forno Oval baking dish PL040370000 8000257191133 cm 37* h 7,5* 24 · cc 3000 14 1/2" x h 3" x 9 1/2" · 101 1/2 oz. inner 1 master Rettangolare forno Rectangular baking dish PL041320000 8000257191096 cm 33* h 6,5* 24 · cc 2700 13" x h 2 1/2" x 9 1/2" · 91 1/4 oz. inner 1 master Rettangolare forno Rectangular baking dish PL041360000 8000257191102 cm 37* h 6,5* 25 · cc 3100 14 1/2" x h 2 1/2" x 9 3/4" · 104 3/4 oz. inner 1 master Ramequin costolato Ramequin PL042560000 8000257500386 cm 6* h 3,5* 6 · cc 40 2 1/4" x h 1 1/2" x 2 1/4" · 1 1/4 oz. inner 24 master 288 Ramequin costolato Ramequin PL042580000 8000257500393 cm 8* h 4,5* 8 · cc 100 3 1/4" x h 1 3/4" x 3 1/4" · 3 1/2 oz. inner 24 master 144 Ramequin costolato Ramequin PL042600000 8000257500409 cm 10* h 5,6* 10 · cc 220 4" x h 2 1/4" x 4" · 7 1/2 oz. inner 12 master 72 Tortiera Quiche dish PL044260000 8000257493763 cm 26* h 5,5* 26 · cc 1550 10 1/4" x h 2 1/4" x 10 1/4" · 52 1/2 oz. inner 1 master
pl-cook
porcelain MADE IN ITALY

















212 213 Piastra quadra Square tablet slate R390220ARDE 8000257669526 cm 20* h 0,5* 20 7 3/4" x h 1/4" x 7 3/4" inner 4 master 24 Piastra quadra Square tablet slate R392231ARDE 8000257669489 cm 30* h 0,5* 30 11 3/4" x h 1/4" x 11 3/4" inner 4 master 12 Piastra rotonda Round tablet slate R392230ARDE 8000257669502 cm 30* h 0,5* 30 11 3/4" x h 1/4" x 11 3/4" inner 4 master 12 Piastra rettangolare Rectangular tablet slate R392030ARDE 8000257669540 cm 30* h 0,5* 20 11 3/4" x h 1/4" x 7 3/4" inner 4 master 12 Piastra rettangolare Rectangular table slate R392038ARDE 8000257709925 cm 38* h 0,5* 26 15" x h 1/4" x 10 1/4" inner 4 master 8 Vassoio Tray R3934B1ARDE 8000257543529 cm 26* h 0,5* 15 10 1/4" x h 1/4" x 6" inner 6 master 24 Set 3 piatti quadri 3-square plate set R39AS33ARDE 8000257542911 cm 15* h 0,5* 15 6" x h 1/4" x 6" inner 8 master 16 Set 3 piatti tondi 3-round plate set R39AT42ARDE 8000257543017 cm 15* h 0,5* 15 6" x h 1/4" x 6" inner 8 master 16 Vassoio Tray R3934B2ARDE 8000257543352 cm 36* h 0,5* 13 14 1/4" x h 1/4" x 5" inner 6 master 18 Vassoio Tray R3934B3ARDE 8000257543222 cm 53* h 0,5* 16 20 3/4" x h 1/4" x 6 1/4" inner 6 master 12 olly la pietra naturale the natural stone
coffee & more

una collezione unica di tazze e accessori per il bar in porcellana bianca, crema e colorata
a unique collection of cups and accessories for the bar in white, creamy and coloured porcelain
Piattino the Tea saucer
Piattino the Tea saucer
Piattino the Tea saucer































216 217
AL015110780 8056444218411 cm
2 1/2"
oz. inner
AL015110798 8000257754321 cm 6,2* h 5,5* 7,7
80 2 1/2" x h 2 1/4"
3" · 2 3/4 oz. inner
72 Tazza
Coffee
AL015110801 8056444218596 cm 6,2* h 5,5* 7,7 · cc 80 2 1/2" x h 2 1/4" x 3" · 2 3/4 oz. inner
AL015110846 8056444218350 cm 6,2* h 5,5* 7,7
cc 80 2 1/2" x h 2 1/4" x 3" · 2 3/4 oz. inner
master 72
Tazza caffè Coffee cup
6,2* h 5,5* 7,7 · cc 80
x h 2 1/4" x 3" · 2 3/4
12 master 72 Tazza caffè Coffee cup
· cc
x
12 master
caffè
cup
12 master 72 Tazza caffè Coffee cup
·
12
cm
h 2* 12 4 3/4" x h 3/4" x 4 3/4" inner
Piattino caffè Coffee saucer AL005140780 8056444218381
12*
12 master 72
cm
12 4 3/4" x h 3/4" x 4 3/4" inner 12 master 72 Piattino caffè Coffee saucer AL005140801 8056444218541 cm 12* h 2* 12 4 3/4" x h 3/4" x 4 3/4" inner 12 master 72 Piattino caffè Coffee saucer AL005140846 8056444218329 cm 12* h 2* 12 · 4 3/4" x h 3/4" x 4 3/4" inner 12 master 72
the Tea cup AL016190780 8056444218435 cm 8,7* h 6* 11 · cc 200 3 1/2" x h 2 1/4" x 4 1/4" · 6 3/4 oz. inner 12 master 48 Tazza the Tea cup AL016190798 8000257725833 cm 8,7* h 6* 11 · cc 200 3 1/2" x h 2 1/4" x 4 1/4" · 6 3/4 oz. inner 12 master 48 Tazza the Tea cup AL016190801 8056444218602 cm 8,7* h 6* 11 · cc 200 3 1/2" x h 2 1/4" x 4 1/4" · 6 3/4 oz. inner 12 master 48
Tea cup AL016190846 8056444218367 cm 8,7* h 6* 11 · cc 200 3 1/2" x h 2 1/4" x 4 1/4" · 6 3/4 oz. inner 12 master 48
Piattino caffè Coffee saucer AL005140798 8000257755946
12* h 2*
Tazza
Tazza the
AL006140780 8056444218398 cm 14* h 2* 14 5 1/2"
Piattino the Tea saucer
x h 3/4" x 5 1/2" inner 12 master 48
cm
5
AL006140798 8000257755960
14* h 2* 14
1/2" x h 3/4" x 5 1/2" inner 12 master 48
AL006140801
cm 14* h 2*
5 1/2" x h 3/4"
5
inner
8056444218565
14
x
1/2"
12 master 48
cm 14* h 2* 14 5 1/2" x h 3/4" x 5 1/2" inner 12 master 48 0780 · Orange-Arancio 0780 · Orange-Arancio 0798 · Red-Rosso 0798 · Red-Rosso 0801 · Yellow-Giallo 0801 · Yellow-Giallo 0846 · Blue-Blu 0846 · Blue-Blu Tazza colazione Breakfast cup AL017270780 8056444218442 cm 10,9* h 6,8* 13 · cc 340 4 1/4" x h 2 3/4" x 5" · 11 1/2 oz. inner 6 master 48 Tazza colazione Breakfast cup AL017270798 8000257754383 cm 10,9* h 6,8* 13 · cc 340 4 1/4" x h 2 3/4" x 5" · 11 1/2 oz. inner 6 master 48 Tazza colazione Breakfast cup AL017270801 8056444218619 cm 10,9* h 6,8* 13 · cc 340 4 1/4" x h 2 3/4" x 5" · 11 1/2 oz. inner 6 master 48 Tazza colazione Breakfast cup AL017270846 8056444218374 cm 10,9* h 6,8* 13 · cc 340 4 1/4" x h 2 3/4" x 5" · 11 1/2 oz. inner 6 master 48 Piattino colazione Breakfast saucer AL007170780 8056444218404 cm 16* h 2* 14 6 1/4" x h 3/4" x 5 1/2" inner 6 master 48 Piattino colazione Breakfast saucer AL007170798 8000257075891 cm 16* h 2* 14 6 1/4" x h 3/4" x 5 1/2" inner 6 master 48 Piattino colazione Breakfast saucer AL007170801 8056444218589 cm 16* h 2* 14 6 1/4" x h 3/4" x 5 1/2" inner 6 master 48 Piattino colazione Breakfast saucer AL007170846 8056444218343 cm 16* h 2* 14 6 1/4" x h 3/4" x 5 1/2" inner 6 master 48 albergo
AL006140846 8056444218336


















218 219 Tazza caffè Coffee cup AL015110000 8000257230450 cm 6,2* h 5,5* 7,7 · cccc 80 2 1/2" x h 2 1/4" x 3" · 2 3/4 oz. inner 12 master 72 Tazza tè Tea cup AL016190000 8000257208213 cm 8,7* h 6* 11 · cc cc 200 3 1/2" x h 2 1/4" x 4 1/4" · 6 3/4 oz. inner 12 master 48 Piattino caffè Coffee saucer AL005140000 8000257226071 cm 12* h 2* 12 4 3/4" x h 3/4" x 4 3/4" inner 12 master 72 Piattino tè Tea saucer AL006140000 8000257208152 cm 14* h 2* 14 5 1/2" x h 3/4" x 5 1/2" inner 12 master 48 Piattino colazione Breakfast saucer AL007170000 8000257754789 cm 16* h 2* 14 6 1/4" x h 3/4" x 5 1/2" inner 6 master 48 Tazza colazione Breakfast cup AL017270000 8000257754956 cm 10,9* h 6,8* 13 · cc cc 340 4 1/4" x h 2 3/4" x 5" · 11 1/2 oz. inner 6 master 48 Piattino caffè Coffee saucer SC305130000 8000257028101 cm 12,8* h 1,5* 12,8 5" x h 1/2" x 5" inner 12 master 48 Piattino tè Tea saucer SC306160000 8000257028118 cm 16* h 2* 16 6 1/4" x h 3/4" x 6 1/4" inner 12 master 48 Tazza caffè s/piattino Coffee cup SC315100000 8000257028149 cm 7,2* h 6* 9,5 · cc 100 2 3/4" x h 2 1/4" x 3 3/4" · 3 1/2 oz. inner 12 master 48 Tazza tè s/piattino Tea cup SC316210000 8000257028156 cm 9,5* h 6,8* 11,7 · cc 195 3 3/4" x h 2 3/4" x 4 1/2" · 6 1/2 oz. inner 12 master 48
scala













220 221 Tazza caffè Coffee cup VS015100000 8000257028200 cm 6* h 6* 8 · cc 65 2 1/4" x h 2 1/4" x 3 1/4" · 2 1/4 oz. inner 12 master 72 Tazza tè Tea cup VS016200000 8000257028217 cm 8,8* h 7,2* 11 · cc 215 3 1/2" x h 2 3/4" x 4 1/4" · 7 1/4 oz. inner 12 master 48 Piattino caffè Coffee saucer VS005120000 8000257028163 cm 11,8* h 1,8* 11,8 4 3/4" x h 3/4" x 4 3/4" inner 12 master 72 Piattino tè Tea saucer VS006150000 8000257028170 cm 14* h 2* 14 5 1/2" x h 3/4" x 5 1/2" inner 12 master 48 Teiera Tea pot VS033030000 8000257665849 cm 10* h 9,5* 15,5 · cc 270 4" x h 3 3/4" x 6" · 9 1/4 oz. inner 6 master 24 Teiera Tea pot VS033050000 8000257665863 cm 12* h 10* 18 · cc 550 4 3/4" x h 4" x 7" · 18 1/2 oz. inner 6 master 24 Lattiera Milk jug VS032250000 8000257455235 cm 8* h 10* 11 · cc 275 3 1/4" x h 4" x 4 1/4" · 9 1/4 oz. inner 6 master 24 Lattiera Milk jug VS032510000 8000257455396 cm 10* h 12* 14 · cc 550 4" x h 4 3/4" x 5 1/2" · 18 1/2 oz. inner 6 master 24 Lattiera Milk jug VS032750000 8000257455556 cm 11,5* h 14,5* 17,6 · cc 850 4 1/2" x h 5 3/4" x 7" · 28 3/4 oz. inner 6 master 24 Lattiera Milk jug VS032990000 8000257455716 cm 12,5* h 15,7* 18,5 · cc 1160 5" x h 6 1/4" x 7 1/4" · 39 1/4 oz. inner 6 master 12 Lattiera Milk jug VS032050000 8000257454924 cm 4,7* h 5,7* 7 · cc 55 1 3/4" x h 2 1/4" x 2 3/4" · 1 3/4 oz. inner 6 master 144 Lattiera Milk jug VS032110000 8000257455068 cm 6* h 7,5* 8,8 · cc 115 2 1/4" x h 3" x 3 1/2" · 4 oz. inner 6 master 72 vesuvio

















222 223 Tazza caffè luzia Coffee cup luzia SU015080000 8000257664880 cm 6* h 5* 8,3 · cc 90 2 1/4" x h 2" x 3 1/4" · 3 oz. inner 6 master 192 Tazza tè luzia Tea cup luzia SU016180000 8000257664996 cm 8* h 6,8* 10,5 · cc 200 3 1/4" x h 2 3/4" x 4 1/4" · 6 3/4 oz. inner 6 master 96 Piattino caffè luzia Coffee saucer luzia SU005110000 8000257664347 cm 12,3* h 1,8* 12,3 4 3/4" x h 3/4" x 4 3/4" inner 6 master 162 Piattino tè luzia Tea saucer luzia SU006140000 8000257664361 cm 14,5* h 2* 14,5 5 3/4" x h 3/4" x 5 3/4" inner 6 master 96 Piattino caffè julia Coffee saucer julia SU005120000 8000257664330 cm 12* h 1,8* 12 4 3/4" x h 3/4" x 4 3/4" inner 6 master 162 Tazza caffè julia Coffee cup julia SU015090000 8000257664910 cm 7,5* h 5,8* 9 · cc 115 3" x h 2 1/4" x 3 1/2" · 4 oz. inner 6 master 192 Tazza tè julia Tea cup julia SU016190000 8000257665047 cm 8,5* h 7,8* 10,5 · cc 210 3 1/4" x h 3" x 4 1/4" · 7 oz. inner 6 master 48 Piattino tè julia Tea saucer julia SU006150000 8000257664422 cm 15* h 2* 15 6" x h 3/4" x 6" inner 6 master 96 Mug ines Mug ines SU014350000 8000257664873 cm 9* h 10,5* 12,5 · cc 380 3 1/2" x h 4 1/4" x 5" · 12 3/4 oz. inner 6 master 48 sun creamy colour
Tazza
Piattino tè helia/ines Tea
Tazza
Piattino









Tazza
Tazza










224 225
SU015110000 8000257664958 cm 6,5* h 5,5* 85
cc 80 2 1/2" x h 2 1/4" x 33 1/2" · 2 3/4 oz. inner 6 master 108
caffè ines Coffee cup ines
·
cm 8* h 5,5* 9,5 · cc 100 3 1/4" x h 2 1/4" x 3 3/4" · 3 1/2 oz. inner 6 master 144
caffè helia Coffee cup helia SU015100000 8000257664934
8000257664354 cm 12,3* h 1,8* 12,3 4 3/4" x h 3/4" x 4 3/4" inner 6
108
caffè helia/ines Coffee saucer helia/ines SU005130000
master
cm 9* h 6,8* 11 · cc 225 3 1/2" x h 2 3/4" x 4 1/4" · 7 1/2 oz. inner 6 master 48
tè ines Tea cup ines SU016210000 8000257665122
helia SU016200000 8000257665054 cm 9,5* h 6,5* 11 · cc 180 3 3/4" x h 2 1/2" x 4 1/4" · 6 oz. inner 6 master 96
tè helia Tea cup
helia/ines SU006160000 8000257664446 cm 15* h 2* 15 6" x h 3/4" x 6" inner 6 master 96 Mug conico Conical mug IR614340000 8056444057607 cm 8,5* h 10* 11,5 · cc 300 3 1/4" x h 4" x 4 1/2" · 10 1/4 oz. inner 6 master 36 Mug cilindrico Cylindrical mug IR614350000 8056444057614 cm 8* h 10* 12 · cc 360 3 1/4" x h 4" x 4 3/4" · 12 1/4 oz. inner 6 master 36 Mug balky Balky mug IR614360000 8056444057621 cm 8* h 10,5* 11 · cc 330 3 1/4" x h 4 1/4" x 4 1/4" · 11 1/4 oz. inner 6 master 36 confezione min 6 pz 3 design assortiti min quantity 6 pcs 3 designs mix and match * iris
saucer
ET015070000
8000257184074
Tazza caffè mara Coffee cup mara cm 5,4* h 7,5* 7,3 · cc 70 2 1/4" x h 3" x 2 3/4" · 2 1/4 oz.







inner 6 master 48
ET016200000 8000257184913 cm 8* h 8,2* 10 · cc 190 3 1/4" x h 3 1/4" x 4" · 6 1/2 oz.

Tazza tè mara Tea cup mara
inner 6 master 48
ET005080000








8000257184890 cm 12,5* h 1,7* 12,5 5" x h 3/4" x 5"
Piattino caffè mara Coffee saucer mara

inner 6 master 72
ET006150000 8000257184906 cm 15,5* h 2,1* 15,5
x h 3/4" x 6"
Piattino tè mara Tea saucer mara
inner 6 master 48
ET005100000 8000257184104 cm 13,4* h 1,8* 13,4 5 1/4" x h 3/4" x 5 1/4"
ET005090000
8000257184067 cm 11,6* h 1,7* 11,6 4 1/2"
Piattino caffè francesca dec Saucer francesca
inner 6 master 72
Piattino caffè francesca dec Saucer francesca
Piattino
226 227
6"
x h 3/4" x 4 1/2" inner 6 master 72
tè
Tea saucer francesca ET006110000 8000257205366 cm 15* h 1,7* 12 6" x h 3/4" x 4 3/4" inner 6 master 72
francesca dec
Coffee cup francesca ET015130000 8000257398808 cm 7* h 6,5* 8,8 · cc 105 2 3/4" x h 2 1/2" x 3 1/2" · 3 1/2 oz. inner 6 master 72
Coffee cup francesca ET015080000 8000257184098 cm 6,3* h 5,7* 8,3 · cc 70 2 1/2" x h 2 1/4" x 3 1/4" · 2 1/4 oz. inner 6 master 72
Tea
ET016170000 8000257205397 cm 9,1* h 7,8* 11,4 · cc 220 3 1/2" x h 3" x 4 1/2" · 7 1/2 oz. inner 6 master 48 elegant
Tazza caffè francesca
Tazza caffè francesca
Tazza tè francesca
cup francesca













228 229 Lattiera Milk jug SP032050779 8000257500461 cm 5* h 4,9* 7,5 · cc 50 2" x h 2" x 3" · 1 3/4 oz. inner 12 master 216 Lattiera Milk jug SP032050000 8000257500478 cm 5* h 4,9* 7,5 · cc 50 2" x h 2" x 3" · 1 3/4 oz. inner 12 master 216 Lattiera Milk jug SP032130000 8000257500539 cm 7* h 6* 10,5 · cc 130 2 3/4" x h 2 1/4" x 4 1/4" · 4 1/2 oz. inner 12 master 144 Lattiera Milk jug SP032130779 8000257500492 cm 7* h 6* 10,5 · cc 130 2 3/4" x h 2 1/4" x 4 1/4" · 4 1/2 oz. inner 12 master 144 Teiera Tea pot SP033250000 8000257500669 cm 7* h 7,5* 15,5 · cc 250 2 3/4" x h 3" x 6" · 8 1/2 oz. inner 1 master 36 Teiera Tea pot SP033470000 8000257500706 cm 8* h 10* 19 · cc 470 3 1/4" x h 4" x 7 1/2" · 16 oz. inner 1 master 24 Teiera Tea pot SP033250779 8000257500676 cm 7* h 7,5* 15,5 · cc 250 2 3/4" x h 3" x 6" · 8 1/2 oz. inner 1 master 36 Teiera Tea pot SP033470779 8000257500713 cm 8* h 10* 19 · cc 470 3 1/4" x h 4" x 7 1/2" · 16 oz. inner 1 master 24 0000 ·
0779 ·
sphere
White-Bianco
Black-Nero
melamina
una collezione ampia di articoli in melamina certificata per il buffet e per la ristorazione in varie forme e colori
a large collection of certified melamine items for buffets and restaurants in various shapes and colours











232 GREE · Green-Verde ORAN · Orange-ArancioneBLUE · Blue-Blu Vassoio rotondo Round tray S09VSB6ORAN 8056444462180 cm 32* h 3,5 12 1/2" x h 1 1/2" inner 6 master 18 Vassoio rotondo Round tray S09VSB6BLUE 8056444462197 cm 32* h 3,5 12 1/2" x h 1 1/2" inner 6 master 18 Vassoio rotondo Round tray S09VSB6GREE 8056444462203 cm 32* h 3,5 12 1/2" x h 1 1/2" inner 6 master 18 Vassoio rotondo Round tray S09VSB5ORAN 8056444462142 cm 40,5* h 5,5 16" x h 2 1/4" inner 4 master 12 Vassoio rotondo Round tray S09VSB5BLUE 8056444462159 cm 40,5* h 5,5 16" x h 2 1/4" inner 4 master 12 Vassoio rotondo Round tray S09VSB5GREE 8056444462166 cm 40,5* h 5,5 16" x h 2 1/4" inner 4 master 12 Alzata buffet Buffet stand S04ALR60NER 8056444463651 cm 31* 12 1/4" inner 1 master 4 * Adatto per 1 - 2 -3 Suitable with 1 - 2 - 3 * *1 *2 show plate glossy NEW 2024 NEW 2024













235 GREE · Green-Verde ORAN · Orange-ArancioneBLUE · Blue-Blu Bowl Bowl S096816ORAN 8056444462093 cm 16* h 6 · cc 570 6 1/4" x h 2 1/4" · 19 1/4 oz. inner 24 master 72 Bowl Bowl S096816BLUE 8056444462050 cm 16* h 6 · cc 570 6 1/4" x h 2 1/4" 19 1/4 oz. inner 24 master 72 Bowl Bowl S096816GREE 8056444462067 cm 16* h 6 · cc 570 6 1/4" x h 2 1/4" · 19 1/4 oz. inner 24 master 72 Coppetta Small bowl S0904A8ORAN 8056444462098 cm 8* h 3,5 · cc 66 3 1/4" x h 1 1/2" · 2 1/4 oz. inner 48 master 192 Coppetta Small bowl S0904A8BLUE 8056444462104 cm 8* h 3,5 · cc 66 3 1/4" x h 1 1/2" · 2 1/4 oz. inner 48 master 192 Coppetta Small bowl S0904A8GREE 8056444462111 cm 8* h 3,5 · cc 66 3 1/4" x h 1 1/2" · 2 1/4 oz. inner 48 master 192 Bowl Bowl S096819ORAN 8056444461992 cm 19* h 8 · cc 1000 7 1/2" x h 3 1/4" · 33 3/4 oz. inner 12 master 48 Bowl Bowl S096819BLUE 8056444462005 cm 19* h 8 · cc 1000 7 1/2" x h 3 1/4" 33 3/4 oz. inner 12 master 48 Bowl Bowl S096819GREE 8056444462012 cm 19* h 8 · cc 1000 7 1/2" x h 3 1/4" · 33 3/4 oz. inner 12 master 48 *3 show plate glossy NEW 2024 NEW 2024 NEW 2024
show plate barrel








237 NEW 2024 NEW 2024 NEW 2024 Bowl Wooden bowl S096814WOOD 8056444462272 cm 14* h 7 · cc 500 5 1/2" x h 2 3/4" · 17 oz. inner 24 master 72 Bowl Wooden bowl S096820WOOD 8056444462234 cm 20* h 10,5 · cc 1600 7 3/4" x h 4 1/4" · 54 oz. inner 6 master 24 Bowl Wooden bowl S096818WOOD 8056444462258 cm 18* h 8 · cc 950 7" x h 3 1/4" · 32 oz. inner 12 master 48
show plate


















marina & clay

239 Coppetta Small bowl S0904A8BRWR 8056444462814 cm 8,2* h 2,7 · cc 50 3 1/4" x h 1" · 1 3/4 oz. inner 12 master 144 Bowl Bowl S096812BRWR 8056444462883 cm 11,5* h 3,5 · cc 125 4 1/2" x h 1 1/2" · 4 1/4 oz. inner 24 master 96 Bowl Bowl S096814BRWR 8056444462944 cm 14,3* h 5,8 · cc 395 5 3/4" x h 2 1/4" · 13 1/3 oz. inner 12 master 72 Insalatiera Salad bowl S0924A0BRWR 8056444463019 cm 19,5* h 8* 19,5 · cc 1000 7 3/4" x h 3 1/4" x 7 3/4" · 33 3/4 oz. inner 6 master 24 Insalatiera Salad bowl S0924A1BRWR 8056444463088 cm 21,3* h 8,8* 21,3 · cc 1410 8 3/8" x h 3 1/2"x 8 3/8" · 49 6/8 oz. inner 4 master 32 Insalatiera Salad bowl S0924A4BRWR 8056444463156 cm 24* h 9,5* 24 · cc 1820 9 1/2" x h 3 3/4"x 9 1/2" · 61 1/2 oz. inner 4 master 24 Insalatiera Salad bowl S0924A1WHBR 8056444463095 cm 21,3* h 8,8* 21,3 · cc 1410 8 3/8" x h 3 1/2"x 8 3/8" · 49 6/8 oz. inner 4 master 32 Insalatiera Salad bowl S0924A4WHBR 8056444463163 cm 24* h 9,5* 24 · cc 1820 9 1/2" x h 3 3/4"x 9 1/2" · 61 1/2 oz. inner 4 master 24 Insalatiera Salad bowl S0924A0WHBR 8056444463026 cm 19,5* h 8* 19,5 · cc 1000 7 3/4" x h 3 1/4" x 7 3/4" · 33 3/4 oz. inner 6 master 24 Bowl Bowl S096814WHBR 8056444462951 cm 14,3* h 5,8 · cc 395 5 3/4" x h 2 1/4" · 13 1/3 oz. inner 12 master 72 Coppetta Small bowl S0904A8WHBR 8056444462821 cm 8,2* h 2,7 · cc 50 3 1/4" x h 1" · 1 3/4 oz. inner 12 master 144 Bowl Bowl S096812WHBR 8056444462890 cm 11,5* h 3,5 · cc 125 4 1/2" x h 1 1/2" · 4 1/4 oz. inner 24 master 96
WHBR · White and blue rim BRWR · Brown white rim NEW 2024 NEW 2024 NEW 2024 NEW 2024 NEW 2024 NEW 2024
show plate























241 Piatto rettangolare Rectangular tray S09PTD6BRWR 8056444463224 cm 26,5* h 4,5* 16,8 10 1/2" x h 1 3/4" x 6 1/2" inner 12 master 48 Piatto rettangolare Rectangular tray S09PTD7BRWR 8056444463293 cm 32,8* h 4,5* 23,8 13" x h 1 3/4" x 3 15/16" inner 6 master 24 Piatto rettangolare Rectangular tray S09PTD8BRWR 8056444463361 cm 39* h 3* 16,6 15 3/8" x h 1 1/4" x 6 1/2" inner 6 master 24 Piatto barca Leaf plate S09PB26BRWR 8056444463507 cm 25,5* h 5,5* 14,2 · cc 800 10" x h 2 1/4" x 5 1/2" · 28 2/10 oz. inner 10 master 60 Piatto barca Leaf plate S09PB36BRWR 8056444463576 cm 25,5* h 5,5* 14,2 · cc 1170 14 1/4" x h 7 3/8" x 5 1/2" · 41 1/4 oz. inner 6 master 24 Piatto barca Leaf plate S09PB36WHBR 8056444463583 cm 25,5* h 5,5* 14,2 · cc 1170 14 1/4" x h 7 3/8" x 5 1/2" · 41 1/4 oz. inner 6 master 24 Piatto barca Leaf plate S09PB26WHBR 8056444463514 cm 25,5* h 5,5* 14,2 · cc 800 10" x h 2 1/4" x 5 1/2" · 28 2/10 oz. inner 10 master 60 Piatto rettangolare Rectangular tray S09PTD9BRWR 8056444463439 cm 40* h 5,5* 30 15 3/4" x h 2 1/4" x 12" inner 6 master 12 Piatto rettangolare Rectangular tray S09PTD8WHBR 8056444463378 cm 39* h 3* 16,6 15 3/8" x h 1 1/4" x 6 1/2" inner 6 master 24 Piatto rettangolare Rectangular tray S09PTD9WHBR 8056444463446 cm 40* h 5,5* 30 15 3/4" x h 2 1/4" x 12" inner 6 master 12 Piatto rettangolare Rectangular tray S09PTD6WHBR 8056444463231 cm 26,5* h 4,5* 16,8 10 1/2" x h 1 3/4" x 6 1/2" inner 12 master 48 Piatto rettangolare Rectangular tray S09PTD7WHBR 8056444463309 cm 32,8* h 4,5* 23,8 13" x h 1 3/4" x 3 15/16" inner 6 master 24 WHBR · White and blue rim BRWR · Brown white rim
marina & clay NEW 2024 NEW 2024 NEW 2024 NEW 2024 NEW 2024 NEW 2024
show plate narciso & cefalù
lo stile della ceramica decorata per questi articoli in melamina ideali per il buffet


the "ceramic style" decorated melamine items for buffet








242 243 Vassoio ovale Oval tray S0934H4CEFA 8056444093179 cm 35,5* h 3* 25,5 14" x h 1 1/4" x 10" inner 9 master 36 Vassoio ovale Oval tray S0934H5CEFA 8056444093223 cm 48* h 3,3* 34 19" x h 1 1/4" x 13 1/2" inner 3 master 12 Vassoio ovale Oval tray S0934H4NARC 8056444093186 cm 35,5* h 3* 25,5 14" x h 1 1/4" x 10" inner 9 master 36 Vassoio ovale Oval tray S0934H5NARC 8056444093230 cm 48* h 3,3* 34 19" x h 1 1/4" x 13 1/2" inner 3 master 12 Vassoio ovale Oval tray S0934H6CEFA 8056444093278 cm 80* h 3,3* 56 31 1/2" x h 1 1/4" x 22" inner 1 master 4 Vassoio ovale Oval tray S0934H6NARC 8056444093285 cm 80* h 3,3* 56 31 1/2" x h 1 1/4" x 22" inner 1 master 4 Vassoio rotondo Round tray S0934L1NARC 8056444093339 cm 30,5* h 3,8* 30,5 12" x h 1 1/2" x 12" inner 9 master 36 Vassoio rotondo Round tray S0934L2NARC 8056444093384 cm 45* h 3,8* 45 17 3/4" x h 1 1/2" x 17 3/4" inner 5 master 10 Vassoio rotondo Round tray S0934L1CEFA 8056444093322 cm 30,5* h 3,8* 30,5 12" x h 1 1/2" x 12" inner 9 master 36 Vassoio rotondo Round tray S0934L2CEFA 8056444093377 cm 45* h 3,8* 45 17 3/4" x h 1 1/2" x 17 3/4" inner 5 master 10 Vassoio rotondo Round tray S0934L3CEFA 8056444093421 cm 60* h 3,8* 60 23 1/2" x h 1 1/2" x 23 1/2" inner 1 master 4 Vassoio rotondo Round tray S0934L4CEFA 8056444093476 cm 80* h 3,8* 80 31 1/2" x h 1 1/2" x 31 1/2" inner 1 master 3 Vassoio rotondo Round tray S0934L3NARC 8056444093438 cm 60* h 3,8* 60 23 1/2" x h 1 1/2" x 23 1/2" inner 1 master 4 Vassoio rotondo Round tray S0934L4NARC 8056444093483 cm 80* h 3,8* 80 31 1/2" x h 1 1/2" x 31 1/2" inner 1 master 3










244 245 Risottiera ovale Oval serve bowl S092134NARC 8056444137002 cm 23* h 6,5* 34 · cc 2200 9" x h 2,5 13 1/4" · 74,25 oz. inner 4 master 28 Risottiera ovale Oval serve bowl S092141NARC 8056444137064 cm 25* h 7,5* 40 · cc 3200 9 3/4" x h 2,75 15 3/4" · 108,25 oz. inner 4 master 20 Risottiera ovale Oval serve bowl S092134CEFA 8056444136999 cm 23* h 6,5* 34 · cc 2200 9" x h 2,5 13 1/4" · 74,25 oz. inner 4 master 28 Risottiera ovale Oval serve bowl S092141CEFA 8056444137071 cm 25* h 7,5* 40 · cc 3200 9 3/4" x h 2,75 15 3/4" · 108,25 oz. inner 4 master 20 Bowl rotonda Round bowl S0924A2NARC 8056444136869 cm 25* h 7,5* 25 · cc 1700 9 3/4" x h 2,75 9 3/4" · 57,5 oz. inner 4 master 24 Bowl rotonda Round bowl S092430NARC 8056444136920 cm 30* h 9* 30 · cc 1200 13 3/4" x h 3,5 13 3/4" · 108,25 oz. inner 4 master 16 Bowl rotonda Round bowl S0924A2CEFA 8056444136852 cm 25* h 7,5* 25 · cc 1700 9 3/4" x h 2,75 9 3/4" · 57,5 oz. inner 4 master 24 Bowl rotonda Round bowl S092430CEFA 8056444136937 cm 30* h 9* 30 · cc 3200 13 3/4" x h 3,5 13 3/4" · 108,25 oz. inner 4 master 16 show plate narciso
cefalù
&

















246 247 Vassoio ovale Oval tray S0934H50BLU 8056444164923 cm 48* 34 19" x 13 1/2" inner 3 master 12 Vassoio ovale Oval tray S0934H40BLU 8056444164862 cm 35,5* 25,5 14" x 10" inner 9 master 36 Vassoio ovale Oval tray S0934H50VER 8056444164930 cm 48* 34 19" x 13 1/2" inner 3 master 12 Vassoio ovale Oval tray S0934H40VER 8056444164879 cm 35,5* 25,5 14" x 10" inner 9 master 36 Vassoio ovale Oval tray S0934H50ARA 8056444164947 cm 48* 34 19" x 13 1/2" inner 3 master 12 Vassoio ovale Oval tray S0934H40ARA 8056444164886 cm 35,5* 25,5 14" x 10" inner 9 master 36 0VER · Green-Verde 0VER · Green-Verde 0ARA · Orange-Arancione 0ARA · Orange-Arancione 0BLU · Blue-Blu 0BLU · Blue-Blu Vassoio rotondo Round tray S0934L20BLU 8056444164831 cm 45 17 3/4" inner 5 master 10 Vassoio rotondo Round tray S0934L10BLU 8056444164893 cm 30 11 3/4" x h 3 1/2" inner 9 master 36 Vassoio rotondo Round tray S0934L10VER 8056444164916 cm 30 11 3/4" x h 3 1/2" inner 9 master 36 Vassoio rotondo Round tray S0934L20VER 8056444164848 cm 45 17 3/4" inner 5 master 10 Vassoio rotondo Round tray S0934L20ARA 8056444164855 cm 45 17 3/4" inner 5 master 10 Vassoio rotondo Round tray S0934L10ARA 8056444164909 cm 30 11 3/4" x h 3 1/2" inner 9 master 36 show plate colourful
































248 249 Vassoio ovale Oval tray S0920320BLU 8056444215632 cm 32* h 3* 22 12 1/2" x h 1 1/4" x 8 3/4" inner 6 master 48 Vassoio ovale Oval tray S0920320VER 8056444215670 cm 32* h 3* 22 12 1/2" x h 1 1/4" x 8 3/4" inner 6 master 48 Vassoio ovale Oval tray S0920320ARA 8056444215595 cm 32* h 3* 22 12 1/2" x h 1 1/4" x 8 3/4" inner 6 master 48 Vassoio ovale Oval tray S0920270BLU 8056444225525 cm 27* h 2,5* 18,5 10 3/4" x h 1" x 7 1/4" inner 6 master 48 Vassoio ovale Oval tray S0920270VER 8056444225532 cm 27* h 2,5* 18,5 10 3/4" x h 1" x 7 1/4" inner 6 master 48 Vassoio ovale Oval tray S0920270ARA 8056444225518 cm 27* h 2,5* 18,5 10 3/4" x h 1" x 7 1/4" inner 6 master 48 Vassoio ovale Oval tray S0920240BLU 8056444215625 cm 23,7* h 2,3* 16 9 1/4" x h 1" x 6 1/4" inner 6 master 48 Vassoio ovale Oval tray S0920240VER 8056444215663 cm 23,7* h 2,3* 16 9 1/4" x h 1" x 6 1/4" inner 6 master 48 Vassoio ovale Oval tray S0920240ARA 8056444215588 cm 23,7* h 2,3* 16 9 1/4" x h 1" x 6 1/4" inner 6 master 48 Vassoio ovale Oval tray S0920210VER 8056444215656 cm 21* h 2* 13,5 8 1/4" x h 3/4" x 5 1/4" inner 6 master 48 Vassoio ovale Oval tray S0920210ARA 8056444215571 cm 21* h 2* 13,5 8 1/4" x h 3/4" x 5 1/4" inner 6 master 48 Vassoio ovale Oval tray S0920210BLU 8056444215618 cm 21* h 2* 13,5 8 1/4" x h 3/4" x 5 1/4" inner 6 master 48 Vassoio ovale Oval tray S0920180BLU 8056444215601 cm 18,2* h 1,8* 11,2 7 1/4" x h 3/4" x 4 1/2" inner 6 master 120 Vassoio ovale Oval tray S0920180VER 8056444215649 cm 18,2* h 1,8* 11,2 · 7 1/4" x h 3/4" x 4 1/2" · inner 6 master 120 Vassoio ovale Oval tray S0920180ARA 8056444215564 cm 18,2* h 1,8* 11,2 · 7 1/4" x h 3/4" x 4 1/2" · inner 6 master 120 Insalatiera conica Salad bowl S0924210ARA 8056444216059 cm 20,5* h 7,5 8" x h1 3/4" inner 6 master 36 Insalatiera conica Salad bowl S0924210BLU 8056444216073 cm 20,5* h 7,5 8" x h1 3/4" inner 6 master 36 Insalatiera conica Salad bowl S0924210VER 8056444216097 cm 20,5* h 7,5 8" x h1 3/4" inner 6 master 36 Insalatiera conica Salad bowl S0924180ARA 8056444216042 cm 17,5* h 6,5 7" x h 2 1/2" inner 6 master 48 Insalatiera conica Salad bowl S0924160BLU 8056444215946 cm 15,5* h 5,8 6" x h 1 3/4" inner 6 master 60 Insalatiera conica Salad bowl S0924180VER 8056444216080 cm 17,5* h 6,5 7" x h 2 1/2" inner 6 master 48 Insalatiera conica Salad bowl S0924160ARA 8056444215939 cm 15,5* h 5,8 6" x h 1 3/4" inner 6 master 60 Insalatiera conica Salad bowl S0924180BLU 8056444216066 cm 17,5* h 6,5 7" x h 2 1/2" inner 6 master 48 Insalatiera conica Salad bowl S0924160VER 8056444215953 cm 15,5* h 5,8 6" x h 1 3/4" inner 6 master 60 0VER · Green-Verde 0VER · Green-Verde 0ARA · Orange-Arancione 0ARA · Orange-Arancione 0BLU · Blue-Blu 0BLU · Blue-Blu
show plate
S0934430NER 8000257642154 cm 43,5* h 2,8* 26,7 17 1/4" x h 1" x 10 1/2"




S0934380BIA 8000257641843 cm 38* h 2,7* 22,8 15" x h 1" x 9"



tray
Piatto rettangolare Rectangular tray
inner 6 master 12
inner 6 master 12
S0934320BIA




8000257641539
cm 32,5* h 2,3* 19,8 12 3/4" x h 1" x 7 3/4"
S0934320NER 8000257641683
cm 32,5* h 2,3* 19,8 12 3/4" x h 1" x 7 3/4"
Piatto rettangolare Rectangular tray
Piatto rettangolare Rectangular tray

inner 6 master 24
inner 6 master 24
251 Piatto
8000257643229 cm 70*
27 1/2"
inner 1 master 6 Piatto
Rectangular tray
8000257643533 cm 70* h
30 27 1/2"
inner 1 master 6 Piatto rettangolare Rectangular tray S0934750BIA 8000257643786 cm 75* h 2,7* 25 29 1/2" x h 1" x 9 3/4" inner 1 master 12 Piatto rettangolare Rectangular tray S0934750NER 8000257643908 cm 75* h 2,7* 25 29 1/2" x h 1" x 9 3/4" inner 1 master 12 Piatto rettangolare Rectangular plate S0934200NER 8000257648354 cm 20* h 2,4* 13,6 7 3/4" x h 1" x 5 1/4" inner 6 master 24 Piatto rettangolare Rectangular plate S0934250NER 8000257649092 cm 25* h 3* 17,3 9 3/4" x h 1 1/4" x 6 3/4" inner 6 master 24 Piatto rettangolare Rectangular plate S0934300NER 8000257649474 cm 30* h 2,8* 20,7 11 3/4" x h 1" x 8 1/4" inner 6 master 24 Piatto rettangolare Rectangular tray S0934380NER 8000257641904 cm 38* h 2,7* 22,8 15" x h 1" x 9" inner 6 master 12 Piatto rettangolare Rectangular tray S0934430BIA 8000257642062 cm 43,5* h 2,8* 26,7 17 1/4" x h 1" x 10 1/2" inner 6 master 12 Piatto rettangolare Rectangular
rettangolare Rectangular tray S0934700BIA
h 5* 30
x h 2" x 11 3/4"
rettangolare
S0934700NER
5*
x h 2" x 11 3/4"
0BIA · White-Bianco 0NER · Black-Nero
*1 Solo piatto rettangolare compatibile con S0924090BIA Fitting with S0924090BIA












252 Vassoio gn 1/1 Gn 1/1 tray S0934F10BIA 8056444018615 cm 53* h 1,7* 32,5 20 3/4" x h 3/4" x 12 3/4" inner 4 master 8 Vassoio gn 1/2 Gn 1/2 tray S0934F20BIA 8056444018639 cm 32,5* h 1,7* 26,5 12 3/4" x h 3/4" x 10 1/2" inner 6 master 12 Piatto rettangolare Rectangular plate S0900210BIA 8056444018592 cm 20* h 1,8* 27 7 3/4" x h 3/4" x 10 3/4" inner 6 master 36 Piatto quadro Square plate S0900200BIA 8056444018578 cm 20* h 1,8* 20 7 3/4" x h 3/4" x 7 3/4" inner 12 master 48 Piatto quadro Square plate S0900130BIA 8056444018554 cm 13,5* h 1,8* 13,5 5 1/4" x h 3/4" x 5 1/4" inner 12 master 96 Bowl quadro Square bowl S0924090BIA 8000257991467 cm 9,4* h 4,5* 9,4 · cc 150 3 3/4" x h 1 3/4" x 3 3/4" · 5 oz. inner 12 master 120
S0900300BIA 8000257991030 cm 27* h 1,7* 13,5 10 3/4" x h 3/4" x 5 1/4" inner 12 master 48 *
Vassoio gn 2/4 Gn 2/4 tray S0934M80BIA 8056444456684 cm 53* h 1,7* 16,2 20 3/4" x h 3/4" x 6 1/2" inner 6 master 12
plate NEW 2024
Piatto rettangolare Rectangular plate
show
18,2* h 1,8* 11,2 7 1/4" x h 3/4" x 4 1/2"
S0904250BIA 8000257732084
cm 25,3* h 10,5* 25,3 · cc 3010 10" x h 4 1/4" x 10" · 101 3/4 oz.
S0904210BIA 8000257732077
21,5* h 9* 21,5 · cc 1940
1/2" x h 3 1/2" x 8 1/2" · 65 1/2 oz.
S0904190BIA 8000257732060
cm 19,5* h 8* 19,5 · cc 1440
7 3/4" x h 3 1/4" x 7 3/4" · 48 3/4 oz.
Ciotola quadra Square bowl
Ciotola quadra Square bowl
Ciotola quadra Square bowl
inner 6 master 12
inner 6 master 24
inner 6 master 36
Ciotola quadra Square bowl S0904170BIA 8000257732053
17* h 7* 17 · cc 1000 6
x h 2
x 6 3/4" · 33 3/4 oz.
Ciotola quadra Square bowl
· 22 oz.
Ciotola quadra Square bowl
inner 6 master 48
inner 6 master 72
inner 6 master 96
inner 6 master 120
· 12 3/4 oz.
S0924290BIA









8000257640884
cm 29,4* h 10* 29,4 · cc 2900
11 1/2" x h 4" x 11 1/2" · 98 oz.
S0924250BIA
8000257640860
cm 25,3* h 9,5* 25,3 · cc 2000
10" x h 3 3/4" x 10" · 67 3/4 oz.
Bowl con piede Footed bowl








inner 1 master 12
Bowl con piede
Footed bowl
inner 6 master 24
Pirofila rettangolare Rectangular baking dish S0941370BIA



Pirofila rettangolare Rectangular baking dish
S0924170BIA
8000257640648
cm 17,5* h 7* 17,5 · cc 630
Bowl con piede
Footed bowl
254 255 Vassoio ovale Oval tray S0920390BIA 8000257638973 cm 39* h 3,5* 27 15 1/4" x h 1 1/2" x 10 3/4" inner 6 master 24 Vassoio ovale Oval tray S0920320BIA 8000257638775 cm 32* h 3* 22 12 1/2" x h 1 1/4" x 8 3/4" inner 6 master 24 Vassoio ovale Oval tray S0920270BIA 8000257638560 cm 27* h 2,5* 18,5 10 3/4" x h 1" x 7 1/4" inner 6 master 48 Vassoio ovale Oval tray S0920290BIA 8000257638652 cm 29,5* h 2,7* 20,3 11 1/2" x h 1" x 8" inner 6 master 48
Oval tray S0920210BIA 8000257637990 cm
h
13,5 8 1/4" x h 3/4" x 5 1/4" inner 6
Oval
S0920240BIA 8000257638430 cm 23,7* h 2,3* 16 9 1/4" x h 1" x 6 1/4" inner 6
S0920180BIA 8000257637518 cm
Vassoio ovale
21*
2*
master 48 Vassoio ovale
tray
master 48 Vassoio ovale Oval tray
cm
8
2
5"
S0904120BIA 8000257732015 cm 12,2* h 5,5* 12,5 · cc 380 4 3/4" x h
1/4" x
6"
S0904150BIA 8000257732046 cm 15* h 6,5* 15 · cc 650 6" x h 2 1/2" x
cm
3/4"
3/4"
7"
inner
x h 2 3/4" x 7" · 21 1/4 oz.
6 master 48
8000257640716 cm
8"
inner
8000257640792 cm
8
x h 3 3/4" x 8 3/4" · 43 oz. inner 6 master 36 Bowl obliqua Slanted bowl S0924360BIA 8000257637266 cm 35,5* h 13,7* 31,5 · cc 2300 14" x h 5 1/2" x 12 1/2" · 77 3/4 oz. inner 1 master 6 Bowl obliqua Slanted bowl S0924360NER 8000257637273 cm 35,5* h 13,7* 31,5 · cc 2300 14" x h 5 1/2" x 12 1/2" · 77 3/4 oz. inner 1 master 6 Bowl Bowl S0924350BIA 8000257636894 cm 35,5* h 14* 35,5 · cc 4400 14" x h 5 1/2" x 14" · 148 3/4 oz. inner 1 master 6 Bowl Bowl S0924350NER 8000257637181 cm 35,5* h 14* 35,5 · cc 4400 14" x h 5 1/2" x 14" · 148 3/4 oz. inner 1 master 6 Bowl con piede Footed bowl S0924110NER 8000257641096 cm 11,3* h 6* 11,3 · cc 280 4 1/2" x h 2 1/4" x 4 1/2" · 9 1/2 oz. inner 6 master 120 Bowl con piede Footed bowl S0924140NER 8000257641263 cm 13,8* h 7* 13,8 · cc 550 5 1/2" x h 2 3/4" x 5 1/2" · 18 1/2 oz. inner 6 master 48 Bowl con piede Footed bowl S0924190NER 8000257641515 cm 18,9* h 9,8* 18,9 · cc 1340 7 1/2" x h 3 3/4" x 7 1/2" · 45 1/4 oz. inner 6 master 24 Bowl con piede Footed bowl S0924230NER 8000257991481 cm 22* h 11* 22 · cc 2200 8 3/4" x h 4 1/4" x 8 3/4" · 74 1/2 oz. inner 6 master 18 Bowl ovale con piede Oval footed bowl S0924240NER 8000257640907 cm 24* h 8,8* 20 · cc 1110 9 1/2" x h 3 1/2" x 7 3/4" · 37 1/2 oz. inner 6 master 24
Bowl con piede Footed bowl S0924200BIA
20,2* h 8* 20,2 · cc 910
x h 3 1/4" x 8" · 30 3/4 oz.
6 master 36 Bowl con piede Footed bowl S0924220BIA
22* h 9,5* 22 · cc 1270
3/4"
S0941320BIA 8000257783741 cm 32* h 6,6* 20 12 1/2" x h 2 1/2" x 7 3/4" inner 6
master 12
8000257783789 cm 37* h 6,8* 21 14 1/2" x h 2 3/4" x 8 1/4" inner 6 master 12 Pirofila rettangolare Rectangular baking dish S0941400BIA 8000257783802 cm 40* h 7* 24 15 3/4" x h 2 3/4" x 9 1/2" inner 6 master 12 0BIA · White-Bianco 0NER · Black-Nero Ovale fondo Deep oval dish S0934M40BIA 8056444309447 cm 27* h 4* 17 10 3/4" x h 1 1/2" x 6 3/4" inner 6 master 12 Ovale fondo Deep oval dish S0934M20BIA 8056444309362 cm 42* h 4,8* 9 1/2 16 1/2" x h 2" x 9 1/2" inner 6 master 12 Ovale fondo Deep oval dish S0934M10BIA 8056444309324 cm 47* h 5* 29 18 1/2" x h 2" x 11 1/2" inner 6 master 12 Ovale fondo Deep oval dish S0934M30BIA 8056444309409 cm 34* h 4,5* 21 13 1/2" x h 1 3/4" x 8 1/4" inner 6 master 12


























256 257 Posacenere Ashtray S09PS100BIA 8000257644196 cm 10,3* h 3,3* 10,3 4" x h 1 1/4" x 4" inner 6 master 60 Posacenere antivento Wind ashtray S09PS120BIA 8000257644745 cm 10* h 4,6* 10 4" x h 1 3/4" x 4" inner 6 master 60 Posacenere antivento Wind ashtray S09PS120NER 8000257955445 cm 10* h 4,6* 10 4" x h 1 3/4" x 4" inner 6 master 60 Piatto piano Dinner plate S0900260BIA 8000257780498 cm 26* h 2,5* 26 10 1/4" x h 1" x 10 1/4" inner 6 master 24 Piatto dessert Dessert plate S0902200BIA 8000257780511 cm 20,2* h 2,5* 20,2 7 3/4" x h 1" x 7 3/4" inner 6 master 24 Fondina Soup plate S0901170BIA 8000257780504 cm 17,5* h 5,8* 17,5 · cc 600 7" x h 2 1/4" x 7" · 20 1/4 oz. inner 6 master 24 Portabustine Sugar holder S09SC010BIA 8000257830919 cm 9* h 5* 6 3 1/2" x h 2" x 2 1/4" inner 12 master 96 Portabustine Sugar holder S09SC010NER 8000257779379 cm 9* h 5* 6 3 1/2" x h 2" x 2 1/4" inner 12 master 96 0BIA · White-Bianco 0NER · Black-Nero Tazzina moka Coffee cup S0915090BIA 8000257829425 cm 7,5* h 4,8* 9 · cc 90 3" x h 2" x 3 1/2" · 3 oz. inner 12 master 120 Tazzina moka Coffee cup S0915090NER 8000257829432 cm 7,5* h 4,8* 9 · cc 90 3" x h 2" x 3 1/2" · 3 oz. inner 12 master 120 Mug Mug S0914350BIA 8000257780528 cm 8,7* h 10,3* 11 · cc 310 3 1/2" x h 4" x 4 1/4" · 10 1/2 oz. inner 6 master 72 Alzata torta Cake stand S09AH100BIA 8000257991511 cm 12,5* h 10* 12,5 5" x h 4" x 5" inner 12 master 36 Alzata torta Cake stand S09AH180BIA 8000257991535 cm 13,8* h 18* 13,8 5 1/2" x h 7" x 5 1/2" inner 6 master 36 Piatto torta Cake plate S0922300BIA 8000257991559 cm 30* h 1,5* 30 11 3/4" x h 1/2" x 11 3/4" inner 6 master 18 Bicchiere Pot S0914H90BIA 8056444329964 cm 10* h 12 4" x h 4 1/2" inner 6 master 60
0BIA · White-Bianco 0NER · Black-Nero
show plate gastronorm










































258 259 1/1 1/2 1/3 1/3 GASTRONORM SYSTEM 1/1 1/2 1/2 1/3 1/3 1/3 Contenitore gn 1/1 Gn 1/1 dish S0941A40BIA 8000257650845 cm 52,2* h 4* 32 20 1/2" x h 3/4" x 12 1/2" inner 1 master 6 Contenitore gn 1/1 Gn 1/1 dish S0941A50BIA 8000257651095 cm 52,2* h 6,5* 32 20 1/2" x h 2 1/2" x 12 1/2" inner 1 master 6 Contenitore gn 1/2 Gn 1/2 dish S0941A60BIA 8000257651118 cm 32* h 6,5* 26 12 1/2" x h 3/4" x 10 1/4" inner 6 master 12 Contenitore gn 1/2 Gn 1/2 dish S0941A70BIA 8000257651392 cm 32* h 4* 26 12 1/2" x h 2 3/4" x 10 1/4" inner 6 master 12 Contenitore gn 1/3 Gn 1/3 dish S0941A80BIA 8000257652818 cm 32* h 6,5* 17,5 12 1/2" x h 2 3/4" x 7" inner 6 master 24 Contenitore gn 1/6 Gn 1/6 dish S0941A90BIA 8000257653440 cm 17,5* h 6,5* 16 7" x h 2 1/2" x 6 1/4" inner 6 master 24
dimensioni gastronorm in vari colori per tutti gli utilizzi gastronorm sizes in various colours for all uses
le
show plate gastronorm

le dimensioni gastronorm in vari colori per tutti gli utilizzi

sizes in various colours for all uses















260 261 0NER · Black-Nero 0NER · Black-Nero WOOD · Wood-Legno WOOD · Wood-Legno DARK · Dark DARK · Dark
Gn
8000257555041 cm
inner
Piastra gn 1/3
1/3 tray S0941A3DARK
32,5* h 1,7* 17,5 12 3/4" x h 3/4" x 7"
6 master 24
Gn
inner
Piastra gn 1/3
1/3 tray S0941A30NER 8000257650814 cm 32,5* h 1,7* 17,5 12 3/4" x h 3/4" x 7"
6 master 24
Gn
inner
Gn
8000257543055 cm 53*
16,2 20 3/4"
inner 6
Gn 2/4
S09TA210NER 8000257733876 cm 53*
1* 16,2 20 3/4"
h 1/2"
6 1/2" inner 6
Piastra gn 1/3
1/3 tray S0941A3WOOD 8000257650746 cm 32,5* h 1,7* 17,5 12 3/4" x h 3/4" x 7"
6 master 24 Tavoletta gn 2/4
2/4 plate S09TA21DARK
h 1*
x h 1/2" x 6 1/2"
master 18 Tavoletta gn 2/4
plate
h
x
x
master 18
Gn
S09TA21WOOD 8000257733869 cm 53* h 1* 16,2 20 3/4" x h 1/2" x 6 1/2" inner 6 master 18 Piastra gn 1/1 Gn 1/1 tray S0941A1DARK 8000257555027 cm 53* h 1,7* 32,5 20 3/4" x h 3/4" x 12 3/4" inner 2 master 12 Piastra gn 1/1 Gn 1/1 tray S0941A10NER 8000257650456 cm 53* h 1,7* 32,5 20 3/4" x h 3/4" x 12 3/4" inner 2 master 12
gn 1/1 Gn 1/1 tray S0941A1WOOD 8000257649795 cm 53* h 1,7* 32,5 20 3/4" x h 3/4" x 12 3/4" inner 2 master 12 Piastra gn 1/2 Gn 1/2 tray S0941A2DARK 8000257555034 cm 32,5* h 1,7* 26,5 12 3/4" x h 3/4" x 10 1/2" inner 6 master 24 Piastra gn 1/2 Gn 1/2 tray S0941A20NER 8000257650586 cm 32,5* h 1,7* 26,5 12 3/4" x h 3/4" x 10 1/2" inner 6 master 24 Piastra gn 1/2 Gn 1/2 tray S0941A2WOOD 8000257650531 cm 32,5* h 1,7* 26,5 12 3/4" x h 3/4" x 10 1/2" inner 6 master 24
Tavoletta gn 2/4
2/4 plate
Piastra
gastronorm
S09TA05DARK
8000257535159
cm 40* h 1,5* 51
15 3/4" x h 1/2" x 20"
S09TA04DARK
8000257535142
cm 36* h 1,5* 46 14 1/4" x h 1/2" x 18"

S09TA03DARK
8000257533643
cm 32* h 1,5* 41,5
12 1/2" x h 1/2" x 16 1/4"
S09TA02DARK 8000257529660
cm 28* h 1,5* 37 11" x h 1/2" x 14 1/2"
S09TA01DARK






8000257529653
cm 23* h 1,5* 32 9" x h 1/2" x 12 1/2"
Tagliere tondo Round chopping board
inner 6 master 12
Tagliere tondo Round chopping board
Tagliere tondo Round chopping board
Tagliere tondo Round cutting board
Tagliere tondo Round cutting board
inner 6 master 12
inner 6 master 12
inner 6 master 24
inner 6 master 36
S09TA05WOOD 8000257733791
cm 40* h 1,5* 51
15 3/4" x h 1/2" x 20"
S09TA04WOOD 8000257733777
cm 36* h 1,5* 46
14 1/4" x h 1/2" x 18"
S09TA03WOOD 8000257733753
cm 32* h 1,5* 41,5
12 1/2" x h 1/2" x 16 1/4"
S09TA02WOOD 8000257733661
cm 28* h 1,5* 37
11" x h 1/2" x 14 1/2"
S09TA01WOOD 8000257733715
cm 23* h 1,5* 32
9" x h 1/2" x 12 1/2"
Tagliere tondo
Round cutting board
Tagliere tondo
Round cutting board
Tagliere tondo
Round cutting board
Tagliere tondo
Round cutting board
Tagliere tondo
Round cutting board
inner 6 master 12
inner 6 master 12
inner 6 master 12
inner 6 master 24
inner 6 master 36
S09TAT9DARK 8000257528786
cm 51* h 1,6* 16
20" x h 3/4" x 6 1/4"
S09TA12DARK
8000257543048
cm 18 x 30* h 1,5* 41,7
7 x 11 3/4" x h 1/2" x 16 1/2"
S09TA11DARK
8000257540344
cm 27,7 x 13,8* h 1,5* 37,5
11 x 5 1/2" x h 1/2" x 14 3/4"
Tagliere rettangolare Rectangular board
Tagliere rettangolare Rectangular chopping board
Tagliere rettangolare Rectangular chopping board
inner 2 master 12
inner 6 master 12
inner 6 master 12
S09TAT9WOOD 8000257795119
cm 51* h 1,6* 16
20" x h 3/4" x 6 1/4"
S09TA12WOOD 8000257733845
cm 18 x 30* h 1,5* 41,7
7 x 11 3/4" x h 1/2" x 16 1/2"
S09TA11WOOD 8000257733814
cm 27,7 x 13,8* h 1,5* 37,5
11 x 5 1/2" x h 1/2" x 14 3/4"
Tagliere rettangolare Rectangular cutting board
Tagliere rettangolare Rectangular cutting board
Tagliere rettangolare Rectangular cutting board
inner 2 master 12
inner 6 master 12
inner 6 master 12
S093429WOOD 8056444330052
cm 39* h 23,5
15 1/4" x h 9 1/4"
S093433WOOD 8056444330076


cm 33* h 20
13" x h 7 3/4"
Piatto wood 39
Wooden plate 39

Piatto wood 33

Wooden plate 33

inner 6 master 30
inner 6 master 36
S09TA38WOOD 8056444394689
cm 60* h 2* 30
Tagliere rettangolare per pinsa
Pinsa cutting board

inner 1 master 6
23 3/4" x h 3/4" x 11 3/4"
262 263

















264 Coppetta tonda Round bowl S0904100NER 8000257779454 cm 9,7* h 5* 9,7 · cc 200 3 3/4" x h 2" x 3 3/4" · 6 3/4 oz. inner 12 master 144 Coppetta tonda Round bowl S0904110NER 8000257779461 cm 11,3* h 5,5* 11,3 · cc 300 4 1/2" x h 2 1/4" x 4 1/2" · 10 1/4 oz. inner 12 master 144 Coppetta tonda righe Round bowl S0904090NER 8000257779447 cm 9,5* h 5* 9,5 · cc 120 3 3/4" x h 2" x 3 3/4" · 4 oz. inner 12 master 144 Coppetta esagonale Bowl S0904130NER 8000257779485 cm 8,5* h 2,9* 8,5 · cc 90 3 1/4" x h 1 1/4" x 3 1/4" · 3 oz. inner 12 master 192 Coppetta obliqua Bowl S0904160NER 8000257779508 cm 13* h 9* 12 · cc 200 5" x h 3 1/2" x 4 3/4" · 6 3/4 oz. inner 6 master 72 Coppetta ovale Oval bowl S0904140NER 8000257779492 cm 9,7* h 4,2* 7,8 · cc 80 3 3/4" x h 1 3/4" x 3" · 2 3/4 oz. inner 12 master 192 Coppetta con coperchio Bowl with lid S0904180NER 8000257779515 cm 10* h 8* 10 · cc 250 4" x h 3 1/4" x 4" · 8 1/2 oz. inner 6 master 72 Coppetta goccia Bowl S0904220NER 8000257779522 cm 9,5* h 3,8* 7,5 · cc 40 3 3/4" x h 1 1/2" x 3" · 1 1/4 oz. inner 12 master 192 Vassoietto ovale righe Oval tray S0934A60NER 8000257779539 cm 14* h 3* 8 5 1/2" x h 1 1/4" x 3 1/4" inner 12 master 144 0BIA
White-Bianco 0NER · Black-Nero
linea ricca di articoli per finger food in melamina full range of melamine finger food items
·
show plate finger food
































266 267 0BIA · White-Bianco 0NER · Black-Nero
Square deep plate S0903100NER 8000257779386 cm 10* h 2,5* 10 · cc 125 4" x h 1" x 4" · 4 1/4 oz. inner 12 master 240
Rectangular plate S0903130NER 8000257779409 cm 13,3* h 1,8* 9 5 1/4" x h 3/4" x 3 1/2" inner 12 master 192
ovale righe Oval plate S0903110NER 8000257779393 cm 10,5* h 2,8* 9,5 4 1/4" x h 1" x 3 3/4" inner 12 master 192
Fingerfood spoon S09AY320NER 8000257779362 cm 12,9* h 2,6* 3,7 5" x h 1" x 1 1/2" inner 12 master 432
Small fingerfood spoon S09AY300NER 8000257779348 cm 9,5* h 2,3* 5,7 3 3/4" x h 1" x 2 1/4" inner 12 master 432
Piattino quadro fondo
Piattino rettangolare
Piattino
Cucchiaio finger
Cucchiaio finger piccolo
Big fingerfood spoon S09AY310NER 8000257779355 cm 12,9* h 3,9* 9,4 5" x h 1 1/2" x 3 3/4" inner 12 master 240 Cucchiaio finger Fingerfood spoon S09AY290NER 8000257779331 cm 14,5* h 5,2* 4,7 5 3/4" x h 2" x 1 3/4" inner 12 master 288 Coppetta finger Bowl S0904070NER 8000257779423 cm 11,5* h 5,6* 6,3 · cc 30 4 1/2" x h 2 1/4" x 2 1/2" · 1 oz. inner 12 master 288 Coppetta finger Bowl S0904080NER 8000257779430 cm 10,2* h 4,9* 9 · cc 70 4" x h 2" x 3 1/2" · 2 1/4 oz. inner 12 master 288 Coppetta finger Bowl S0904060NER 8000257779416 cm 11,5* h 2,5* 7,8 · cc 50 4 1/2" x h 1" x 3" · 1 3/4 oz. inner 12 master 288 Coppetta quadrata Small square cup S09ME350BIA 8056444167641 cm 7,2* h 7* 4,5 2 3/4" x h 2 3/4" x 1 3/4" inner 24 master 240 Coppetta quadrata Small square cup S09ME350NER 8056444167658 cm 7,2* h 7* 4,5 2 3/4" x h 2 3/4" x 1 3/4" inner 24 master 240 Bicchierino rotondo Small round cup S09ME380BIA 8056444167719 cm 4,5* h 6* 3,3 1 3/4" x h 2 1/4" x 1 1/4" inner 48 master 480 Bicchierino rotondo Small round cup S09ME380NER 8056444167726 cm 4,5* h 6* 3,3 1 3/4" x h 2 1/4" x 1 1/4" inner 48 master 480 Tris salsiera Hors-d’oeuvre plate 3 sector S0925230BIA 8056444210231 cm 23* h 3* 7,50 · 9" x h 1 1/4" x 3" inner 4 master 96 Tris salsiera Hors-d’oeuvre plate 3 sector S0925230NER 8056444210224 cm 23* h 3* 7,50 · 9" x h 1 1/4" x 3" inner 4 master 96 Coppetta conica Conical bowl S0904230BIA 8056444083149 cm 8,5* h 5,5* 8,5 · cc 130 3 1/4" x h 2 1/4" x 3 1/4" · 4 1/2 oz. inner 20 master 120 Coppetta conica Conical bowl S0904230NER 8056444083156 cm 8,5* h 5,5* 8,5 · cc 130 3 1/4" x h 2 1/4" x 3 1/4" · 4 1/2 oz. inner 20 master 120 0BIA · White-Bianco 0NER · Black-Nero
Cucchiaio finger grande































268 269
Square saucer S0905080BIA 8000257829395 cm 10* h 1,8* 10 4" x h 3/4" x 4" inner 12 master 180 Piattino quadrato Square saucer S0905080NER 8000257829401 cm 10* h 1,8* 10 4" x h 3/4" x 4" inner 12 master 180
tondo Round saucer S0905090BIA 8056444083217 cm 9* h 2,5* 9 3 1/2" x h 1" x 3 1/2" inner 20 master 240 Piattino tondo Round saucer S0905090NER 8056444083200 cm 9* h 2,5* 9 3 1/2" x h 1" x 3 1/2" inner 20 master 240
quadrato Square saucer S0905070BIA 8056444083170 cm 7,3* h 2,8* 7,3 · cc 70 2 3/4" x h 1" x 2 3/4" · 2 1/4 oz. inner 20 master 240 Piattino quadrato Square saucer S0905070NER 8056444083187 cm 7,3* h 2,8* 7,3 · cc 70 2 3/4" x h 1" x 2 3/4" · 2 1/4 oz. inner 20 master 240
Bowl S0904050BIA 8000257956282 cm 7* h 3,2* 7 · cc 50 2 3/4" x h 1 1/4" x 2 3/4" · 1 3/4 oz. inner 24 master 240 Coppetta Bowl S0904050NER 8056444089448 cm 7* h 3,2* 7 · cc 50 2 3/4" x h 1 1/4" x 2 3/4" · 1 3/4 oz. inner 24 master 240 Piattino
scomparti
sector plate S0934M50NER 8056444456561 cm 12,5* h 3* 8 5" x h 1 1/4" x 3 1/4" inner 12 master 48 Piattino 3 scomparti 3 sector plate S0934M60NER 8056444456608 cm 19,5* h 3* 8 7 3/4" x h 1 1/4" x 3 1/4" inner 12 master 48
Sushi plate S0934M70NER 8056444456646 cm 19,5* h 3* 11,5 7 3/4" x h 1 1/4" x 4 1/2" inner 12 master 48 Bucket 11 Bucket 11 S0968110GRI 8056444330007 cm 11* h 9,3 4 1/4" x h 3 3/4" inner 6 master 240 Bucket 8 Bucket 8 S0968080GRI 8056444330021 cm 7,6* h 6,5 3" x h 2 1/2" inner 6 master 60 Bucket 15 Bucket 15 S0968150GRI 8056444329988 cm 15* h 11 6" x h 4 1/4" inner 6 master 96 Poggiaposate melamina Cutlery rest S09PP03MAWH 8056444462296 cm 8* h 1* 2 3 1/4" x h 3/8" x 3/4 inner 100 master 800 Poggiaposate melamina Cutlery rest S09PP03MABL 8056444462302 cm 8* h 1* 2 3 1/4" x h 3/8" x 3/4 inner 100 master 800 Set 2 chopstick Set 2 chopstick S09BTS10NER 8056444170450 cm 24,5 9 3/4" inner 20 master 500 Set 2 chopstick Set 2 chopstick S09BTS20NER 8056444170474 cm 22 8 3/4" inner 20 master 500 Chopstick rest Chopstick rest S09BTS30NER 8056444170498 cm 5 * 3,4 2" x 1 1/4" inner 20 master 600 0BIA · White-Bianco 0NER · Black-Nero 0BIA · White-Bianco 0NER · Black-Nero NEW 2024 NEW 2024 NEW 2024 NEW 2024 NEW 2024
Piattino quadrato
Piattino
Piattino
Coppetta
2
2
Piattino sushi
CARATTERISTICHE / FEATURES
Presa elettrica SCHUKO / Electric socket SCHUKO
Cavo retraibile 60 cm/ Retractable cable 27 1/2"
il bollitore professionale completo di vassoi
the professional kettle for the station with its trays



CARATTERISTICHE / FEATURES




Presa elettrica SCHUKO / Electric socket SCHUKO
Cavo retraibile 70 cm/ Retractable cable 27 1/2"
Capacità 1 L/ Capacity 1.06 qt


Potenza 950 W / Power 950 W
Base cordless con ventose / Cordless stand with vacuum feet
Esterno: plastica termoresistente antiscottatura / Exterior:

cool touch and anti-scald heat-resistant plastic
Interno: acciaio inox 304 / Inside: stainless steel 304

Set 3 vassoi per bollitore Set 3 trays for kettle
S2934A40NER 8000257771618 inner 1 master 6
9,40 5" x h 1 1/2" x 3 3/4" vassoio rett. piccolo

270 271 Bollitore elettrico Electric kettle S24BE12INOX 8000257771632 cm 14* h 22* 14 · L1,2 5 1/2" x h 8 3/4" x 5 1/2" inner 1 master 6
Electric kettle
8056444438352 cm 11* h 21,6 · cc 1000 4 1/4" x h 8 1/2" · 33 3/4 oz. inner 6 master Vassoio per bollitore 1 tray and steel panel S29VS65BLCK 8056444438406 cm 45* 20 17 3/4" x 7 3/4" inner 12 master
elettrico Electric kettle
8056444438369 cm 11* h 21,6 · cc 1000 4 1/4" x h 8 1/2" · 33 3/4 oz. inner 6 master Vassoio per bollitore 1 tray and steel panel S29VS65WHIT 8056444438413 cm 45* 20 17 3/4" x 7 3/4" inner 12 master cm 34* h 2,50* 31 13 1/2" x h 1" x 1" vassoio grande cm 32* h 1,70* 12,70 12 1/2" x h 3/4" x 5" vassoio rett. medio cm 12,60* h 4*
Bollitore elettrico
D2DBE10BLCK
Bollitore
D2DBE10WHIT
premium
WHIT · White-Bianco BLCK · Black-Nero
dinamika dinamika
flatware

R5784F10154
8056444472370
NEW
VERSIONE
Set 2 forchetta tavola Set 2 dinner fork




cm 20,4* h 1* 2,4 (spessore 4 mm)
8" x h 1/2" x 1" (4 mm thick)
inner 6 master 60
NEW
R5784F30154
8056444472417
Set 2 coltello tavola Set 2 dinner knife
cm 21,5* h 0,5* 1,8 (spessore 4 mm)
8 1/2" x h 1/4" x 3/4" (4 mm thick)
R5784F50154
8056444472455
Set 2 coltello bistecca Set 2 steak knife



cm 21,5* h 2* 0,8 (spessore 5 mm)
8" 1/2 x h 3/4" x 1/4" (5 mm thick)
inner 6 master 60
NEW
R5784F20154
8056444472394
cm 20,4* h 1* 4 (spessore 4 mm)
8" x h 1/2" x 1 1/2" (4 mm thick)
Set 2 cucchiaio tavola Set 2 dinner spoon




inner 6 master 60
R5784F40154






8056444472851
cm 14,5* h 2,7* 1,5 (spessore 4 mm)
5 3/4" x h 1" x 3/4" (4 mm thick)
Set 2 cucchiaio tè Set 2 tea spoon



inner 6 master 60
R5784F60154

8056444472479
cm 23,5* h 7* 7 (spessore 7 mm)

Set 2x2 chopstick Set 2x2 chopstick



9 1/4" x h 2 3/4" x 2 3/4" (7 mm thick)
inner 6 master 60
274 275
2024
inner 6 master 60 2024
2024
2024
2024
2024
mex stainless steel
NEW
NEW
NEW
tex
420 vintage finishing
LOGO + BOLLO
LOGO
TEX MEX VERSIONE DEFINITIVA
AISI
VERSIONE
LOGO














276 master Coppetta chips Chips bowl R5760M10154 8056444472707 cm 9,7* h 8,3* 5,5 3 3/4" x h 3 1/4" x 2 1/4" inner 12 master 60 Vassoio fondo ovale Oval deep tray R5760M50154 8056444472783 cm 25,5* h 2,8* 16,5 9 3/4" x h 1 1/4" x 6 1/2" inner 6 master 36 Vassoio rettangolare Rectangular baking tray R5760M30154 8056444472745 cm 25* h 1,3* 18 9 3/4" x h 1/2" x 7" inner 6 master 36 Large bowl Large bowl R5760M70154 8056444472820 cm 9,7* h 4,8* 9,7 3 3/4" x h 3 1/2" x 3 3/4" inner 12 master 60 Coppetta Small ball R5760L90154 8056444472684 cm 7,7* h 2,3* 7,7 3" x h 1" x 3" inner 12 master 60 Vassoio rettangolare Rectangular baking tray R5760M40154 8056444472769 cm 28* h 1,3* 20 11" x h 1/2" x 7 3/4" inner 6 master 36 Vassoio rettangolare Rectangular baking tray R5760M20154 8056444472721 cm 19* h 1,3* 14 7 1/2" x h 1/2" x 5 1/2" inner 6 master 36 Mini bowl Mini bowl R5760M60154 8056444472806 cm 7,7* h 4* 7,7 3" x h 1 1/2" x 3" inner 12 master 60 Mini padella Mini pan R5760L80154 8056444472660 cm 10,3* h 3,1* 10,3 4" x h 1 1/4" x 4" inner 12 master 60 Mini padella Mini pan R5760L70154 8056444472646 cm 12,3* h 3,1* 12,3 4 3/4" x h 1 1/4" x 4 3/4" inner 12 master 60 tex mex NEW 2024 NEW 2024 NEW 2024 NEW 2024 NEW 2024 NEW 2024













279 278 Coltello fiorentina Knife for t-bone steak R5760G1WOOD 8056444091489 cm 23* h 1,5* 2,5 9" x h 1/2" x 1" inner 6 master 48 Set 2 coltelli bistecca forgiato set 2 forged steak knives R5784F70155 8056444472493 cm 23* h 2* 2 9" x h 3/4" x 3/4" inner 12 master 48 Coltello filetto Living wooden R5760G2WOOD 8056444091502 cm 24* h 1,5* 2 9 1/2" x h 1/2" x 3/4" inner 6 master 48 Set 2 coltello bistecca Set 2 steak knife R5784F50155 8056444472509 cm 24* h 2* 2 9 1/2" x h 3/4" x 3/4" inner 12 master 48 NEW 2024 NEW 2024



















281 Cucchiaio tavola Table spoon R5760H10153 8056444470567 cm 21,5* h 2,4* 4 8 1/2" x h 1" x 1 1/2" inner 12 master 120 Set 2 cucchiaio caffè Set 2 coffee spoon R5784F80153A 8056444000672 cm 15* h 1,8* 3,2 6" x h 3/4" x 1 1/4" inner 6 master 60 Set 2 forchetta tavola Set 2 table fork R5784F10153A 8056444000610 cm 21* h 2,4* 4 8 1/4" x h 1" x 1 1/2" inner 6 master 60 Set 2 coltello tavola Set 2 table knife R5784F30153A 8056444000641 cm 23,5* h 1,8* 2 9 1/4" x h 3/4" x 3/4" inner 6 master 60 Set 2 cucchiaio tavola Set 2 table spoon R5784F20153A 8056444000580 cm 21,5* h 2,4* 4 8 1/2" x h 1" x 1 1/2" inner 6 master 60 Forchetta tavola Table fork R5760H20153 8056444470604 cm 21* h 2,4* 4 8 1/4" x h 1" x 1 1/2" inner 12 master 120 Coltello tavola Table knife R5760H30153 8056444470642 cm 23,5* h 1,8* 2 9 1/4" x h 3/4" x 3/4" inner 12 master 120 Cucchiaio frutta Dessert spoon R5760H40153 8056444470680 cm 18,6* h 1,8* 3,5 7 1/4" x h 3/4" x 1 1/2" inner 12 master 120 Set 2 cucchiaio moka Set 2 moka spoon R5784F90153A 8056444000702 cm 12* h 1,65* 2,44 4 3/4" x h 3/4" x 1" inner 6 master 60 Cucchiaio caffè Coffee spoon R5760H70153 8056444470802 cm 15* h 1,8* 3,2 6" x h 3/4" x 1 1/4" inner 12 master 120 Forchetta frutta Dessert fork R5760H50153 8056444470727 cm 18,1* h 2,2* 2,4 7" x h 3/4" x 1" inner 12 master 120 Coltello frutta Dessert knife R5760H60153 8056444470765 cm 21* h 1,6* 1,8 8 1/4" x h 3/4" x 3/4" inner 12 master 120 Cucchiaio moka Moka spoon R5760H80153 8056444470840 cm 12* h 1,65* 2,44 4 3/4" x h 3/4" x 1" inner 12 master 120
spessore 4 mm in acciao inox 18/10 4 mm thick in stainless steel 18/10 NEW 2024 NEW 2024 NEW 2024 NEW 2024 NEW 2024 NEW 2024 NEW 2024 NEW 2024 NEW 2024
alhambra
MADE IN ITALY









283 Cucchiaio tavola Table spoon R5760F10144 8000257736969 cm 20* h 0,25* 4,4 7 3/4" x h 1/8" x 1 3/4" inner 12 master 240 Forchetta tavola Table fork R5760F20144 8000257737003 cm 20,2* h 0,25* 2,5 8" x h 1/8" x 1" inner 12 master 240 Coltello tavola Table knife R5760F30144 8000257737010 cm 23* h 0,25* 2 9" x h 1/8" x 3/4" inner 12 master 240 Cucchiaio frutta Dessert spoon R5760F40144 8000257737027 cm 18* h 0,25* 3,70 7" x h 1/8" x 1 1/2" inner 12 master 240 Forchetta frutta Dessert fork R5760F50144 8000257737034 cm 18,2* h 0,25* 2,2 7 1/4" x h 1/8" x 3/4" inner 12 master 240 Coltello frutta Dessert knife R5760F60144 8000257737041 cm 21* h 0,25* 1,9 8 1/4" x h 1/8" x 3/4" inner 12 master 240 Cucchiaio caffè Coffee spoon R5760F70144 8000257737058 cm 14* h 0,25* 2,9 5 1/2" x h 1/8" x 1 1/4" inner 12 master 600 Cucchiaio moka Moka spoon R5760F80144 8000257737089 cm 11,5* h 0,25* 2,4 4 1/2" x h 1/8" x 1" inner 12 master 600 charme stile classico, finitura vintage invecchiata artificialmente e spessore in 2,5 mm in acciaio inox 18/10 classic style, 2,5 mm thicking artificially aged vintage finish in stainless steel 18/10









285 Cucchiaio tavola Table spoon R5760D10142 8000257736761 cm 21,2* h 0,25* 4,1 8 1/4" x h 1/8" x 1 1/2" inner 12 master 240 Forchetta tavola Table fork R5760D20142 8000257736778 cm 21,7* h 0,25* 2,6 8 1/2" x h 1/8" x 1" inner 12 master 240 Coltello tavola forgiato Table knife R5760D30142 8000257736785 cm 23,7* h 0,25* 1,8 9 1/4" x h 1/8" x 3/4" inner 12 master 144 Cucchiaio frutta Dessert spoon R5760D40142 8000257736792 cm 18,3* h 0,25* 3,5 7 1/4" x h 1/8" x 1 1/2" inner 12 master 240 Cucchiaio caffè Coffee spoon R5760D70142 8000257736839 cm 13* h 0,25* 2,5 5" x h 1/8" x 1" inner 12 master 600 Forchetta frutta Dessert fork R5760D50142 8000257736808 cm 19,7* h 0,25* 2,3 7 3/4" x h 1/8" x 1" inner 12 master 240 Coltello frutta forgiato Dessert knife R5760D60142 8000257736815 cm 21* h 0,25* 1,5 8 1/4" x h 1/8" x 1/2" inner 12 master 240 Cucchiaio moka Moka spoon R5760D80142 8000257736853 cm 10,5* h 0,25* 2,1 4 1/4" x h 1/8" x 3/4" inner 12 master 600 portovenere stile liscio e spessore 2,5 mm in acciao inox 18/10 smooth style and 2,5 mm thick in stainless steel 18/10
MADE IN ITALY
MADE IN









287 Cucchiaio tavola Table spoon R5760B10140 8000257736471 cm 20,7* h 0,25* 4,5 8 1/4" x h 1/8" x 1 3/4" inner 12 master 240 Forchetta tavola Table fork R5760B20140 8000257736501 cm 20,7* h 0,25* 2,5 8 1/4" x h 1/8" x 1" inner 12 master 240 Coltello tavola forgiato Table knife R5760B30140 8000257736549 cm 23,3* h 0,25* 2,3 9 1/4" x h 1/8" x 1" inner 12 master 240 Cucchiaio frutta Dessert spoon R5760B40140 8000257736556 cm 19* h 0,25* 4,2 7 1/2" x h 1/8" x 1 3/4" inner 12 master 240 Forchetta frutta Dessert fork R5760B50140 8000257736563 cm 19* h 0,25* 2,5 7 1/2" x h 1/8" x 1" inner 12 master 240 Coltello frutta forgiato Dessert knife R5760B60140 8000257736570 cm 20,7* h 0,25* 2,5 8 1/4" x h 1/8" x 1" inner 12 master 240 Cucchiaio caffè Coffee spoon R5760B70140 8000257736587 cm 13,8* h 0,25* 3 5 1/2" x h 1/8" x 1 1/4" inner 12 master 600 Cucchiaio moka Moka spoon R5760B80140 8000257736594 cm 11,4* h 0,25* 2,5 4 1/2" x h 1/8" x 1" inner 12 master 600
stile classico e spessore 2,5 mm in acciao inox 18/10 classic style and 2,5 mm thick in stainless steel 18/10
rapallo
ITALY
viareggio
MADE











289 Cucchiaio tavola Table spoon R5760E10143 8000257736860 cm 20* h 0,18* 4,6 7 3/4" x h 1/8" x 1 3/4" inner 12 master 240 Forchetta tavola Table fork R5760E20143 8000257736877 cm 20,2* h 0,18* 2,6 8" x h 1/8" x 1" inner 12 master 240 Coltello tavola forgiato Table knife R5760E30143 8000257736884 cm 23,4* h 0,18* 2,1 9 1/4" x h 1/8" x 3/4" inner 12 master 240 Forchetta frutta Dessert fork R5760E50143 8000257736921 cm 17,5* h 0,18* 2,2 7" x h 1/8" x 3/4" inner 12 master 240 Coltello frutta forgiato Dessert knife R5760E60143 8000257736938 cm 20,3* h 0,18* 1,8 8" x h 1/8" x 3/4" inner 12 master 240 Cucchiaio caffè Coffee spoon R5760E70143 8000257736945 cm 13,8* h 0,18* 2,9 5 1/2" x h 1/8" x 1 1/4" inner 12 master 600 Cucchiaio moka Moka spoon R5760E80143 8000257736952 cm 11* h 0,18* 2,3 4 1/4" x h 1/8" x 1" inner 12 master 600 Cucchiaio bibita Iced tea spoon R5760E90143 8056444039184 cm 19,2* h 0,18* 3 7 1/2" x h 1/8" x 1 1/4" inner 12 master 240
stile basico e liscio, spessore 1,8 mm in acciaio inox 18/10 basic and smooth style, 1,8 mm thick in stainless steel
IN ITALY















291 Cucchiaio tavola Table spoon R5760C10141 8000257736600 cm 20,8* h 0,25* 4,4 8 1/4" x h 1/8" x 1 3/4" inner 12 master 240 Forchetta tavola Table fork R5760C20141 8000257736624 cm 20,8* h 0,25* 2,7 8 1/4" x h 1/8" x 1" inner 12 master 240 Coltello tavola forgiato Table knife R5760C30141 8000257736631 cm 23* h 0,25* 1,9 9" x h 1/8" x 3/4" inner 12 master 240 Cucchiaio frutta Dessert spoon R5760C40141 8000257736648 cm 17,8* h 0,25* 4 7" x h 1/8" x 1 1/2" inner 12 master 240 Forchetta frutta Dessert fork R5760C50141 8000257736655 cm 18* h 0,25* 2,2 7" x h 1/8" x 3/4" inner 12 master 240 Coltello frutta forgiato Dessert knife R5760C60141 8000257736679 cm 21* h 0,25* 1,7 8 1/4" x h 1/8" x 3/4" inner 12 master 240 Cucchiaio caffè Coffee spoon R5760C70141 8000257736693 cm 12,7* h 0,25* 2,8 5" x h 1/8" x 1" inner 12 master 600 Cucchiaio moka Moka spoon R5760C80141 8000257736723 cm 10,7* h 0,25* 2,3 4 1/4" x h 1/8" x 1" inner 12 master 600 Forchetta pesce Fish fork R5760C90141 8000257743288 cm 21* h 0,25* 2 8 1/4" x h 1/8" x 3/4" inner 12 master 240 Coltello pesce forgiato Fish knife R5760CA0141 8000257743325 cm 22,8* h 0,25* 2,5 9" x h 1/8" x 1" inner 12 master 240 Forchettina dolce Dessert fork R5760CB0141 8000257743301 cm 15* h 0,25* 2 6" x h 1/8" x 3/4" inner 12 master 600 sirolo stile moderno e spessore 2,5 mm in acciao inox 18/10 modern style and 2,5 mm thick in stainless steel 18/10 MADE IN ITALY









293 Cucchiaio tavola Table spoon R5760A10139 8000257736372 cm 19,8* h 0,4* 4,5 7 3/4" x h 1/4" x 1 3/4" inner 12 master 240 Forchetta tavola Table fork R5760A20139 8000257736396 cm 20* h 0,4* 2,4 7 3/4" x h 1/4" x 1" inner 12 master 240 Coltello tavola Table knife R5760A30139 8000257736402 cm 23,2* h 0,4* 2 9 1/4" x h 1/4" x 3/4" inner 12 master 240 Cucchiaio frutta Dessert spoon R5760A40139 8000257736419 cm 23,2* h 0,4* 2 9 1/4" x h 1/4" x 3/4" inner 12 master 240 Forchetta frutta Dessert fork R5760A50139 8000257736426 cm 18,2* h 0,4* 2,3 7 1/4" x h 1/4" x 1" inner 12 master 240 Coltello frutta Dessert knife R5760A60139 8000257736433 cm 21,3 * h 0,4 * 1,8 8 1/2" x h 1/4" 3/4" inner 12 master 240 Cucchiaio caffè Coffee spoon R5760A70139 8000257736457 cm 13,3* h 0,4* 3 5 1/4" x h 1/4" x 1 1/4" inner 12 master 600 Cucchiaio moka Moka spoon R5760A80139 8000257736464 cm 10,5* h 0,4* 2 4 1/4" x h 1/8" x 3/4" inner 12 master 600
stile moderno e spessore 4 mm in acciao inox 18/10 modern style and 4 mm thick in stainless steel 18/10
alassio
MADE IN ITALY
glassware

Uso: bollicine





Use: sparkling wine
PW585M1TRAS 8056444257090
cc 230 8 oz.
Confezione 6 flute Set 6 flute
inner 1 master 4
Uso: vini bianchi e rossi, champagne e bollicine
Use: white and red wine, champagne and sparkling
Uso: vini rossi, cocktails
Use: red wine and long drinks

PW585M2TRAS 8056444257113
cc 440 15 oz
Confezione 6 calici medi Set 6 medium goblets

inner 1 master 4
PW585M3TRAS 8056444257144
cc 550 18 1/2 oz
Confezione 6 calici grandi Set 6 large goblets




inner 1 master 4
Uso: acqua e bibite
Use: water and soft drinks
Uso: bibite e cocktails
Use: soft and long drinks
PW585M4TRAS 8056444257175
cc 380 12 3/4 oz
Confezione 6 bicchieri Set 6 tumblers
inner 1 master 4
PW585M5TRAS
8056444257205
cc 390 13 1/4 oz
Confezione 6 bicchieri bibita set 6 juices
inner 1 master 4
297
MADE IN ITALY
vitÆ
stars & stripes









299 Conf. 6 bicchieri hightball Set 6 higtball A6585P1TRAS 8056444354393 cm 7* h 15 • 370 cc 2 3/4" x h 6" • 12 ½ oz inner 6 master 12 Conf. 6 bicchieri dof Set 6 tumbler dof A6585P2TRAS 8056444354423 cm 8,2* h 9,4 • 340 cc 3 1/4" x h 3 3/4" • 11 ½ oz inner 6 master 12 Conf. 6 calici gin tonic Set 6 gin tonic goblet A6585P3TRAS 8056444354454 cm 10,8* h 20,8 • 580 cc 4 1/4" x h 8 1/4" • 18 1/4 oz inner 6 master 12 Conf. 6 calice spritz Set 6 spritz goblet A6585P4TRAS 8056444386035 cm 10,4* h 23,7 • 670 cc 4" x h 9 1/3" • 22 1/4 oz inner 6 master 12 MADE IN ITALY













301 Bicchiere Tumbler B3557380003 8056444403336 cm 8* h 10 • 380 cc 3 1/4" x h 4" • 12 3/4 oz inner 6 master 48 Bicchiere Tumbler B3557380022 8056444403329 cm 8* h 10 • 380 cc 3 1/4" x h 4" • 12 3/4 oz inner 6 master 48 Bicchiere Tumbler B3557380113 8056444403299 cm 8* h 10 • 380 cc 3 1/4" x h 4" • 12 3/4 oz inner 6 master 48 Bicchiere Tumbler B3557380026 8056444403312 cm 8* h 10 • 380 cc 3 1/4" x h 4" • 12 3/4 oz inner 6 master 48 Bicchiere Tumbler B3557380059 8056444403282 cm 8* h 10 • 380 cc 3 1/4" x h 4" • 12 3/4 oz inner 6 master 48 Bicchiere Tumbler B3557380025 8056444403305 cm 8* h 10 • 380 cc 3 1/4" x h 4" • 12 3/4 oz inner 6 master 48 bubbles solid colour glass













303 Bicchiere Tumbler M3565280056 8056444395419 cm 8* h 10 • 260 cc 3 1/4" x h 4" • 8 1/4 oz inner 6 master 36 Calice Goblet M3557260056 8056444395600 cm 8,5* h 15,8 • 280 cc 3 1/3" x h 6 1/4" • 9 1/4 oz inner 6 master 24 Bicchiere Tumbler M3565280031 8056444395402 cm 8* h 10 • 260 cc 3 1/4" x h 4" • 8 1/4 oz inner 6 master 36 Bicchiere Tumbler M3565280023 8056444395433 cm 8* h 10 • 260 cc 3 1/4" x h 4" • 8 1/4 oz inner 6 master 36 Calice Goblet M3557260031 8056444395594 cm 8,5* h 15,8 • 280 cc 3 1/3" x h 6 1/4" • 9 1/4 oz inner 6 master 24 Calice Goblet M3557260023 8056444395624 cm 8,5* h 15,8 • 280 cc 3 1/3" x h 6 1/4" • 9 1/4 oz inner 6 master 24 marriage solid colour glass













305 Bicchiere Tumbler M3565280055 8056444395426 cm 8* h 10 • 260 cc 3 1/4" x h 4" • 8 1/4 oz inner 6 master 36 Calice Goblet M3557260055 8056444395617 cm 8,5* h 15,8 • 280 cc 3 1/3" x h 6 1/4" • 9 1/4 oz inner 6 master 24 Bicchiere Tumbler M3565280059 8056444395440 cm 8* h 10 • 260 cc 3 1/4" x h 4" • 8 1/4 oz inner 6 master 36 Bicchiere Tumbler M3565280007 8056444395457 cm 8* h 10 • 260 cc 3 1/4" x h 4" • 8 1/4 oz inner 6 master 36 Calice Goblet M3557260059 8056444395631 cm 8,5* h 15,8 • 280 cc 3 1/3" x h 6 1/4" • 9 1/4 oz inner 6 master 24 Calice Goblet M3557260007 8056444395648 cm 8,5* h 15,8 • 280 cc 3 1/3" x h 6 1/4" • 9 1/4 oz inner 6 master 24 marriage solid colour glass
bamboo






colori assortiti e design unico per dare alla tavola un tocco di allegria. Danno movimento grazie al decoro in rilievo sui bordi che ricorda le canne di bamboo.
assorted colors and unique design to give the table a touch of joy. They give movement thanks to the embossed decoration on the edges reminiscent of bamboo canes.







307 Bicchiere impilabile Stackable tumbler BO557240023 8056444301465 cm 8* h 8,5 · cc 245 3 1/4" x h 3 1/4" · 8 1/4 oz. inner 6 master 36 Bicchiere impilabile Stackable tumbler BO557240026 8056444301458 cm 8* h 8,5 · cc 245 3 1/4" x h 3 1/4" · 8 1/4 oz. inner 6 master 36 Bicchiere impilabile Stackable tumbler BO557240031 8056444301427 cm 8* h 8,5 · cc 245 3 1/4" x h 3 1/4" · 8 1/4 oz. inner 6 master 36 Bicchiere impilabile Stackable tumbler BO557240056 8056444301441 cm 8* h 8,5 · cc 245 3 1/4" x h 3 1/4" · 8 1/4 oz. inner 6 master 36 Bicchiere impilabile Stackable tumbler BO557240007 8056444301410 cm 8* h 8,5 · cc 245 3 1/4" x h 3 1/4" · 8 1/4 oz. inner 6 master 36 Bicchiere impilabile Stackable tumbler BO557240025 8056444301434 cm 8* h 8,5 · cc 245 3 1/4" x h 3 1/4" · 8 1/4 oz. inner 6 master 36
pasta di vetro colorato in stile vintage coloured glass paste in vintage style

















308 309 Bicchiere Tumbler A95572A0022 8056444434699 cm 8* h 10* 8 · cc 230 3 1/4" x h 4" x 3 1/4" · 7 3/4 oz. inner 6 master 48 Calice Goblet A95653D0022 8056444434798 cm 8* h 14,5* 8 · cc 270 3 1/4" x h 5 3/4" x 3 1/4" · 9 1/4 oz. inner 6 master 36 Bicchiere Tumbler A95572A0006 8056444434682 cm 8* h 10* 8 · cc 230 3 1/4" x h 4" x 3 1/4" · 7 3/4 oz. inner 6 master 48 Calice Goblet A95653D0006 8056444434781 cm 8* h 14,5* 8 · cc 270 3 1/4" x h 5 3/4" x 3 1/4" · 9 1/4 oz. inner 6 master 36 Bicchiere Tumbler A95572A0025 8056444434705 cm 8* h 10* 8 · cc 230 3 1/4" x h 4" x 3 1/4" · 7 3/4 oz. inner 6 master 48 Calice Goblet A95653D0025 8056444434804 cm 8* h 14,5* 8 · cc 270 3 1/4" x h 5 3/4" x 3 1/4" · 9 1/4 oz. inner 6 master 36 Bicchiere Tumbler A95572A0031 8056444434712 cm 8* h 10* 8 · cc 230 3 1/4" x h 4" x 3 1/4" · 7 3/4 oz. inner 6 master 48 Calice Goblet A95653D0031 8056444434811 cm 8* h 14,5* 8 · cc 270 3 1/4" x h 5 3/4" x 3 1/4" · 9 1/4 oz. inner 6 master 36
solange

















310 311 Bicchiere Tumbler A95572A0055 8056444434729 cm 8* h 10* 8 · cc 230 3 1/4" x h 4" x 3 1/4" · 7 3/4 oz. inner 6 master 48 Calice Goblet A95653D0055 8056444434828 cm 8* h 14,5* 8 · cc 270 3 1/4" x h 5 3/4" x 3 1/4" · 9 1/4 oz. inner 6 master 36 Bicchiere Tumbler A95572A0056 8056444434736 cm 8* h 10* 8 · cc 230 3 1/4" x h 4" x 3 1/4" · 7 3/4 oz. inner 6 master 48 Calice Goblet A95653D0056 8056444434835 cm 8* h 14,5* 8 · cc 270 3 1/4" x h 5 3/4" x 3 1/4" · 9 1/4 oz. inner 6 master 36 Calice Goblet A95653D0059 8056444434842 cm 8* h 14,5* 8 · cc 270 3 1/4" x h 5 3/4" x 3 1/4" · 9 1/4 oz. inner 6 master 36 Bicchiere Tumbler A95572A0059 8056444434743 cm 8* h 10* 8 · cc 230 3 1/4" x h 4" x 3 1/4" · 7 3/4 oz. inner 6 master 48 Calice Goblet A95653DTRAS 8056444434774 cm 8* h 14,5* 8 · cc 270 3 1/4" x h 5 3/4" x 3 1/4" · 9 1/4 oz. inner 6 master 36 Bicchiere Tumbler A95572ATRAS 8056444434675 cm 8* h 10* 8 · cc 230 3 1/4" x h 4" x 3 1/4" · 7 3/4 oz. inner 6 master 48 solange
pasta di vetro colorato in stile vintage coloured

















312 313 Bicchiere Tumbler C55573A0007 8056444434873 cm 8* h 10* 8 · cc 250 3 1/4" x h 4" x 3 1/4" · 8 1/2 oz. inner 6 master 48 Calice Goblet C55654A0007 8056444435016 cm 8* h 14* 8 · cc 270 3 1/4" x h 5 1/2" x 3 1/4" · 9 1/4 oz. inner 6 master 36 Bicchiere Tumbler C55573A0022 8056444434897 cm 8* h 10* 8 · cc 250 3 1/4" x h 4" x 3 1/4" · 8 1/2 oz. inner 6 master 48 Calice Goblet C55654A0022 8056444435030 cm 8* h 14* 8 · cc 270 3 1/4" x h 5 1/2" x 3 1/4" · 9 1/4 oz. inner 6 master 36 Calice Goblet C55654A0056 8056444435023 cm 8* h 14* 8 · cc 270 3 1/4" x h 5 1/2" x 3 1/4" · 9 1/4 oz. inner 6 master 36 Bicchiere Tumbler C55573A0056 8056444434880 cm 8* h 10* 8 · cc 250 3 1/4" x h 4" x 3 1/4" · 8 1/2 oz. inner 6 master 48 Bicchiere Tumbler C55573ATRAS 8056444434866 cm 8* h 10* 8 · cc 250 3 1/4" x h 4" x 3 1/4" · 8 1/2 oz. inner 6 master 48 Calice Goblet C55654ATRAS 8056444435009 cm 8* h 14* 8 · cc 270 3 1/4" x h 5 1/2" x 3 1/4" · 9 1/4 oz. inner 6 master 36
vintage style
gloria
glass paste in
pasta di vetro colorato in stile moderno e casual coloured glass paste in modern and casual style

















314 315 Bicchiere Tumbler KL557340003 8000257838908 cm 9* h 10,5* 9 · cc 340 3 1/2" x h 4 1/4" x 3 1/2" · 11 1/2 oz. inner 6 master 48 Bicchiere Tumbler KL557340022 8000257838892 cm 9* h 10,5* 9 · cc 340 3 1/2" x h 4 1/4" x 3 1/2" · 11 1/2 oz. inner 6 master 48 Bicchiere Tumbler KL557340026 8000257838885 cm 9* h 10,5* 9 · cc 340 3 1/2" x h 4 1/4" x 3 1/2" · 11 1/2 oz. inner 6 master 48 Bicchiere Tumbler KL557340031 8000257838922 cm 9* h 10,5* 9 · cc 340 3 1/2" x h 4 1/4" x 3 1/2" · 11 1/2 oz. inner 6 master 48 Bicchiere Tumbler KL557340055 8000257838861 cm 9* h 10,5* 9 · cc 340 3 1/2" x h 4 1/4" x 3 1/2" · 11 1/2 oz. inner 6 master 48 Bicchiere Tumbler KL55734TRAS 8000257838854 cm 9* h 10,5* 9 · cc 340 3 1/2" x h 4 1/4" x 3 1/2" · 11 1/2 oz. inner 6 master 48 Bicchiere Tumbler KL557340082 8000257838915 cm 9* h 10,5* 9 · cc 340 3 1/2" x h 4 1/4" x 3 1/2" · 11 1/2 oz. inner 6 master 48 Bicchiere Tumbler KL557340056 8000257838878 cm 9* h 10,5* 9 · cc 340 3 1/2" x h 4 1/4" x 3 1/2" · 11 1/2 oz. inner 6 master 48
kolors
pasta di vetro colorato dalle trasparenze eleganti coloured glass paste with elegant transparencies























316 317 Bicchiere Tumbler KL557340005 8000257838861 cm 9* h 10,5* 9 · cc 340 3 1/2" x h 4 1/4" x 3 1/2" · 11 1/2 oz. inner 6 master 48 Bicchiere Tumbler KL557340008 8000257838878 cm 9* h 10,5* 9 · cc 340 3 1/2" x h 4 1/4" x 3 1/2" · 11 1/2 oz. inner 6 master 48 Bicchiere Tumbler KL557340030 8000257838854 cm 9* h 10,5* 9 · cc 340 3 1/2" x h 4 1/4" x 3 1/2" · 11 1/2 oz. inner 6 master 48 Bicchiere Tumbler KL557340023 8000257838915 cm 9* h 10,5* 9 · cc 340 3 1/2" x h 4 1/4" x 3 1/2" · 11 1/2 oz. inner 6 master 48 Bicchiere Tumbler KL557340083 8000257838861 cm 9* h 10,5* 9 · cc 340 3 1/2" x h 4 1/4" x 3 1/2" · 11 1/2 oz. inner 6 master 48 Bicchiere Tumbler KL557340095 8000257838878 cm 9* h 10,5* 9 · cc 340 3 1/2" x h 4 1/4" x 3 1/2" · 11 1/2 oz. inner 6 master 48 Bicchiere Tumbler KL557340113 8000257838915 cm 9* h 10,5* 9 · cc 340 3 1/2" x h 4 1/4" x 3 1/2" · 11 1/2 oz. inner 6 master 48 0006 · Green-Verde 0026 · Blue-Blu 0055 · Cyclamen-Ciclamino Bicchiere Tumbler MA557230006 8056444149739 cc 230 7 3/4 oz. inner master Calice Goblet MA565260006 8056444149845 cc 260 8 3/4 oz. inner master Bicchiere Tumbler MA557230026 8056444149746 cc 230 7 3/4 oz. inner master Calice Goblet MA565260026 8056444149852 cc 260 8 3/4 oz. inner master Bicchiere Tumbler MA557230055 8056444149722 cc 230 7 3/4 oz. inner master Calice Goblet MA565260055 8056444149838 cc260 8 3/4 oz. inner master madame
cookware serrano starbamboo tools

WP758P1BTBF
8000257305493
cm 32* h 5,5* 62,5 · cc 3080
Padella 1 manico Pan 1 handle
12 1/2" x h 2 1/4" x 24 1/2" · 104 1/4 oz.
WP758P8BTBF
8000257306261 cm 28* h 5* 53,5 · cc 1980 11" x h 2" x 21" · 67 oz.
WP758P6BTBF
8000257305455
cm 24* h 4,5* 46 · cc 1370
9 1/2" x h 1 3/4" x 18" · 46 1/4 oz.
WP758P4BTBF




8000257305394
cm 20* h 4* 40 · cc 730
Padella 1 manico Aluminium pan 1 handle
Padella 1 manico Aluminium pan 1 handle
Padella 1 manico Aluminium pan 1 handle

7 3/4" x h 1 1/2" x 15 3/4" · 24 3/4 oz.
inner 1 master 4
inner 1 master 4
inner 1 master 4
inner 1 master 4
WP758B5BTBF
Padella
Padella alta 1 manico Deep pan 1 handle
Padella alta 1 manico Deep pan 1 handle



corpo in alluminio, fondo ad alto spessore adatto anche all'induzione, rivestimento esterno resistente alle alte temperature, rivestimento interno rinforzato e manico ergonomico in acciaio inox alluminium body, very thick bottom also suitable for induction, external coating resistant to high temperatures, internal coating reinforced and ergonomic stainless steel handle

WP758B3BTBF 8056444014594 cm 24* h 6,5* 45,5 · cc 2380 9 1/2" x h 2 1/2" x 18" · 80 1/2 oz. inner 1 master 4
11"
2 3/4"
inner
8000257305530 cm 28* h 7* 53,5 · cc 3300
x h
x 21" · 111 1/2 oz.
1 master 4
cm
12 1/2"
h 3"
1/2"
oz. inner
4
Padella alta 1 manico Deep pan 1 handle WP758B7BTBF 8000257305578
32* h 7,5* 62,5 · cc 6000
x
x 24
· 203
1 master
alta 1 manico Deep pan 1 handle
cm
h 8* 72 14 1/4" x h 3 1/4" x 28 1/4" inner 1 master 4 Casseruola 1 manico Saucepan 1 handle WP758H2BTBF 8000257305899 cm 16* h 8* 33 · cc 1360 6 1/4" x h 3 1/4" x 13" · 46 oz. inner 1 master 4 Casseruola 1 manico Saucepan 1 handle WP758H4BTBF 8000257305943 cm 20* h 11* 39 · cc 3070 7 3/4" x h 4 1/4" x 15 1/4" · 103 3/4 oz. inner 1 master 4 Casseruola 1 manico Saucepan 1 handle WP758H6BTBF 8000257937366 cm 24* h 13* 45,5 · cc 6000 9 1/2" x h 5" x 18" · 203 oz. inner 1 master 4 Casseruola 2 manici Double handled casserole WP7581GBTBF 8000257306100 cm 28* h 16* 37,5 · cc 8200 11" x h 6 1/4" x 14 3/4" · 277 1/4 oz. inner 1 master 4 Casseruola 2 manici Double handled casserole WP7581JBTBF 8000257306124 cm 32* h 18* 41,5 · cc 1200 12 1/2" x h 7" x 16 1/4" · 40 1/2 oz. inner 1 master 4 320 321 pro
WP758B8BTBF 8000257305639
36*
diamond
INDUZIONE INDUCTION









Tegame 2 manici Double handled skillet WP7583VBTBF 8000257305677 cm 28* h 6,5* 38,5 · cc 3000 11" x h 2 1/2" x 15 1/4" · 101 1/2 oz. inner 1 master 4 Tegame 2 manici Double handled skillet WP7583FBTBF 8000257305714 cm 32* h 7,5* 42,5 · cc 4250 12 1/2" x h 3" x 16 3/4" · 143 3/4 oz. inner 1 master 4 Tegame 2 manici Double handled skillet WP7583HBTBF 8000257305752 cm 36* h 8* 45,5 · cc 1400 14 1/4" x h 3 1/4" x 18" · 47 1/4 oz. inner 1 master 4 Pentola 2 manici High pot WP75808BTBF 8000257306148 cm 28* h 22* 37,5 · cc 11800 11" x h 8 3/4" x 14 3/4" · 399 oz. inner 1 master 4 Pentola 2 manici High pot WP75810BTBF 8000257306247 cm 32* h 24* 41 · cc 13200 12 1/2" x h 9 1/2" x 16 1/4" · 446 1/4 oz. inner 1 master 4 Crepiera Crepe pan WP758CRBTBF 8056444014617 cm 28* h 1,6* 54 11" x h 3/4" x 21 1/4" inner 1 master 4 Wok 1 manico Wok 1 handle WP758R3BTBF 8056444087819 cm 30* h 9* 58 11 3/4" x h 3 1/2" x 22 3/4" inner 1 master 4 322 323 pro diamond

















Wok 1 manico Wok 1 handle WX7583WBIFA 8056444156928 cm 32 · cc 5400 12,5" · 182,5 oz. inner 1 master 4 Paella pan Paella pan WX7583JBIFA 8056444156805 cm 34 · cc 300 13,5" · 10 1/4 oz. inner 1 master 4 Lasagnera Roaster WX74140BIFA 8056444156959 cm 48* h 6,5* 28 · cc 7800 19" x h 2 1/2" 11" · 263 3/4 oz. inner 1 master 4 Pentola 2 manici Hig pot WX75808BIFA 8056444156621 cm 28 · cc 7800 11" · 263 3/4 oz. inner 1 master 4 Casseruola 2 manici Double handled casserole WX75820BIFA 8056444156713 cm 32 · cc 8200 12,5" · 277 1/4 oz. inner 1 master 4 inner master Casseruola 1 manico cm 22 Casserole 1 handle cm 22 WX758H5BIFA 8056444203004 cm 22 · cc 2900 8 1/2" · 98 oz. Padella alta 1 manico Deep pan 1 handle WX758B8BIFA 8056444156683 cm 36 · cc 5600 14 1/4" · 189 1/4 oz. inner 1 master 4 Padella alta 1 manico Deep pan 1 handle WX758B7BIFA 8056444156669 cm 32 · cc 3700 12,5" · 125 oz. inner 1 master 4 Padella alta 1 manico Deep pan 1 handle WX758B3BIFA 8056444343960 cm 24 · cc 2100 9 ½ “ · 71 oz. inner 1 master 4 Padella alta 1 manico Deep pan 1 handle WX758H8BIFA 8056444202946 cm 28 · cc 3470 11" · 11 3/4 oz. inner 1 master 4 Tegame 2 manici Double handled skillet WX7583HBIFA 8056444156775 cm 36 · cc 3600 14 1/4" · 121 3/4 oz. inner 1 master 4 Tegame 2 manici Double handled skillet WX7583FBIFA 8056444156744 cm 32* · cc 4300 12,5" · 145 1/2 oz. inner 1 master 4 Tegame 2 manici Double handled skillet cm 28* · cc 7800 11" · 263 3/4 oz. WX7583VBIFA 8056444202977 inner 1 master 4 324 325 big
pressed aluminum - non stick INDUZIONE INDUCTION
family













Padella 2 manici Double handled pan V5758P9INSL 8056444087529 cm 31,5* h 8,5* 53 · cc 5000 12 1/4" x h 3 1/4" x 20 3/4" · 169 oz. inner 1 master 6 Tegame 2 manici Double handled pan V575838INSL 8000257340890 cm 28* h 7,5* 36,5 · cc 3800 11" x h 3" x 14 1/4" · 128 1/2 oz. inner 1 master 6 Tegame 2 manici Double handled pan V575836INSL 8000257340876 cm 24* h 6* 34 · cc 2200 9 1/2" x h 2 1/4" x 13 1/2" · 74 1/2 oz. inner 1 master 6 Padella 1 manico Pan 1 handle V5758P7INSL 8056444087505 cm 28* h 7,3* 46 · cc 3180 11" x h 2 3/4" x 18" · 107 1/2 oz. inner 1 master 6 Padella 1 manico Pan 1 handle V5758P5INSL 8056444087482 cm 23,5* h 6,2* 41,5 · cc 2000 9 1/4" x h 2 1/2" x 16 1/4" · 67 3/4 oz. inner 1 master 6 Pentola 2 manici Double handled pot V575808INSL 8000257340838 cm 28* h 19* 36,5 · cc 10000 11" x h 7 1/2" x 14 1/4" · 338 1/4 oz. inner 1 master 6 Pentola 2 manici Double handled pot V575803INSL 8000257340517 cm 18* h 14* 27 · cc 2900 7" x h 5 1/2" x 10 3/4" · 98 oz. inner 1 master 6 Pentola 2 manici Double handled pot V575804INSL 8000257340555 cm 20* h 16* 29,5 · cc 4200 7 3/4" x h 6 1/4" x 11 1/2" · 142 oz. inner 1 master 6 Pentola 2 manici Double handled pot V575805INSL 8000257765426 cm 22* h 15,5* 31,5 · cc 5000 8 3/4" x h 6" x 12 1/2" · 169 oz. inner 1 master 6 Pentola 2 manici Double handled pot V575806INSL 8000257340807 cm 24* h 20* 33,5 · cc 6200 9 1/2" x h 7 3/4" x 13 1/4" · 209 3/4 oz. inner 1 master 6 Casseruola 1 manico Saucepan 1 handle V5758H1INSL 8000257765419 cm 15* h 7,2* 30 · cc 950 6" x h 2 3/4" x 11 3/4" · 32 oz. inner 1 master 6 Casseruola 1 manico Saucepan 1 handle V5758H2INSL 8000257340845 cm 17,5* h 8,5* 31,5 · cc 1400 6 3/4" x h 3 1/4" x 12 1/2" · 47 1/4 oz. inner 1 master 6 Bollilatte Milk pan V57584BINSL 8000257340982 cm 12* h 11* 16,5 · cc 1000 4 3/4" x h 4 1/4" x 6 1/2" · 33 3/4 oz. inner 1 master 6 326 327
corpo, coperchi e manici in acciaio inox 18/10, fondo multistrato termoradiante acciaio/alluminio/ acciaio stainless steel body, lids and handles 18/10, steel/aluminium/ steel multi-layer radiant bottom INDUZIONE INDUCTION
vanitosa
Casseruola 2 manici Double handled casserole V57581AINSL
















Coperchio Lid V545880INSL 8056444054248 cm 36* h 6,5* 36 14 1/4" x h 2 1/2" x 14 1/4" inner 1 master 6 Coperchio Lid V545867INSL 8000257765402 cm 26* h 5* 26 10 1/4" x h 2" x 10 1/4" inner 1 master 6 Coperchio Lid V545866INSL 8000257339948 cm 24* h 4,5* 24 9 1/2" x h 1 3/4" x 9 1/2" inner 1 master 6 Coperchio Lid V545868INSL 8000257339993 cm 28* h 5* 28 11" x h 2" x 11" inner 1 master 6 Coperchio Lid V545870INSL 8056444054224 cm 32* h 6,5* 32 12 1/2" x h 2 1/2" x 12 1/2" inner 1 master 6 Coperchio Lid V545865INSL 8000257765396 cm 22* h 5* 22 8 3/4" x h 2" x 8 3/4" inner 1 master 6 Coperchio Lid V545861INSL 8000257339894 cm 14* h 4* 14 5 1/2" x h 1 1/2" x 5 1/2" inner 1 master 6 Coperchio Lid V545862INSL 8000257339917 cm 16* h 4* 16 6 1/4" x h 1 1/2" x 6 1/4" inner 1 master 6 Coperchio Lid V545863INSL 8000257765389 cm 18* h 5* 18 7" x h 2" x 7" inner 1 master 6 Coperchio Lid V545864INSL 8000257339924 cm 20* h 4,5* 20 7 3/4" x h 1 3/4" x 7 3/4" inner 1 master 6 Set 3 pezzi spaghetti 3-pc spaghetti cooker set V5758Y2INSL 8000257661049 cm 22* h 27* 32 · cc 5600 8 3/4" x h 10 3/4" x 12 1/2" · 189 1/4 oz. inner 1 master 4 Pastapot - set 2 pezzi 2 pcs set pastapot V5758Y3INSL 8056444102949 cm 22* · cc 4600 8 5/8" · 4.86 oz. inner 1 master 4 Set 3 pezzi vapor 3 pcs vapor V5758Y1INSL 8000257660998 cm 22* · cc 4600 8 3/4" x · 15 1/2 oz. inner 1 master 4 Scolapasta Colander V545877INSL 8056444054200 cm 22* h 13* 22 8 3/4" x h 5" x 8 3/4" inner 1 master 6 Casseruola 2 manici Double handled casserole V575815INSL 8000257765440 cm 22* h 12,3* 31,5 · cc 4050 8 3/4" x h 4 3/4" x 12 1/2" · 137 oz. inner 1 master 6 Casseruola 2 manici Double handled casserole V575816INSL 8000257340043 cm 24* h 11,5* 34 · cc 4800 9 1/2" x h 4 1/2" x 13 1/2" · 162 1/4 oz. inner 1 master 6 Casseruola 2 manici Double handled casserole V575818INSL 8000257340289 cm 28* h 12* 36,5 · cc 5500 11" x h 4 3/4" x 14 1/4" · 186 oz. inner 1 master 6
8000257340036 cm 20* h 9,5* 29,5 · cc 2800 7 3/4" x h 3 3/4" x 11 1/2" · 94 3/4 oz. inner 1 master 6
8000257765433 cm 18* h 10,5* 27,3 · cc 2290 7" x h 4 1/4" x 10 3/4" · 77 1/2 oz. inner 1 master 6
Casseruola 2 manici Double handled casserole V575813INSL
8000257340005 cm 16* h 8* 25 · cc 1400 6 1/4" x h 3 1/4" x 9 3/4" · 47 1/4 oz. inner 1 master 6 328 329 vanitosa
Casseruola 2 manici Double handled casserole V575812INSL








Grill Grill W8458GAFUTA 8056444204902 cm 33* 20,5 13" x 8" inner 1 master 6 Grill Grill W8458GBFUTA 8056444204933 cm 38* h * 22,5 15" x 8 3/4" inner 1 master 6 Casseruola Casserole W8458GCFUTA 8056444204964 cm h 9,5* 19 · cc 1450 h 3 3/4" x · 7 1/2 oz. inner 1 master 6 330 331
fusion taste
Cast iron & beech wood
fusion taste

















Tegamino tondo Round pan W8458X3FUTA 8056444127621 cm 14* h 3* 17,5 · cc 280 5 1/2" x h 1 1/4" x 7" inner 6 master 6 Tegamino tondo Round pan W8458X4FUTA 8056444127645 cm 11* h 3* 16 · cc 220 4 1/4" x h 1 1/4" x 6 1/4" inner 6 master 6 Tegamino ovale Oval pan W8458X5FUTA 8056444127669 cm 11* h 3* 22 · cc 300 4 1/4" x h 1 1/4" x 8 3/4" inner 6 master 6 Padella grill Grill pan W8458X6FUTA 8056444127683 cm 12,5* h 3* 20 · cc 260 5" x h 1 1/4" x 7 3/4" inner 6 master 6 Padella quadra Square pan W8458X7FUTA 8056444127706 cm 14,5* h 2,7* 14,5 · cc 300 5 3/4" x h 1" x 5 3/4" inner 6 master 6 Padella Pan W8458X8FUTA 8056444127720 cm 15* h 3,3* 25,5 · cc 380 6" x h 1 1/4" x 10" inner 6 master 6 Padella tonda Round pan W8458X1FUTA 8056444127362 cm 21* h 2,5* 21 · cc 530 8 1/4" x h 1" x 8 1/4" inner 6 master 6 Padella ovale Oval pan W8458X2FUTA 8056444127584 cm 32* h 2* 17 · cc 380 12 1/2" x h 3/4" x 6 3/4" inner 6 master 6 ** * ** ** * * * * * * Con manico amovibile e sottopentola in legno With removable handle and wooden trivet Con manico fisso e sottopentola in legno With fixed handle and wooden trivet 332 333
starter kit 18pz
Wi99118aMnF
contiene / contains:
1 - Wi7aK37Uten coltello pane / bread knife
2 - Wi7aK39Uten coltello multiuso / utility knife
3 - Wi7aK42Uten coltello sbucciatore / peeling knife
4 - Wi7aK51Uten set 6 coltelli / 6 pcs set table knife
5 - Wi4aJ86Uten apriscatole / can opener
6 - Wi4aJ90Uten levatappi cameriere / steel waiter corkscrew
7 - Wi4aJ94Uten pinza insalata / steel salad tong

8 - Wi4aJ98Uten grattugia verticale acciaio / steel 4 sided grater
9 - Wi4aK31Uten forbice multiuso / scissor multifunction
10 - Wi9aD48Uten mestolo nylon / nylon ladle
11 - Wi9aD51Uten spatola nylon / nylon turner
12 - Wi9aD52Uten cucchiaio nylon / nylon spoon
13 - Wi9aD53Uten servispaghetti nylon / nylon spaghetti server
14 - Wi9aD58Uten schiumarola nylon / nylon skimmer
15 - Wi9aK20Uten brocca 1000 ml / ps measuring cup 1000 ml
16 - Wi9aK21Uten scola pasta pp / pp colander
17 - Wi9aK25Uten sottopentola silicone cm 15/ silicone
placemat 15 cm
18 - Wi9aK81Uten tagliere grigio 34x25 pp / pp cuting board
34x25 cm
334 335
10 15 1 6 4 3 14 9 5 13 11 12 16 18 8 7 2 17








Set 2 tovagliette goccia + 2 sottobicchieri Set of 2 drop placemats + set of 2 coasters E1YTO26SERR 8056444283532 Ecopelle Eco-friendly leather inner 2 master 20 Grembiule con tasca no pettorina Apron E1YGR17SERR 8056444337808 cm 70 * 60 27 1/2” x 24 inner 2 master 20 Grembiule con pettorina Chest Apron E1YGR15SERR 8056444283471 cm 70 * 85 27 1/2" x 33 1/4" inner 2 master 20 Tovaglietta americana Place mat E1YTO25SERR 8056444283501 cm 35* h 0,1* 45 13 3/4" x 17 3/4" inner 6 master 30 336 337
MADE IN ITALY ecopelle eco-friendly leather
serrano
Tagliere da portata Chopping board serving




Tagliere rettangolare Rectangular chopping SJ8TAH1243A
rotondo Round tray



8056444367898 cm
29
SJ8TAH3243A
75* h 1,5* 15
1/2" x h 3/5" x 6" inner 6 master 6
8056444367805 49
19 1/4"
1/2"
8056444367850 cm
15 3/4"
3/5"
338 339
natural teak wood
x h 1,5 x 24 cm
x h 3/5" x 9
inner 6 master 6 Serving
SJ8TAH2243A
40 x h 1,7
x
inner 6 master 6
starbamboo




















Tagliere rotondo girevole Revolving board SJ8TA09263A 8056444295641 cm 30* h 4* 11 3/4" x h 1 1/2" inner 6 master 6 Tagliere rotondo girevole Revolving board SJ8TA10263A 8056444295665 cm 40* h 4,5* 15 3/4" x h 1 3/4" inner 4 master 4 Tagliere incavo rettangolare Rectangular cutting board SJ8TA13263A 8056444295726 cm 44* h 2* 20 17 1/4" x h 3/4" x 7 3/4" inner 12 master 12 Tagliere rettangolare Rectangular cutting board SJ8TA16263A 8056444295702 cm 47* h 2* 17 18 1/2" x h 3/4" x 6 3/4" inner 8 master 8 Tagliere rettangolare Rectangular cutting board SJ8TA19263A 8056444295689 cm 38* h 2* 31 15 " x h 3/4 " x 12 1/4 " inner 8 master 8 Tagliere in bamboo cm 30x20 Bamboo cutting board 30x20 WI8AK83UTEN 8056444164015 inner 6 master 36 Tagliere in bamboo cm 34x25 Bamboo cutting board 34x25 WI8AK84UTEN 8056444164053 inner 6 master 36 Tagliere in bamboo cm 39x28 Bamboo cutting board 39x28 WI8AK85UTEN 8056444164091 inner 6 master 36 Tagliere rettangolare Rectangular cutting board SJ8TAE9ACAC 8056444144642 cm 47 * h 1,5 *24 18 1/2" x h 1/2" x 9 1/2 inner master Tagliere rettangolare Rectangular cutting board SJ8TAF1ACAC 8056444144673 cm 51 * h1,5 * 19 20" x h 1/2" x 7 1/2" inner master Serving rotondo Round tray SJ8TAH5243A 8056444372380 cm 28 x h 1,7 11" x 3/5" inner 12 master 12 Serving rotondo Round tray SJ8TAH6243A 8056444372410 cm 33 x h 1,7 13" x 3/5" inner 8 master 8 340 341

















Coltello pane Bread knife WI7AK37UTEN 8000257330167 cm 32* h 20 lama* 3 12 1/2" x h 7 3/4" x 1 1/4" inner 6 master 48 Coltello intaglio Carving knife WI7AK38UTEN 8000257330181 cm 33* h 20 lama* 3 13" x h 7 3/4" x 1 1/4" inner 6 master 48 Coltello multiuso Utility-knife WI7AK39UTEN 8000257330266 cm 32* h 20 lama* 4 12 1/2" x h 7 3/4" x 1 1/2" inner 6 master 48 Coltello chef Chef knife WI7AK40UTEN 8000257330303 cm 28* h 15 lama* 4 11" x h 6" x 1 1/2" inner 6 master 48 Coltello santoku Santoku knife WI7AK41UTEN 8000257330365 cm 30* h 18 lama* 4 11 3/4" x h 7" x 1 1/2" inner 6 master 48 Coltello sbucciatore Peeling knife WI7AK42UTEN 8000257330457 cm 18* h 7 lama* 2 7" x h 2 3/4" x 3/4" inner 6 master 48 Coltello disosso Boning knife WI7AK36UTEN 8000257330099 cm 27* h 15 lama* 4 10 3/4" x h 6" x 1 1/2" inner 6 master 48 Coltello prosciutto cm 26 Ham knife 26 cm WI7KR26UTEN 8056444055122 inner 6 master 48 342 343 tools























8056444070590 cm 22* h 11 lama* 2 8 3/4" x h 4 1/4" x 3/4" inner 12 master 48
pcs
8056444072310 inner 12 master 48
WI7AK32UTEN 8000257328065 cm 11* h 21* 2 4 1/4" x h 8 1/4" x 3/4" inner 12 master 48
WI7AK53UTEN 8056444072334 inner 12 master 48
Set 6 pezzi coltello tavolo nero 6-black-table-knife set WI7AK51UTEN
Set 6 pz coltelli tavola rosso 6
set table knife handle red WI7AK52UTEN
Set 6 pezzi coltelli steak 6-pc-steak-knife set
Set 6 pz coltelli tavola bianco 6 pcs set table knife handle white
WI7AK35UTEN 8000257328492 cm 12* h 2* 22,5 4 3/4" x h 3/4" x 8 3/4" inner 12 master 48
Set 4 pz coltelli steak churras 4-pc-steak-knife set
WI7AK95UTEN
inner
master
Set 6 coltelli spelucc.nero 6pcs knife black
8056444164497
12
48
8056444164336 inner 6 master 36
spoon
WI7AK92UTEN 8056444164374 inner 12 master 48
8056444163896 inner 6 master 36 Tagliere
Grey
WI9AK81UTEN 8056444163933 inner 6 master 36 Tagliere
Grey
WI9AK82UTEN 8056444163971 inner 6 master 36 344 345
Set 6 forchette nero riv 6 steel forks black WI7AK91UTEN
Set 6 cucchiai nero riv 6pcs
black
Tagliere grigio cm 30x17 pp Grey cutting board 30x17 WI9AK80UTEN
grigio cm 34x25 pp
cutting board 34x25
grigio cm 39x28 pp
cutting board 39x28
verticale triang.
inox con manico in pp
etching small








etching long small Long grater etching smal









Grattugia
Steel triang. vert.
WI4AK66UTEN 8056444163339 inner 6 master 72 Grattugia verticale 4 sided grater WI4AJ98UTEN 8000257325804 cm 9,5* h 23* 7 3 3/4" x h 9" x 2 3/4" inner 6 master 48 Grattugia
Grater abs
WI4AJ99UTEN 8000257326269 cm 33* h 4* 13 13" x h 1 1/2" x 5" inner 6 master 72 Grattugia
Grater etching small WI4AJ74UTEN 8000257324753 inner 6 master 72 Grattuggino Mini grater WI4AK60UTEN 8056444163094 inner 6 master 72 Grattuggia etching medium Grater etching medium WI4AJ75UTEN 8000257324777 inner 6 master 72 Grattuggia
WI4AJ76UTEN 8000257324791 inner 6 master 72 Grattuggia stching long medium Long grater etching medium WI4AJ77UTEN 8000257324814 inner 6 master 72 346 347 tools
grater
handle
WI9AK75UTEN 8056444163698 inner 6 master 72
WI4AK31UTEN 8000257327921
cm 20* h 1* 8,5 7 3/4" x h 1/2" x 3 1/4"

Sottopentola silic.d.cm18 Silicone pot holder d. cm18
Forbice multiuso Multifunction scissor
inner 6 master 72
WI9AK25UTEN 8000257327570
cm 14,5* h 0,5* 14,5 5 3/4" x h 1/4" x 5 3/4"


Sottopentola silicone Silicone placemat
inner 6 master 72
Set 6 stampi cuore per biscotti 6 heart shape cookie cutter set

WI4AK69UTEN 8056444163452 inner 6 master 72
Forbice grande cm 23 Steel big size scissors 23





WI4AK30UTEN 8000257327891
cm 25* h 1,5* 5
Trinciapolli Chicken bones scissors
inner 6 master 48















Forbice media cm 20 Steel medium size scissor
WI4AK70UTEN 8056444163490 inner 6 master 72
WI7AG63UTEN 8056444055146 inner 6 master 72 Set 3 proteggi pentola cm 28-32-36 3 frypan protector set cm 28-32-36 WI9AG65UTEN 8056444055184
WI7AG64UTEN 8056444055160 inner 6 master 72
Set 6 stampi stella per biscotti 6 star shape cookie cutter set


Set 3 pz.coppaps.cm6-8-10 3 pc food shaper rd 6/8/10

WI4AJ97UTEN 8000257325781 inner 6 master 48
WI4AJ96UTEN 8000257325767 inner 6 master 48
Spargifarina Flour-sifter


Sacco pasticcere + 5 ugelli 5 nozzles pastry bag

WI9AK17UTEN 8000257327136 inner 6 master 72
WI9AK18UTEN 8000257327174 inner 6 master 36
Siringa pasticc.+ 7 ugelli 7 nozzles pastry bag
Forbice piccola cm 17 Small size scissors cm17
WI4AK71UTEN 8056444163537 inner 6 master 72
WI9AD67UTEN 8000257314228 inner 6 master 72
Pinza chef nylon Nylon chef tongs
inner 24 master 48
9 3/4" x h 1/2" x 2" 348 349
































Schiumarola nylon Nylon skimmer WI9AJ54UTEN 8000257314662 inner 6 master 72 Cucchiaio nylon Nylon spoon WI9AJ53UTEN 8000257314532 inner 6 master 72 Servispaghetti nylon Nylon spaghetti server WI9AJ57UTEN 8000257315119 inner 6 master 72 Frusta nylon Nylon whisk WI9AJ59UTEN 8000257320007 inner 6 master 72 Spatola nylon Nylon spoon turner WI9AJ56UTEN 8000257314983 inner 6 master 72 Spatola nylon crepes Nylon scraper for crepes WI9AG29UTEN 8000257989754 inner 6 master 72 Mestolo nylon Nylon ladle WI9AJ55UTEN 8000257314686 inner 6 master 72 Spatola lasagne nylon Nylon lasagna server WI9AJ58UTEN 8000257316062 inner 6 master 72 Cucchiaio Spoon WI4AJ60UTEN 8000257321929 inner 6 master 72 Schiumarola Skimmer WI4AJ61UTEN 8000257321998 inner 6 master 72 Mestolo Ladle WI4AJ62UTEN 8000257323138 inner 6 master 72 Spatola Turner WI4AJ63UTEN 8000257323299 inner 6 master 72 Tagliapasta doppio Pasta crimper WI4AJ67UTEN 8000257324104 inner 6 master 72 Servispaghetti Spaghetti server WI4AJ64UTEN 8000257323336 inner 6 master 72 Cucchiaio gelato Ice cream spoon WI4AJ66UTEN 8000257323985 inner 6 master 72 Frusta Whisk WI4AJ65UTEN 8000257323817 inner 6 master 72 350 351
Stampo pasta d.30 mm Pasta cutter round 30 mm
WI4AJ68UTEN 8000257324487 inner 6 master 72
WI4AJ69UTEN 8000257324517 inner 6 master 72
Stampo pasta d.45 mm Pasta cutter round 45 mm
Colino 75 mm Strainer 75 mm



WI4AJ78UTEN 8000257324838 inner 6 master 72
Colino 100 mm Strainer 100 mm WI4AJ79UTEN 8000257324869 inner 6 master 72
Stampo pasta q.45 mm Pasta cutter square 45 mm
WI4AJ70UTEN 8000257324531 inner 6 master 72
WI4AJ71UTEN 8000257324555 inner 6 master 72
Tagliapizza Pizza cutter with wheel






Colino 150 mm Strainer 150 mm
WI4AJ80UTEN 8000257325200 inner 6 master 72
WI4AK22UTEN 8000257327518 inner 6 master 72
Riduttore gas 2 pz. Gas safety stars

WI4AJ72UTEN 8000257324579 inner 6 master 72
Sbucciapatate vert. Potato peeler w/blade
Batticarne Meat-tenderizer


WI4AJ73UTEN 8000257324654 inner 6 master 72
Filtro the Tea ball WI4AK23UTEN 8000257327532 inner 6 master 72
V54AG66RIFL 8056444055474 cm 20* h 3* 20 7 3/4" x h 1 1/4" x 7 3/4"
Piastra rid. Induzione Induction adapter
inner 6 master 24
















Sbucciapatate lama orizz. Peeler
WI4AJ81UTEN 8000257325316 inner 6 master 72
WI4AJ82UTEN 8000257325347 inner 6 master 72
Spremiaglio acciaio Steel garlic press


Spatola legno Bamboo wooden solid turner
WI8AK43UTEN 8000257331522 inner 12 master 72
Cucchiaio legno Bamboo wooden solid spoon WI8AK44UTEN 8000257331546 inner 12 master 72


352 353
8056444162851
8056444162936
6 master 72 Svuotatorsoli Steel core reducer
6 master 72
8056444163056
WI9AK15UTEN
inner 6 master 72
WI9AK19UTEN
WI9AK20UTEN













6 master 36
Brocca graduata 1000 ml Ps measuring cup 1000 ml


6 master 36
8000257327556 inner 6 master 72
Lacci silicone cm 20 - 6 pz 6 pcs silicone bandage
Tappo silicone Silicone stopper WI9AK26UTEN 8000257327594

Spremilimone ps Lemon squeezer






8000257327617 inner 12 master 72
Sbucciat. multiuso-set 3 pz Set 3 multi use peelers WI4AK28UTEN 8000257327631 inner 6 master 72

Clips sacchetti set 3 pz 3 pcs magnetic bag clips


WI4AK29UTEN 8000257327853 inner 12 master 72

WI9AK24UTEN
inner 6 master 96
WI9AK27UTEN
inner
Brocca graduata 500 ml Ps measuring cup 500 ml inner
8000257327204
8000257327228
WI9AK54UTEN
inner
Schiacciapatate
WI4AK55UTEN
inner
Spazzola lavaggio Brush cleaner
6 master 72
Potato masher
8056444162899
6 master 72
WI4AK56UTEN
inner
WI4AK58UTEN
inner
Svuotazucchine Steel zucchine reducer
8056444163018
WI4AK59UTEN
inner
Paletta a servire Steel pizza/cake server
6 master 72
354 355
Pennello silicone Silicone brush
8000257327006





















Taglia pizza grande cm 10 Big pizza cutter cm 10 WI4AK61UTEN 8056444163131 inner 6 master 72 Appoggia mestoli Set 2 ladle holders WI9AK63UTEN 8056444163216 inner 6 master 72 Cucchiai insalata Set 2 salad spoons WI9AK64UTEN 8056444163254 inner 6 master 72 Taglia uova Plastic egg cutter WI9AK65UTEN 8056444163292 inner 6 master 72 Servi miele Honey mixing stick WI9AK67UTEN 8056444163377 inner 6 master 72 WI9AK68UTEN 8056444163414 Separatore uova Ps egg separator inner 6 master 72 Termom.cucina dig.+spat.sil Thermometer + silic.spatula WI9AK96UTEN 8056444164534 inner 12 master 48 Sbuccia aglio in silicone Rubber garlic peeler WI9AK74UTEN 8056444163650 inner 6 master 72 Paraspruzzi cm 33 Steel splash guard cm 33 WI4AK78UTEN 8056444163810 inner 6 master 36 Paraspruzzi cm 29 Steel splash guard cm 29 WI4AK79UTEN 8056444163858 inner 6 master 36 356 357
Set 4 pz. tappi vino plast. 4pcs plastic wine pourer
WI9AK72UTEN 8056444163575 inner 6 master 72
WI9AK73UTEN 8056444163612 inner 6 master 36
Pistola biscotti + 6 forme Set cookie syringe + tools
basic
Macinapepe cm 20 lame ceram Pepper mill cm 20

WI9AK76UTEN 8056444163735 inner 6 master 36
WI9AK77UTEN 8056444163773 inner 6 master 36
Macinapepe cm 15 lame ceram Pepper mill cm 15


Rullo silicone e legno cm44 Silicone + wood roller 44cm
WI9AK86UTEN 8056444164138 inner 6 master 36
WI4AK89UTEN 8056444164251 inner 6 master 36
Setac.farina ss cm18 c/asol Steel flour sifter 18x5

basic
Set 3 imbuti pp d.5/6,5/8,5 Set 3 plastic funnels



WI9AK90UTEN 8056444164299 inner 6 master 36
Levatappi corona & cameriere
















cameriere & coltello Waiter corkscrew w/ knife WI4AJ91UTEN 8000257325668 cm 11* h 1,5* 3









Pinza
Steainless steel food tong WI4AJ92UTEN 8000257325682 cm 30* h 1,5* 1 11 3/4" x h 1/2" x 1/2" inner 6 master 72 Rompinoci/crostacei
Basic nut/lobster
WI4AJ83UTEN 8000257325507 cm 15* h 1* 3,5 6" x h 1/2" x 1 1/2" inner 6 master 72 Rompinoci/crostacei elite Elite nut/lobster cracker WI4AJ84UTEN 8000257325521 cm 17* h 1,5* 4 6 3/4" x h 1/2" x 1 1/2" inner 6 master 72 Apriscatole
Basic can opener WI4AJ85UTEN 8000257325545 cm 14,5* h 3,5* 6 5 3/4" x h 1 1/2" x 2 1/4" inner 12 master 72 Apriscatole elite Elite can opener WI4AJ86UTEN 8000257325569 cm 20* h 4* 6 7 3/4" x h 1 1/2" x 2 1/4" inner 6 master 72 Apribottiglie
Basic corkscrew WI4AJ87UTEN 8000257325583 cm 16* h 4* 6 6 1/4" x h 1 1/2" x 2 1/4" inner 6 master 72 Apribottiglie
Elite corkscrew WI4AJ89UTEN 8000257325620 cm 19* h 4* 7 7 1/2" x h 1 1/2" x 2 3/4" inner 6 master 72
chef
cracker
basic
elite
WI4AJ90UTEN 8000257325644 cm 14* h 0,5* 4 5 1/2" x h 1/4" x 1 1/2" inner 12 master 72 Levatappi
Stainless steel waiter corkscrew
4 1/4" x h 1/2" x 1 1/4" inner 12 master 72
358 359




























Mestolo nylon Nylon ladle WI9AD48UTEN 8000257314280 cm 32* h 9* 9,5 12 1/2" x h 3 1/2" x 3 3/4" inner 6 master 72 Spatola nylon Nylon turner WI9AD51UTEN 8000257314389 cm 35* h 6* 9 13 3/4" x h 2 1/4" x 3 1/2" inner 6 master 72
nylon Nylon spoon WI9AD52UTEN 8000257314242 cm 33* h 2* 6,5 13" x h 3/4" x 2 1/2" inner 6 master 72 Servispaghetti
Nylon spaghetti server WI9AD53UTEN 8000257314471 cm 33* h 7* 9 13" x h 2 3/4" x 3 1/2" inner 6 master 72
Nylon skimmer WI9AD58UTEN 8000257314266 cm 34* h 7* 11,5 13 1/2" x h 2 3/4" x 4 1/2" inner 6 master 72 Spatola
Silicone spatula WI9AK16UTEN 8000257327099 cm 25,5* h 1* 6 10" x h 1/2" x 2 1/4" inner 6 master 72
Pp colander WI9AK21UTEN 8000257327358 cm 19* h 11,5* 19 7 1/2" x h 4 1/2" x 7 1/2" inner 6 master 36 Cucchiaio acciaio inox Stainless steel spoon V54AG68RIFL 8056444055511 cm 41,5* h 0,25* 7,5 16 1/4" x h 1/8" x 3" inner 6 master 48 Mestolo acciaio inox Stainless steel ladle V54AG69RIFL 8056444055535 cm 38* h 0,25* 10 15" x h 1/8" x 4" inner 6 master 48 Servispaghetti acciaio inox Stainless steel spaghetti server V54AG70RIFL 8056444055559 cm 41* h 0,25* 7 16 1/4" x h 1/8" x 2 3/4" inner 6 master 48 Schiumarola acciaio inox Stainless steel skimmer V54AG71RIFL 8056444055573 cm 40,2* h 0,25* 10,5 15 3/4" x h 1/8" x 4 1/4" inner 6 master 48 Spatola acciaio inox Stainless steel turner V54AG72RIFL 8056444055597 cm 42* h 0,25* 7,8 16 1/2" x h 1/8" x 3" inner 6 master 48 Forchettone acciaio inox Stainless steel fork V54AG74RIFL 8056444082364 cm 42* h 0,25* 3,3 16 1/2" x h 1/8" x 1 1/4" inner 6 master 48
Stainless steel food tong V54AG67RIFL 8056444055498 cm 21,5* h 0,35* 2,5 8 1/2" x h 1/8" x 1" inner 6 master 48 360 361
Cucchiaio
nylon
Schiumarola nylon
silicone
Scolapasta pp
Pinza a servire acciaio inox
Via Capitello, 22
31030 Casier (TV) Italy
T. (+39) 0422 6721
F. (+39) 0422 670144
info@tognana.com
Follow us: TognanaProfessional
www.tognanaprofessional.com
Fotografie
Davide Barasa
Archivio Tognana
Stampa
Seventyseven
Senza autorizzazione, ogni riproduzione anche parziale e con qualsiasi mezzo è vietata”. L’azienda si riserva la facoltà di apportare tutte le modifiche necessarie al miglioramento estetico e qualitativo del prodotto, in qualsiasi momento e senza preavviso. La resa cromatica è indicativa e soggetta alle variazioni della stampa. Tutte le indicazioni relative alle dimensioni devono essere verificate con il listino.
The company reserves the right to make all the necessary changes for the purpose of constant improvement of quality, whit no obligation to give prior notice.
The colours as reproduced are not binding, since reproduction on paper can cause differences in shade with respect to the originals. All sizes must be checked with the price-list.

Rivenditore autorizzato - Authorized Seller www.tognanaprofessional.com b&n service ag neunbrunnenstrasse 50 8050 zürich 044 262 31 00 www.bn-service.ch info@bn-service.ch